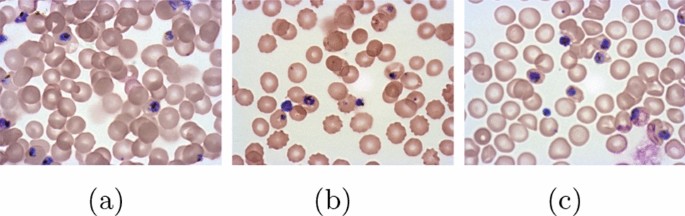
literature review on malaria prevention figure 4

- Download PDF
- CME & MOC
- Share X Facebook Email LinkedIn
- Permissions

Diagnosis, Treatment, and Prevention of Malaria in the US : A Review
- 1 Department of Medicine (Infectious Diseases), Albert Einstein College of Medicine, Bronx, New York
- 2 D. Samuel Gottesman Library, Albert Einstein College of Medicine, Bronx, New York
- Medical News & Perspectives Vaccine Development Is Charting a New Path in Malaria Control Bridget M. Kuehn, MSJ JAMA
- JAMA Patient Page Patient Information: Malaria Kristin Walter, MD, MS; Chandy C. John, MD, MS JAMA
- Global Health Updated Malaria Recommendations for Children and Pregnant People Howard D. Larkin JAMA
- Medical News in Brief First Ever Malaria Vaccine to Be Distributed in Africa Emily Harris JAMA
Importance Malaria is caused by protozoa parasites of the genus Plasmodium and is diagnosed in approximately 2000 people in the US each year who have returned from visiting regions with endemic malaria. The mortality rate from malaria is approximately 0.3% in the US and 0.26% worldwide.
Observations In the US, most malaria is diagnosed in people who traveled to an endemic region. More than 80% of people diagnosed with malaria in the US acquired the infection in Africa. Of the approximately 2000 people diagnosed with malaria in the US in 2017, an estimated 82.4% were adults and about 78.6% were Black or African American. Among US residents diagnosed with malaria, 71.7% had not taken malaria chemoprophylaxis during travel. In 2017 in the US, P falciparum was the species diagnosed in approximately 79% of patients, whereas P vivax was diagnosed in an estimated 11.2% of patients. In 2017 in the US, severe malaria, defined as vital organ involvement including shock, pulmonary edema, significant bleeding, seizures, impaired consciousness, and laboratory abnormalities such as kidney impairment, acidosis, anemia, or high parasitemia, occurred in approximately 14% of patients, and an estimated 0.3% of those receiving a diagnosis of malaria in the US died. P falciparum has developed resistance to chloroquine in most regions of the world, including Africa. First-line therapy for P falciparum malaria in the US is combination therapy that includes artemisinin. If P falciparum was acquired in a known chloroquine-sensitive region such as Haiti, chloroquine remains an alternative option. When artemisinin-based combination therapies are not available, atovaquone-proguanil or quinine plus clindamycin is used for chloroquine-resistant malaria. P vivax, P ovale, P malariae, and P knowlesi are typically chloroquine sensitive, and treatment with either artemisinin-based combination therapy or chloroquine for regions with chloroquine-susceptible infections for uncomplicated malaria is recommended. For severe malaria, intravenous artesunate is first-line therapy. Treatment of mild malaria due to a chloroquine-resistant parasite consists of a combination therapy that includes artemisinin or chloroquine for chloroquine-sensitive malaria. P vivax and P ovale require additional therapy with an 8-aminoquinoline to eradicate the liver stage. Several options exist for chemoprophylaxis and selection should be based on patient characteristics and preferences.
Conclusions and Relevance Approximately 2000 cases of malaria are diagnosed each year in the US, most commonly in travelers returning from visiting endemic areas. Prevention and treatment of malaria depend on the species and the drug sensitivity of parasites from the region of acquisition. Intravenous artesunate is first-line therapy for severe malaria.
Read More About
Daily JP , Minuti A , Khan N. Diagnosis, Treatment, and Prevention of Malaria in the US : A Review . JAMA. 2022;328(5):460–471. doi:10.1001/jama.2022.12366
Manage citations:
© 2024
Artificial Intelligence Resource Center
Cardiology in JAMA : Read the Latest
Browse and subscribe to JAMA Network podcasts!
Others Also Liked
Select your interests.
Customize your JAMA Network experience by selecting one or more topics from the list below.
- Academic Medicine
- Acid Base, Electrolytes, Fluids
- Allergy and Clinical Immunology
- American Indian or Alaska Natives
- Anesthesiology
- Anticoagulation
- Art and Images in Psychiatry
- Artificial Intelligence
- Assisted Reproduction
- Bleeding and Transfusion
- Caring for the Critically Ill Patient
- Challenges in Clinical Electrocardiography
- Climate and Health
- Climate Change
- Clinical Challenge
- Clinical Decision Support
- Clinical Implications of Basic Neuroscience
- Clinical Pharmacy and Pharmacology
- Complementary and Alternative Medicine
- Consensus Statements
- Coronavirus (COVID-19)
- Critical Care Medicine
- Cultural Competency
- Dental Medicine
- Dermatology
- Diabetes and Endocrinology
- Diagnostic Test Interpretation
- Drug Development
- Electronic Health Records
- Emergency Medicine
- End of Life, Hospice, Palliative Care
- Environmental Health
- Equity, Diversity, and Inclusion
- Facial Plastic Surgery
- Gastroenterology and Hepatology
- Genetics and Genomics
- Genomics and Precision Health
- Global Health
- Guide to Statistics and Methods
- Hair Disorders
- Health Care Delivery Models
- Health Care Economics, Insurance, Payment
- Health Care Quality
- Health Care Reform
- Health Care Safety
- Health Care Workforce
- Health Disparities
- Health Inequities
- Health Policy
- Health Systems Science
- History of Medicine
- Hypertension
- Images in Neurology
- Implementation Science
- Infectious Diseases
- Innovations in Health Care Delivery
- JAMA Infographic
- Law and Medicine
- Leading Change
- Less is More
- LGBTQIA Medicine
- Lifestyle Behaviors
- Medical Coding
- Medical Devices and Equipment
- Medical Education
- Medical Education and Training
- Medical Journals and Publishing
- Mobile Health and Telemedicine
- Narrative Medicine
- Neuroscience and Psychiatry
- Notable Notes
- Nutrition, Obesity, Exercise
- Obstetrics and Gynecology
- Occupational Health
- Ophthalmology
- Orthopedics
- Otolaryngology
- Pain Medicine
- Palliative Care
- Pathology and Laboratory Medicine
- Patient Care
- Patient Information
- Performance Improvement
- Performance Measures
- Perioperative Care and Consultation
- Pharmacoeconomics
- Pharmacoepidemiology
- Pharmacogenetics
- Pharmacy and Clinical Pharmacology
- Physical Medicine and Rehabilitation
- Physical Therapy
- Physician Leadership
- Population Health
- Primary Care
- Professional Well-being
- Professionalism
- Psychiatry and Behavioral Health
- Public Health
- Pulmonary Medicine
- Regulatory Agencies
- Reproductive Health
- Research, Methods, Statistics
- Resuscitation
- Rheumatology
- Risk Management
- Scientific Discovery and the Future of Medicine
- Shared Decision Making and Communication
- Sleep Medicine
- Sports Medicine
- Stem Cell Transplantation
- Substance Use and Addiction Medicine
- Surgical Innovation
- Surgical Pearls
- Teachable Moment
- Technology and Finance
- The Art of JAMA
- The Arts and Medicine
- The Rational Clinical Examination
- Tobacco and e-Cigarettes
- Translational Medicine
- Trauma and Injury
- Treatment Adherence
- Ultrasonography
- Users' Guide to the Medical Literature
- Vaccination
- Venous Thromboembolism
- Veterans Health
- Women's Health
- Workflow and Process
- Wound Care, Infection, Healing
- Register for email alerts with links to free full-text articles
- Access PDFs of free articles
- Manage your interests
- Save searches and receive search alerts
An official website of the United States government
The .gov means it’s official. Federal government websites often end in .gov or .mil. Before sharing sensitive information, make sure you’re on a federal government site.
The site is secure. The https:// ensures that you are connecting to the official website and that any information you provide is encrypted and transmitted securely.
- Publications
- Account settings
- My Bibliography
- Collections
- Citation manager
Save citation to file
Email citation, add to collections.
- Create a new collection
- Add to an existing collection
Add to My Bibliography
Your saved search, create a file for external citation management software, your rss feed.
- Search in PubMed
- Search in NLM Catalog
- Add to Search
Integrated malaria prevention in low- and middle-income countries: a systematic review
Affiliations.
- 1 Department of Disease Control and Environmental Health, School of Public Health, Makerere University College of Health Sciences, Kampala, Uganda. [email protected].
- 2 Department of Disease Control and Environmental Health, School of Public Health, Makerere University College of Health Sciences, Kampala, Uganda.
- 3 Department of Medicine, School of Medicine, Makerere University College of Health Sciences, Kampala, Uganda.
- PMID: 36879237
- PMCID: PMC9987134
- DOI: 10.1186/s12936-023-04500-x
Background: As many countries aim to eliminate malaria, use of comprehensive approaches targeting the mosquito vector and environment are needed. Integrated malaria prevention advocates the use of several malaria prevention measures holistically at households and in the community. The aim of this systematic review was to collate and summarize the impact of integrated malaria prevention in low- and middle-income countries on malaria burden.
Methods: Literature on integrated malaria prevention, defined as the use of two or more malaria prevention methods holistically, was searched from 1st January 2001 to 31st July 2021. The primary outcome variables were malaria incidence and prevalence, while the secondary outcome measures were human biting and entomological inoculation rates, and mosquito mortality.
Results: A total of 10,931 studies were identified by the search strategy. After screening, 57 articles were included in the review. Studies included cluster randomized controlled trials, longitudinal studies, programme evaluations, experimental hut/houses, and field trials. Various interventions were used, mainly combinations of two or three malaria prevention methods including insecticide-treated nets (ITNs), indoor residual spraying (IRS), topical repellents, insecticide sprays, microbial larvicides, and house improvements including screening, insecticide-treated wall hangings, and screening of eaves. The most common methods used in integrated malaria prevention were ITNs and IRS, followed by ITNs and topical repellents. There was reduced incidence and prevalence of malaria when multiple malaria prevention methods were used compared to single methods. Mosquito human biting and entomological inoculation rates were significantly reduced, and mosquito mortality increased in use of multiple methods compared to single interventions. However, a few studies showed mixed results or no benefits of using multiple methods to prevent malaria.
Conclusion: Use of multiple malaria prevention methods was effective in reducing malaria infection and mosquito density in comparison with single methods. Results from this systematic review can be used to inform future research, practice, policy and programming for malaria control in endemic countries.
Keywords: Integrated approach; Low- and middle-income countries; Malaria prevention; Multiple methods.
© 2023. The Author(s).
PubMed Disclaimer
Conflict of interest statement
The authors declare that they have no competing interests.
PRISMA flow diagram showing the…
PRISMA flow diagram showing the selection process
Similar articles
- Malaria prevention interventions beyond long-lasting insecticidal nets and indoor residual spraying in low- and middle-income countries: a scoping review. Nalinya S, Musoke D, Deane K. Nalinya S, et al. Malar J. 2022 Feb 2;21(1):31. doi: 10.1186/s12936-022-04052-6. Malar J. 2022. PMID: 35109848 Free PMC article. Review.
- Folic acid supplementation and malaria susceptibility and severity among people taking antifolate antimalarial drugs in endemic areas. Crider K, Williams J, Qi YP, Gutman J, Yeung L, Mai C, Finkelstain J, Mehta S, Pons-Duran C, Menéndez C, Moraleda C, Rogers L, Daniels K, Green P. Crider K, et al. Cochrane Database Syst Rev. 2022 Feb 1;2(2022):CD014217. doi: 10.1002/14651858.CD014217. Cochrane Database Syst Rev. 2022. PMID: 36321557 Free PMC article.
- Malaria prevention practices and associated environmental risk factors in a rural community in Wakiso district, Uganda. Musoke D, Miiro G, Ndejjo R, Karani G, Morris K, Kasasa S, Nakiyingi-Miiro J, Guwatudde D, Musoke MB. Musoke D, et al. PLoS One. 2018 Oct 9;13(10):e0205210. doi: 10.1371/journal.pone.0205210. eCollection 2018. PLoS One. 2018. PMID: 30300396 Free PMC article.
- Reduced exposure to malaria vectors following indoor residual spraying of pirimiphos-methyl in a high-burden district of rural Mozambique with high ownership of long-lasting insecticidal nets: entomological surveillance results from a cluster-randomized trial. Wagman JM, Varela K, Zulliger R, Saifodine A, Muthoni R, Magesa S, Chaccour C, Gogue C, Tynuv K, Seyoum A, Dengela D, Saúte F, Richardson JH, Fornadel C, Linton YM, Slutsker L, Candrinho B, Robertson M. Wagman JM, et al. Malar J. 2021 Jan 21;20(1):54. doi: 10.1186/s12936-021-03583-8. Malar J. 2021. PMID: 33478533 Free PMC article. Clinical Trial.
- The impact of pyrethroid resistance on the efficacy of insecticide-treated bed nets against African anopheline mosquitoes: systematic review and meta-analysis. Strode C, Donegan S, Garner P, Enayati AA, Hemingway J. Strode C, et al. PLoS Med. 2014 Mar 18;11(3):e1001619. doi: 10.1371/journal.pmed.1001619. eCollection 2014 Mar. PLoS Med. 2014. PMID: 24642791 Free PMC article. Review.
- Updates on traditional methods for combating malaria and emerging Wolbachia -based interventions. Mushtaq I, Sarwar MS, Chaudhry A, Shah SAH, Ahmad MM. Mushtaq I, et al. Front Cell Infect Microbiol. 2024 Apr 23;14:1330475. doi: 10.3389/fcimb.2024.1330475. eCollection 2024. Front Cell Infect Microbiol. 2024. PMID: 38716193 Free PMC article. Review.
- Facilitators and barriers to integrated malaria prevention in Wakiso district, Uganda: A photovoice study. Musoke D, Lubega GB, Niyongabo F, Nakalawa S, McMorrow S, Wanyenze RK, Kamya MR. Musoke D, et al. PLOS Glob Public Health. 2024 Apr 16;4(4):e0002469. doi: 10.1371/journal.pgph.0002469. eCollection 2024. PLOS Glob Public Health. 2024. PMID: 38626091 Free PMC article.
- WHO. World malaria report 2021. Geneva: World Health Organization; 2021. https://www.who.int/publications/i/item/9789240040496 . Accessed 28 Jun 2022.
- Nkumama IN, O’meara WP, Osier FHA. Changes in malaria epidemiology in Africa and new challenges for elimination. Trends Parasitol. 2017;33:128–40. doi: 10.1016/j.pt.2016.11.006. - DOI - PMC - PubMed
- Kogan F. Remote sensing for malaria: monitoring and predicting malaria from operational satellites. Cham: Springer Nature; 2020.
- Alonso S, Chaccour CJ, Elobolobo E, Nacima A, Candrinho B, Saifodine A, et al. The economic burden of malaria on households and the health system in a high transmission district of Mozambique. Malar J. 2019;18:360. doi: 10.1186/s12936-019-2995-4. - DOI - PMC - PubMed
- WHO. Malaria Programme Managers Meeting to Review Progress on Implementation of the Regional Action Framework for Malaria Control and Elimination in the Western Pacific 2016–2020, Manila, Philippines, 25–27 June 2018: meeting report. WHO Regional Office for the Western Pacific; 2018. https://apps.who.int/iris/bitstream/handle/10665/279733/RS-2018-GE-31-PH... . Accessed 28 Jun 2022.
Publication types
- Search in MeSH
Related information
Linkout - more resources, full text sources.
- BioMed Central
- Europe PubMed Central
- PubMed Central
- Genetic Alliance
- MedlinePlus Health Information
Research Materials
- NCI CPTC Antibody Characterization Program

- Citation Manager
NCBI Literature Resources
MeSH PMC Bookshelf Disclaimer
The PubMed wordmark and PubMed logo are registered trademarks of the U.S. Department of Health and Human Services (HHS). Unauthorized use of these marks is strictly prohibited.
- Research article
- Open access
- Published: 29 October 2018
Complex interactions between malaria and malnutrition: a systematic literature review
- D Das 1 , 2 ,
- R F Grais 4 ,
- E A Okiro 7 ,
- K Stepniewska 1 , 2 ,
- R Mansoor 1 , 2 ,
- S van der Kam 5 ,
- D J Terlouw 6 , 10 , 11 ,
- J Tarning 1 , 2 , 3 ,
- K I Barnes 8 , 9 &
- P J Guerin 1 , 2
BMC Medicine volume 16 , Article number: 186 ( 2018 ) Cite this article
9489 Accesses
48 Citations
177 Altmetric
Metrics details
Despite substantial improvement in the control of malaria and decreased prevalence of malnutrition over the past two decades, both conditions remain heavy burdens that cause hundreds of thousands of deaths in children in resource-poor countries every year. Better understanding of the complex interactions between malaria and malnutrition is crucial for optimally targeting interventions where both conditions co-exist. This systematic review aimed to assess the evidence of the interplay between malaria and malnutrition.
Database searches were conducted in PubMed, Global Health and Cochrane Libraries and articles published in English, French or Spanish between Jan 1980 and Feb 2018 were accessed and screened. The methodological quality of the included studies was assessed using the Newcastle-Ottawa Scale and the risk of bias across studies was assessed using the GRADE approach. The preferred reporting items for systematic reviews and meta-analyses (PRISMA) guideline were followed.
Of 2945 articles screened from databases, a total of 33 articles were identified looking at the association between malnutrition and risk of malaria and/or the impact of malnutrition in antimalarial treatment efficacy. Large methodological heterogeneity of studies precluded conducting meaningful aggregated data meta-analysis. Divergent results were reported on the effect of malnutrition on malaria risk. While no consistent association between risk of malaria and acute malnutrition was found, chronic malnutrition was relatively consistently associated with severity of malaria such as high-density parasitemia and anaemia. Furthermore, there is little information on the effect of malnutrition on therapeutic responses to artemisinin combination therapies (ACTs) and their pharmacokinetic properties in malnourished children in published literature.
Conclusions
The evidence on the effect of malnutrition on malaria risk remains inconclusive. Further analyses using individual patient data could provide an important opportunity to better understand the variability observed in publications by standardising both malaria and nutritional metrics. Our findings highlight the need to improve our understanding of the pharmacodynamics and pharmacokinetics of ACTs in malnourished children. Further clarification on malaria-malnutrition interactions would also serve as a basis for designing future trials and provide an opportunity to optimise antimalarial treatment for this large, vulnerable and neglected population.
Trial registration
PROSPERO CRD42017056934 .
Peer Review reports
Malaria and malnutrition in children (refers to all forms of undernutrition) are reported independently to be major causes of morbidity and mortality in low- and middle-income countries. About 3.2 billion people remained at risk of malaria with an estimated 216 million new cases (95% confidence interval 196–263 million) and 445,000 deaths worldwide in 2016; the majority of deaths occur in children under 5 years in sub-Saharan Africa [ 1 ]. Approximately 3.1 million deaths in children under five are attributed to malnutrition each year, representing 45% of all childhood deaths [ 2 ]. The interaction between malaria and childhood malnutrition has been studied for many years and complex interactions between these high-burden conditions are now increasingly recognised. Understanding the consequences of malnutrition on malaria and vice versa is crucial and may help guide the choice of public health interventions and research priorities where significant co-morbidity exists.
Malnutrition is a complex phenomenon due to its multifactorial aetiology and diverse clinical presentation. Acute malnutrition manifests with wasting (low weight for height) and chronic malnutrition as stunting (low height for age). Being underweight (low weight for age) can result from either chronic or acute malnutrition or both. Assessment of malnourishment can be conducted using anthropometric indicators which compare child’s weight and height to the standardised age- and sex-specific growth reference derived from the international reference population of children between 6 and 59 months of age (World Health Organization (WHO) Child Growth Standards 2006) [ 3 ]. The anthropometric indicators are expressed as a number of standard deviations (SDs) below or above the reference mean or median value, Z-score. Cutoffs of − 3 are used to indicate severe malnutrition and values between − 2 and − 3 are considered to be moderate malnutrition. Weight-for-height Z-score (WHZ) is the indicator used to classify a child with wasting. Mid-Upper Arm Circumference (MUAC) is another frequently used indicator for wasting. Severe acute malnutrition (SAM) is defined as MUAC < 115 mm and/or WHZ < − 3 and/or bilateral pitting oedema. Stunting is defined by the measure of height-for-age Z-score (HAZ) and a child is considered as being underweight based on low weight-for-age Z-score (WAZ). These definitions do not take micronutrient malnutrition into account, which can occur even if the person is getting enough energy and they are not thin or short.
The exact relationship between childhood malnutrition and malaria remains complex, controversial, and poorly understood. One of the key questions is, to what extent the burden of malaria is attributable to wasting and stunting? In regard to the impact of malaria on malnutrition, some evidence suggests malaria has adverse effects on nutritional status of young children [ 4 , 5 , 6 , 7 , 8 , 9 ]. On the other hand, whether and how malnutrition influences malaria morbidity and mortality is debated. Some studies have reported that malnutrition is associated with a higher risk of malaria [ 10 , 11 , 12 , 13 ], others have suggested a protective effect [ 14 , 15 , 16 , 17 ], or no differential risk [ 18 , 19 ]. Similarly, there is very limited evidence on the relationship between nutritional status and antimalarial drug efficacy. Clinical efficacy of the current first-line malaria treatment, the artemisinin combination therapies (ACTs), in malnourished children has been rarely explored [ 20 , 21 , 22 ]. Understanding the complex relationship of the immune response of individuals infected with malaria and suffering of malnutrition is crucial to guide specific antimalarial therapeutic approaches in this vulnerable sub-population. There are key knowledge gaps in defining the complex relationship between malnutrition and malaria, which need to be identified and addressed. We aimed to conduct a systematic review of the current understanding of interactions between acute or chronic malnutrition and the risk of developing malarial infection. A further objective was to explore published literature on the impact of malnutrition on the efficacy of antimalarial treatment.
We conducted a systematic literature review of manuscripts published between Jan 1, 1980, and Feb 19, 2018. PubMed, Global Health and Cochrane Libraries were searched using key terms (Additional file 1 ), and articles published in English, French or Spanish were accessed. Two reviewers identified relevant articles of interest, as per criteria listed below, by screening titles and abstracts of publications retrieved. The preferred reporting items for systematic reviews and meta-analyses (PRISMA) guideline [ 23 ] was followed. The PRISMA checklist is provided as Additional file 2 and the review is registered in international prospective register of systematic reviews (PROSPERO Registration No. CRD42017056934).
Eligibility screening
For the selected articles, full text was obtained and assessed for relevance to any of the following topics of interest: (1) association between malnutrition and risk of malaria and (2) malnutrition and antimalarial treatment efficacy. We excluded studies primarily focused on non-malarial conditions such as TB, HIV, neglected tropical diseases, pneumonia or diarrhoeal diseases; non-clinical studies (systematic reviews, opinion pieces, editorials, modelling studies, economic evaluations, guidelines, protocols, book chapters) and in vitro, animal, plant or molecular studies; studies on malaria in pregnancy and placental malaria; demographic and health surveys, mortality surveys, qualitative studies; case reports or series; vaccine studies; and studies primarily focused only on malaria or malnutrition or micronutrient deficiencies or anaemia. For this review, observational and interventional studies in non-pregnant populations with malnutrition assessed by anthropometric measurements as exposure and risk of malaria infection (whether asymptomatic parasitemia or uncomplicated malaria) as outcome were included.
Data extraction
From each of the included studies in this review, the following variables were extracted: authors, year of publication, country, study design, age (range or median/mean), sex (ratio), sample size, growth standards, malaria transmission intensity, definition of malaria and the reported risk estimates. The methodological quality of the included studies was assessed using the Newcastle-Ottawa Scale (NOS) [ 24 ] and the risk of bias across studies was assessed using the GRADE approach [ 25 ]. The risk of bias assessment within and across studies is presented as Additional file 3 .
Aggregated data meta-analysis was not possible due to the heterogeneity of studies in respect to study design, definition of malnutrition, definition of malaria, study population, e.g. age group target, analysis conducted and effect measures presented. Only summaries of study findings are presented in this review. Association between malnutrition and risk of malaria was deemed to be statistically significant if either the P value was < 0.05 and/or the 95% confidence intervals (CIs) did not include 1. The risk of malaria was classified as “increased” or “decreased” according to the interpretation of the effect estimates provided (i.e. incidence risk ratio (IRR), odds ratio (OR), risk ratio (RR) or hazard ratio (HR)) if statistical significance was achieved as described above.
The literature search identified 2945 articles. A total of 32 articles identified through the search and 1 article obtained through citation tracking were included, describing cross-sectional surveys ( n = 16), longitudinal studies ( n = 12), interventional studies ( n = 3), case-control study ( n = 1) and individual patient data meta-analysis ( n = 1) (Fig. 1 ). Details of the 33 studies included in this review are given in Table 1 , while the study characteristics are summarised in Additional file 4 .

Flow diagram of study selection
Association between malnutrition and risk of malaria
In total, 29 studies assessed the association between malnutrition and risk of malaria (Tables 2 , 3 and 4 ).
Risk of malaria infection in children with stunting (chronic malnutrition)
Twenty-three studies explored the relationship between stunting and risk of malaria infection (Table 2 ). Overall results were conflicting, with 15 studies showing that stunting was associated with an increased malaria risk, 11 studies showing no association and 2 studies showing a protective effect of stunting (Table 2 ).
A prospective cohort study of 487 children under 5 years of age in rural Gambia by Deen et al. reported that being stunted increased the risk of malaria infection significantly (RR = 1.35 (95% CI = 1.08–1.69)) [ 10 ]. The authors hypothesised that the observed association between malnutrition and malaria infection might be influenced by confounding factors such as HIV co-infection or socio-economic factors. Similarly, in a cross-sectional survey in children < 3 years in Kenya, Friedman and colleagues found an increased malaria risk in stunted children, showing a trend towards an increased risk of clinical malaria (OR = 1.77, P = 0.06), and significantly increased risk of any malaria parasitemia (OR = 1.98, P < 0.0001), high-density parasitemia (any species, > 1500–7000/μL; OR = 1.84, P < 0.0001) and severe anaemia (OR = 2.65, P < 0.0001) [ 26 ]. In contrast, a longitudinal study from the Gambia by Snow et al. in children aged 1–4 years reported only a minor (non-significant) impact of stunting on clinical and asymptomatic malaria episodes [ 17 ]. Two longitudinal malaria surveillance reports, one in Senegal with 874 children aged 12 months–5 years and the other in Burkina Faso with 685 children aged 6–30 months did not show any association between a low HAZ and subsequent malaria attacks [ 18 , 27 ]. Similarly, Verhoef et al. in Kenya did not observe an association between being stunted and the risk of malaria infection; however, they showed that stunting might determine the severity of malaria-associated anaemia in African children [ 13 ]. Verret et al. found that in chronically malnourished children in a high-transmission setting in Uganda, children with mild (HAZ [≥ − 2 and < − 1]) to moderate (HAZ < − 2) stunting not given trimethoprim-sulfamethoxazole prophylaxis were at higher risk for recurrent parasitemia [ 22 ]. Contrary to this, in a cohort survey of 790 children under 5 years in the Kivu province, Democratic Republic of Congo (DRC), Mitangala and colleagues found that being severely stunted was protective of subsequent malaria parasitemia [ 21 ]. This finding was supported by Genton et al. in a prospective cohort of 136 children aged 10–120 months in Papua New Guinea showing that lower HAZ had a protective effect against falciparum malaria [ 14 ].
Risk of malaria infection in children with wasting
Eighteen studies explored the relationship between wasting and risk of malaria infection (Table 3 ). Overall, results were again conflicting, with three studies showing that wasting was associated with an increased malaria risk, two studies showing a protective effect and most studies showing no association (Table 3 ).
Takakura et al. [ 29 ], Ehrhardt et al. [ 11 ] and Shikur et al. [ 28 ] found an increased risk of P. falciparum malaria in children with wasting. In a case-control study involving 428 under-five children in Ethiopia, Shikur and colleagues found that severely wasted children were three times more likely to have malaria episode than non-wasted children (adjusted OR = 2.90 (95% CI = 1.14–7.61) [ 28 ]. In 2006, Ehrhardt et al. reported a survey involving 2905 children in Ghana aged 6–108 months in which wasting was significantly associated with a higher risk of clinical malaria (OR = 1.86, 95% CI = 1.14–3.02) [ 11 ]. Takakura et al. in a cross-sectional study of 309 children and adolescents (aged 2 to 18 years) in the Lao PDR showed that P. falciparum infection was associated with wasting [ 29 ]. However, Fillol and colleagues reported a significant protective association between being wasted (WHZ < − 2) at the onset of the rainy season and the risk of a clinical malaria episode (OR = 0.33, 95% CI = 0.13–0.81) in 874 preschool children (between 12 months and 5 years of age) in Senegal [ 27 ]. Similarly, in a cross-sectional survey of 1862 very young children (from 0 to 36 months age) in western Kenya, Friedman et al. showed that wasting decreased the risk of concurrent malaria (OR = 0.75, P = 0.18) and high-density parasitemia (OR = 0.96, P = 0.88), although increased the risk of severe malarial anaemia (OR = 2.0, P = 0.04) [ 26 ]. In contrast, two other longitudinal studies conducted in the Gambia [ 17 ] and in Burkina Faso [ 18 ] and a few cross-sectional surveys from Equatorial Guinea [ 30 ], Eastern Kenya [ 13 ] and Ghana [ 11 ] reported no association between being wasted and the risk of malaria infections.
Risk of malaria infection in underweight children
Nineteen studies explored the relationship between being underweight-for-age and risk of malaria infection (Table 4 ). Overall, results were again conflicting, with five studies showing that underweight children carried a higher malaria risk, and the remaining studies showing no association (Table 4 ).
In 2006, Ehrhardt et al. using cross-sectional surveys in Ghana found that being underweight was significantly associated with a higher risk of having fever of any cause (OR = 1.59, 95% CI = 1.13–2.23), clinical malaria (OR = 1.67, 95% CI = 1.10–2.50) and anaemia (OR = 1.68, 95% CI = 1.38–2.04) [ 11 ]. This was confirmed by Sumbele et al. [ 57 ] who found that 21.6% of underweight children but only 8.2% of adequately nourished children developed clinical malaria ( P = 0.007) in Cameroon. In a series of cross-sectional surveys conducted in the South Pacific island of Vanuatu in 1997, Williams et al. found a strong association between the incidence of P. vivax malaria and subsequently becoming underweight (IRR = 2.6, 95% CI = 1.5–4.4) but no significant effect of P. falciparum malaria (IRR = 1.1, 95% CI = 0.57–2.1) [ 31 ]. On the other hand, Tonglet et al. reported a non-significant protective association between being underweight and the risk of clinical malaria in children between 9 months and 2 years of age in the DRC (OR = 0.68, 95% CI = 0.24–1.11) [ 32 ].
Malnutrition and anti-malarial drug efficacy
Limited data exist on the effect of malnutrition on response to antimalarial drugs, in particular ACTs. Only five studies were identified in our literature search, and results were again contradictory.
In 2008, Obua et al. explored the impact of nutritional status on the dose, drug concentrations and treatment outcome with co-packaged chloroquine plus sulfadoxine-pyrimethamine in 83 children (6 months–5 years) with uncomplicated falciparum malaria [ 33 ]. The authors found that stunting (height-for-age Z-score < − 2) was associated with higher bodyweight-adjusted (mg/kg) doses of chloroquine and sulfadoxine-pyrimethamine, higher sulfadoxine concentrations on day 1 and chloroquine concentrations on day 3, and better cure rates ( P = 0.046).
In a longitudinal study of 292 infants (aged 4–12 months) in Uganda, a high malaria transmission intensity setting, ACTs (artemether-lumefantrine and dihydroartemisinin-piperaquine) were generally efficacious with a good early parasitological response (99% of study participants cleared parasites by day 3) for treatment of P. falciparum malaria, including in 43% chronically malnourished children [ 22 ]. However, in this study, stunted children (height-for-age Z-score < − 2) in the dihydroartemisinin-piperaquine arm who were not taking trimethoprim-sulfamethoxazole prophylaxis (given to all HIV-infected and exposed infants) were at higher risk for recurrent parasitaemia (HR 3.18 (95% CI 1.18–8.56); P = 0.022). Another study carried out in the DRC in 445 children, comparing the efficacy of standard doses of artesunate-amodiaquine between children with and without severe acute malnutrition (SAM), observed no evidence of reduced efficacy in children with SAM, which had an adequate clinical and parasitological cure rate, ACPR, of 91.4% [ 34 ]. A recent multi-centre (Mali and Niger), open-label trial compared the efficacy and pharmacokinetics of artemether-lumefantrine in 399 children with or without SAM. The results of this study showed adequate therapeutic efficacy in both SAM and non-SAM groups (day 42 ACPR 100% vs. 98.3% respectively) with no early treatment failures and no difference in parasite clearance reported. However, a higher risk of reinfection in children older than 21 months suffering from SAM was evident (AHR 2.10 (1.04–4.22); P = 0.038) [ 35 ]. Similarly in a large pooled analysis of individual pharmacokinetic-pharmacodynamic (PK-PD) data from 2787 patients treated with artemether-lumefantrine for uncomplicated Pf malaria, the WorldWide Antimalarial Resistance Network (WWARN) demonstrated that among children 1–4 years of age in high-transmission areas, the risk of reinfection increased with a decrease in WAZ with a HR of 1.63 (95% CI 1.09 to 2.44) for a child with WAZ of − 3 compared to an adequately nourished child (WAZ = 0) [ 36 ].
Information on the pharmacokinetic properties of ACTs in malnourished children is critically lacking in the published literature. Our search retrieved a study published in 2016 which assessed the efficacy of AL in relation to drug exposure in children with SAM vs. non-SAM in Mali and Niger [ 35 ]. This study measured lumefantrine concentration and showed that despite the administration of 92 g fat with dosing of SAM children (compared to 15 mL milk in non-SAM children), day 7 lumefantrine concentrations were lower in children with SAM compared to non-SAM (median 251 vs. 365 ng/mL, P = 0.049). In the WWARN pooled analysis of individual PK-PD data from patients treated with artemether-lumefantrine for uncomplicated Pf malaria, underweight-for-age young children (< 3 years) had 23% (95% CI − 1 to 41%) lower day 7 lumefantrine concentrations than adequately nourished children of same age [ 36 ].
The evidence on the effect of malnutrition on malaria risk remains controversial and in many instances contradictory. The current review highlights some key limitations in the way the interaction between malaria and malnutrition has been assessed and reported. First, differences in methodology, study populations, the variability in measures used to define malnutrition (e.g. different growth references, different cut off thresholds), and the heterogeneous malaria transmission intensities with different levels of host immunity within the different studies make the comparison challenging. Second, there is a paucity of information on the effect of malnutrition on therapeutic responses to ACTs and their pharmacokinetic properties in malnourished children in published literature. Generally, vulnerable populations with common co-morbidities such as malnutrition, obesity, HIV or tuberculosis co-infection are excluded from or under-represented in antimalarial drug efficacy trials [ 37 ]. Although weight is documented, height is rarely recorded in ACT efficacy trials (< 20% of 250 trials currently included in the WWARN repository, personal communication Kasia Stepniewska), restricting the possibilities for secondary analyses. Another useful metric, mid-upper arm circumference (MUAC) is also rarely documented in malaria clinical trials despite being relatively easy to measure and low MUAC shown to be associated with increased malaria risk [ 38 ] and decreased lumefantrine bioavailability [ 39 ]. Several confounding factors and effect modifiers have been suggested such as age, co-morbidities (e.g. HIV, tuberculosis co-infection and drug interactions), immunity, socio-economic status, or refeeding practices. However, these confounding factors are poorly documented and controlled for in most of the reported studies in this review.
This review has several limitations. First, one third of the studies included in this review recruited individuals of all ages, and disaggregating observations by the age of individuals (below and above 5 years) was not possible. Methodologically, the temporal relationship between malnutrition and risk of malaria (and progression from infection to symptomatic malaria) could not be assessed because of cross-sectional study design (50% included studies). It is also limited by the extent to which important confounders (such as differential micronutrient deficiencies, ecological and genetic factors) are measured and reported in the included articles. Finally, the heterogeneity of the selected studies (presented as Additional file 5 ) including variations in measurement of nutritional status, definition of malaria, and statistical approaches adopted in deriving the risk estimates restricted plausible aggregated data meta-analysis in this review.
Interestingly, while no consistent association between risk of malaria and acute malnutrition was found, chronic malnutrition was relatively consistently associated with severity of malaria such as high-density parasitemia and anaemia [ 10 , 26 , 27 ] . The mechanism behind the higher risk of recurrent parasitemia could be explained partially by the impact of chronic malnutrition on the immune system and/or lower antimalarial bioavailability. Likewise, the apparent protection of wasted children from clinical malaria might be caused by their being administered a higher mg/kg antimalarial dose and/or a modulation of their immune response and thus an absence of symptoms, e.g. fever usually associated with malaria as opposed to an absence of malaria infection. Friedman et al. showed high-density parasitemia as a predictor for chronic malnutrition [ 26 ]. Nevertheless, the role of malaria in the aetiology of malnutrition remains unclear. The effect of malaria on nutritional status appeared to be greatest during the first 2 years of life and age acted as an effect modifier in the association between malaria episodes and malnutrition [ 6 ].
ACTs are now recommended for the treatment of uncomplicated falciparum malaria in almost all malaria-endemic countries and the number of children exposed to these antimalarial agents is increasing. A priority area is to identify gaps in our current knowledge in regard to the pharmacokinetic properties of artemisinins and partner drugs in malnourished paediatric populations to optimise dosing in order to ensure efficacy, safety and avoid the selection of parasite resistance [ 40 ]. Exposing pathogens to sub-therapeutic levels of active ingredients is a major driver of resistance. Protein-energy malnutrition, defined as insufficient calorie and protein intake, may have potential physiological effects on the absorption, distribution and metabolism of ACTs and subsequently affect the efficacy and safety of ACTs. Severe acute malnutrition can cause pathophysiological changes, including increasing total body water, leading to greater volume of distribution of drugs, which in turn may cause sub-optimal drug exposure when ACTs are given at standard doses [ 35 , 41 ]. This could be further compounded by malnutrition in paediatric patients leading to dosing inaccuracies of ACTs when dose is calculated by age (over-dosing for actual body weight) or weight (under-dosing for age). Malnutrition can also be associated with intestinal malabsorption and villous atrophy of the jejunal mucosa which may cause impaired drug absorption [ 42 ]. The reduced absorption of lipids and fats has the potential to specifically affect the lipid-soluble ACTs [ 43 ]. The hepatic metabolism of the ACTs may be compromised in malnourished children. For instance, in case of quinine, hepatic metabolism is decreased in protein deficiency and increased in global malnutrition [ 44 ]. Thus, hepatic metabolised drugs should be carefully monitored in children with malnutrition. A recent individual patient data (IPD) meta-analysis conducted by the WWARN to investigate the effect of dosing strategy on efficacy of artemether-lumefantrine showed that the risk of treatment failure was greatest in malnourished children aged 1–3 years in Africa (PCR-adjusted efficacy 94.3%, 95% CI 92.3–96.3) [ 45 ]. Another large WWARN IPD meta-analysis of individual PK-PD data from patients treated with artemether-lumefantrine (AL) for uncomplicated malaria, showed day 7 concentrations adjusted for mg/kg dose were lowest in very young children (< 3 years), among whom underweight-for-age children had 23% (95% CI − 1 to 41%) lower concentrations than adequately nourished children of the same age and 53% (95% CI 37 to 65%) lower concentrations than adults [ 36 ]. This raises the question of whether an adapted dosing regimen is needed in malnourished young children. The PK-PD evaluation of artemisinins and longer-acting partner antimalarials for the treatment of malaria in paediatric populations and the effect of malnutrition on the pharmacological activity of ACTs is a priority area to identify and address key knowledge gaps.
A summary of the remaining knowledge gaps is presented to serve as the basis for prioritising future research strategies and highlights the need for standardising measures and reporting of nutritional status. Further analyses using individual patient data could provide an important opportunity to better understand the variability observed in publications by standardising both malaria nutritional metrics. In an era of emergence and spread of antimalarial drug resistance, it is imperative to improve our understanding of the pharmacodynamics and pharmacokinetics of ACTs in malnourished children to optimise antimalarial treatment of this very large vulnerable population. Pooled analysis, gap analysis and carefully designed prospective, randomised controlled clinical trials can provide strong evidence on the outstanding questions raised in this review related to malaria-malnutrition interactions.
Abbreviations
Artemisinin combination therapy
Adjusted odds ratio
Confidence interval
Democratic Republic of Congo
Grading of Recommendations Assessment, Development, and Evaluation
Height-for-age Z-score
Hazard ratio
Individual patient data
Incidence risk ratio
Mid-Upper Arm Circumference
Newcastle-Ottawa Scale
Plasmodium falciparum
Pharmacokinetic-pharmacodynamic
Severe acute malnutrition
Standard deviation
Weight-for-age Z-score
World Health Organization
Weight-for-height Z-score
WorldWide Antimalarial Resistance Network
World Malaria Report 2016. Geneva: World Health Organization; 2016. http://www.who.int/malaria/publications/world-malaria-report-2016/report/en/ .
Black RE, Victora CG, Walker SP, Bhutta ZA, Christian P, de Onis M, Ezzati M, Grantham-McGregor S, Katz J, Martorell R, et al. Maternal and child undernutrition and overweight in low-income and middle-income countries. Lancet. 2013;382(9890):427–51.
Article Google Scholar
WHOMGRS. WHO child growth standards based on length/height, weight and age. Acta Paediatr Suppl. 2006;450:76–85.
Google Scholar
Bradley-Moore AM, Greenwood BM, Bradley AK, Kirkwood BR, Gilles HM. Malaria chemoprophylaxis with chloroquine in young Nigerian children. III Its effect on nutrition. Ann Trop Med Parasitol. 1985;79(6):575–84.
Article CAS Google Scholar
Colbourne MJ. The effect of malaria suppression in a group of Accra school children. Trans R Soc Trop Med Hyg. 1955;49(4):556–69.
Nyakeriga AM, Troye-Blomberg M, Chemtai AK, Marsh K, Williams TN. Malaria and nutritional status in children living on the coast of Kenya. Am J Clin Nutr. 2004;80(6):1604–10.
Snow RW, Molyneux CS, Njeru EK, Omumbo J, Nevill CG, Muniu E, Marsh K. The effects of malaria control on nutritional status in infancy. Acta Trop. 1997;65(1):1–10.
ter Kuile FO, Terlouw DJ, Kariuki SK, Phillips-Howard PA, Mirel LB, Hawley WA, Friedman JF, Shi YP, Kolczak MS, Lal AA, et al. Impact of permethrin-treated bed nets on malaria, anemia, and growth in infants in an area of intense perennial malaria transmission in western Kenya. Am J Trop Med Hyg. 2003;68(4 Suppl):68–77.
ter Kuile FO, Terlouw DJ, Phillips-Howard PA, Hawley WA, Friedman JF, Kolczak MS, Kariuki SK, Shi YP, Kwena AM, Vulule JM, et al. Impact of permethrin-treated bed nets on malaria and all-cause morbidity in young children in an area of intense perennial malaria transmission in western Kenya: cross-sectional survey. Am J Trop Med Hyg. 2003;68(4 Suppl):100–7.
Deen JL, Walraven GEL, von Seidlein L. Increased risk for malaria in chronically malnourished children under 5 years of age in rural Gambia. J Trop Pediatr. 2002;48(2):78–83.
Ehrhardt S, Burchard GD, Mantel C, Cramer JP, Kaiser S, Kubo M, Otchwemah RN, Bienzle U, Mockenhaupt FP. Malaria, anemia, and malnutrition in african children--defining intervention priorities. J Infect Dis. 2006;194(1):108–14.
Man WD, Weber M, Palmer A, Schneider G, Wadda R, Jaffar S, Mulholland EK, Greenwood BM. Nutritional status of children admitted to hospital with different diseases and its relationship to outcome in the Gambia, West Africa. Tropical Med Int Health. 1998;3(8):678–86.
Verhoef H, West CE, Veenemans J, Beguin Y, Kok FJ. Stunting may determine the severity of malaria-associated anemia in African children. Pediatrics. 2002;110(4):e48.
Genton B, Al-Yaman F, Ginny M, Taraika J, Alpers MP. Relation of anthropometry to malaria morbidity and immunity in Papua new Guinean children. Am J Clin Nutr. 1998;68(3):734–41.
Hendrickse RG, Hasan AH, Olumide LO, Akinkunmi A. Malaria in early childhood. An investigation of five hundred seriously ill children in whom a “clinical” diagnosis of malaria was made on admission to the children's emergency room at University College Hospital, Ibadan. Ann Trop Med Parasitol. 1971;65(1):1–20.
Murray MJ, Murray AB, Murray NJ, Murray MB. Diet and cerebral malaria: the effect of famine and refeeding. Am J Clin Nutr. 1978;31(1):57–61.
Snow RW, Byass P, Shenton FC, Greenwood BM. The relationship between anthropometric measurements and measurements of iron status and susceptibility to malaria in Gambian children. Trans R Soc Trop Med Hyg. 1991;85(5):584–9.
Muller O, Garenne M, Kouyate B, Becher H. The association between protein-energy malnutrition, malaria morbidity and all-cause mortality in west African children. Tropical Med Int Health. 2003;8(6):507–11.
Tshikuka JG, Gray-Donald K, Scott M, Olela KN. Relationship of childhood protein-energy malnutrition and parasite infections in an urban African setting. Tropical Med Int Health. 1997;2(4):374–82.
Hess FI, Nukuro E, Judson L, Rodgers J, Nothdurft HD, Rieckmann KH. Anti-malarial drug resistance, malnutrition and socio-economic status. Tropical Med Int Health. 1997;2(8):721–8.
Mitangala PN, D’Alessandro U, Donnen P, Hennart P, Porignon D, Bisimwa Balaluka G, Zozo Nyarukweba D, Cobohwa Mbiribindi N, Dramaix Wilmet M. Malaria infection and nutritional status: results from a cohort survey of children from 6-59 months old in the Kivu province, Democratic Republic of the Congo. Revue d’epidemiologie et de sante publique. 2013;61(2):111–20.
Verret WJ, Arinaitwe E, Wanzira H, Bigira V, Kakuru A, Kamya M, Tappero JW, Sandison T, Dorsey G. Effect of nutritional status on response to treatment with artemisinin-based combination therapy in young Ugandan children with malaria. Antimicrob Agents Chemother. 2011;55(6):2629–35.
Moher D, Liberati A, Tetzlaff J, Altman DG, Group P. Preferred reporting items for systematic reviews and meta-analyses: the PRISMA statement. BMJ (Clinical research ed). 2009;339:b2535.
Well GASB, O’Connell D, Peterson J. The Newcastle-Ottawa scale (NOS) for assessing the quality of non-randomised studies in meta-analyses. Ottawa: Ottawa Hospital Research Institute; 2011.
Guyatt GHOA, Vist G, Kunz R, Brozek J. GRADE guidelines: 4. Rating the quality of evidence--study limitations (risk of bias). J Clin Epidemiol. 2011;64(4):407–15.
Friedman JF, Kwena AM, Mirel LB, Kariuki SK, Terlouw DJ, Phillips-Howard PA, Hawley WA, Nahlen BL, Shi YP, ter Kuile FO. Malaria and nutritional status among pre-school children: results from cross-sectional surveys in western Kenya. Am J Trop Med Hyg. 2005;73(4):698–704.
Fillol F, Cournil A, Boulanger D, Cisse B, Sokhna C, Targett G, Trape JF, Simondon F, Greenwood B, Simondon KB. Influence of wasting and stunting at the onset of the rainy season on subsequent malaria morbidity among rural preschool children in Senegal. Am J Trop Med Hyg. 2009;80(2):202–8.
Shikur B, Deressa W, Lindtjørn B. Association between malaria and malnutrition among children aged under-five years in Adami Tulu District, south-Central Ethiopia: a case-control study. BMC Public Health. 2016;16(1):174.
Takakura M, Uza M, Sasaki Y, Nagahama N, Phommpida S, Bounyadeth S, Kobayashi J, Toma T, Miyagi I. The relationship between anthropometric indicators of nutritional status and malaria infection among youths in Khammouane Province, Lao PDR. Southeast Asian J Trop Med Public Health. 2001;32(2):262–7.
CAS PubMed Google Scholar
Custodio E, Descalzo MA, Villamor E, Molina L, Sanchez I, Lwanga M, Bernis C, Benito A, Roche J. Nutritional and socio-economic factors associated with Plasmodium falciparum infection in children from Equatorial Guinea: results from a nationally representative survey. Malar J. 2009;8:225.
Williams TN, Maitland K, Phelps L, Bennett S, Peto TE, Viji J, Timothy R, Clegg JB, Weatherall DJ, Bowden DK. Plasmodium vivax: a cause of malnutrition in young children. QJM. 1997;90(12):751–7.
Tonglet R, Mahangaiko Lembo E, Zihindula PM, Wodon A, Dramaix M, Hennart P. How useful are anthropometric, clinical and dietary measurements of nutritional status as predictors of morbidity of young children in Central Africa? Trop Med Int Health. 1999;4(2):120–30.
Obua C, MNJWO-OLLGUH, Petzold MG. Impact of nutritional status on fixed-dose chloroquine and sulfadoxine/pyrimethamine combination treatment of malaria in Ugandan children. Int J Trop Med. 2008;3(3):53–9.
Mitanlgala NP, D’Alessandro U, Hennart P, Donnen P, Porignon D. Efficacy of Artesunate plus Amodiaquine for treatment of uncomplicated clinical falciparum malaria in severely malnourished children aged 6–59 months, Democratic Republic of Congo. J Clin Exp Pathol. 2012;S3:005.
Denoeud-Ndam L, Dicko A, Baudin E, Guindo O, Grandesso F, Diawara H, Sissoko S, Sanogo K, Traoré S, Keita S, et al. Efficacy of artemether-lumefantrine in relation to drug exposure in children with and without severe acute malnutrition: an open comparative intervention study in Mali and Niger. BMC Med. 2016;14(1):167.
WorldWide Antimalarial Resistance Network Lumefantrine PKPDSG. Artemether-lumefantrine treatment of uncomplicated Plasmodium falciparum malaria: a systematic review and meta-analysis of day 7 lumefantrine concentrations and therapeutic response using individual patient data. BMC Med. 2015;13:227.
Barnes KI, Lindegardh N, Ogundahunsi O, Olliaro P, Plowe CV, Randrianarivelojosia M, Gbotosho GO, Watkins WM, Sibley CH, White NJ. World antimalarial resistance network (WARN) IV: clinical pharmacology. Malar J. 2007;6:122.
Gahutu J-B, Steininger C, Shyirambere C, Zeile I, Cwinya-Ay N, Danquah I, Larsen CH, Eggelte TA, Uwimana A, Karema C, et al. Prevalence and risk factors of malaria among children in southern highland Rwanda. Malar J. 2011;10(1):134.
Chotsiri P, Denoeud-Ndam L, Charunwatthana P, Dicko A: Population pharmacokinetic and time-to-event modelling of the antimalarial drug lumefantrine in young children with severe acute malnutrition. In: Available from: https://www.page-meeting.org/pdf_assets/6574-20170608_PAGE_poster_LF_SAM_children_print.pdf .
Mercer AE, Sarr Sallah M. The pharmacokinetic evaluation of artemisinin drugs for the treatment of malaria in paediatric populations. Expert Opin Drug Metab Toxicol. 2011;7(4):427–39.
Oshikoya KA, Sammons HM, Choonara I. A systematic review of pharmacokinetics studies in children with protein-energy malnutrition. Eur J Clin Pharmacol. 2010;66(10):1025–35.
Oshikoya KA, Senbanjo IO. Pathophysiological changes that affect drug disposition in protein-energy malnourished children. Nutr Metab. 2009;6:50.
Murphy JL, Badaloo AV, Chambers B, Forrester TE, Wootton SA, Jackson AA. Maldigestion and malabsorption of dietary lipid during severe childhood malnutrition. Arch Dis Child. 2002;87(6):522–5.
Treluyer JM, Roux A, Mugnier C, Flouvat B, Lagardere B. Metabolism of quinine in children with global malnutrition. Pediatr Res. 1996;40(4):558–63.
Worldwide Antimalarial Resistance Network ALDISG. The effect of dose on the antimalarial efficacy of artemether-lumefantrine: a systematic review and pooled analysis of individual patient data. Lancet Infect Dis. 2015;15(6):692–702.
Akiyama T, Pongvongsa T, Phrommala S, Taniguchi T, Inamine Y, Takeuchi R, Watanabe T, Nishimoto F, Moji K, Kano S, et al. Asymptomatic malaria, growth status, and anaemia among children in Lao People's Democratic Republic: a cross-sectional study. Malar J. 2016;15(1):499.
Alexandre MAA, Benzecry SG, Siqueira AM, Vitor-Silva S, Melo GC, Monteiro WM, Leite HP, Lacerda MVG, Alecrim MGC. The association between nutritional status and malaria in children from a rural community in the Amazonian region: a longitudinal study. PLoS Negl Trop Dis. 2015;9(4):e0003743.
Arinaitwe E, Gasasira A, Verret W, Homsy J, Wanzira H, Kakuru A, Sandison TG, Young S, Tappero JW, Kamya MR, et al. The association between malnutrition and the incidence of malaria among young HIV-infected and -uninfected Ugandan children: a prospective study. Malar J. 2012;11(1):90.
Ayana TG, Solomon T, Atsbeha H, Shumbulo EL, Amente WD, Lindtjorn B. Malnutrition and malaria infection in children 6-59 months: a cohort study in Adami Tulu District, Ethiopia. Trop Med Int Health. 2015;20(Suppl. 1):294.
Crookston BT, Alder SC, Boakye I, Merrill RM, Amuasi JH, Porucznik CA, Stanford JB, Dickerson TT, Dearden KA, Hale DC, et al. Exploring the relationship between chronic undernutrition and asymptomatic malaria in Ghanaian children. Malar J. 2010;9(1):39.
Deribew A, Alemseged F, Tessema F, Sena L, Birhanu Z, Zeynudin A, Sudhakar M, Abdo N, Deribe K, Biadgilign S. Malaria and under-nutrition: a community based study among under-five children at risk of malaria, south-West Ethiopia. PLoS One. 2010;5(5):e10775.
el Samani FZ, Willett WC, Ware JH. Nutritional and socio-demographic risk indicators of malaria in children under five: a cross-sectional study in a Sudanese rural community. J Trop Med Hyg. 1987;90(2):69–78.
Jeremiah ZA, Uko EK. Childhood asymptomatic malaria and nutritional status among Port Harcourt children. East Afr J Public Health. 2007;4(2):55–8.
Kateera F, Ingabire CM, Hakizimana E, Kalinda P, Mens PF, Grobusch MP, Mutesa L, van Vugt M. Malaria, anaemia and under-nutrition: three frequently co-existing conditions among preschool children in rural Rwanda. Malar J. 2015;14(1):440.
Maketa V, Mavoko HM, da Luz RI, Zanga J, Lubiba J, Kalonji A, Lutumba P, Van Geertruyden J-P. The relationship between Plasmodium infection, anaemia and nutritional status in asymptomatic children aged under five years living in stable transmission zones in Kinshasa, Democratic Republic of Congo. Malar J. 2015;14(1):83.
Mamiro PS, Kolsteren P, Roberfroid D, Tatala S, Opsomer AS, Van Camp JH. Feeding practices and factors contributing to wasting, stunting, and iron-deficiency anaemia among 3-23-month old children in Kilosa district, rural Tanzania. J Health Popul Nutr. 2005;23(3):222–30.
PubMed Google Scholar
Sumbele IUN, Bopda OSM, Kimbi HK, Ning TR, Nkuo-Akenji T. Nutritional status of children in a malaria meso endemic area: cross sectional study on prevalence, intensity, predictors, influence on malaria parasitaemia and anaemia severity. BMC Public Health. 2015;15(1):1099.
Uscategui Penuela RM, Perez Tamayo EM, Corrales Agudelo LV, Correa Botero A, Estrada Restrepo A, Carmona Fonseca J. Relationship between malaria, malnutrition, food insecurity and low socioeconomical conditions in children of Turbo, Colombia. Perspectivas en Nutricion Humana. 2009;11:153–64.
Download references
Acknowledgements
The authors gratefully acknowledge the assistance of Eli Harriss with database searches and Per Olav Vandvik for reviewing the methods of the manuscript. The authors are also very grateful to Prabin Dahal, Makoto Saito, Andrea Stewart and Alex Gardiner for their valuable comments on the manuscript.
WorldWide Antimalarial Resistance Network (WWARN) is funded by the Bill and Melinda Gates Foundation. EAO is supported by the Wellcome as an Intermediary Fellow (# 201866) and also acknowledge the support of the Wellcome to the Kenya Major Overseas Programme (# 077092 and 203077).
Availability of data and materials
All the data used in this review has been presented in the main text either as tables or as supplementary files. Additional requests for the data can be made through the WorldWide Antimalarial Resistance Network ( www.wwarn.org ). Please email: [email protected]
Author information
Authors and affiliations.
WorldWide Antimalarial Resistance Network (WWARN), Oxford, UK
D Das, K Stepniewska, R Mansoor, J Tarning & P J Guerin
Centre for Tropical Medicine and Global Health, Nuffield Department of Clinical Medicine, University of Oxford, Oxford, UK
Mahidol Oxford Tropical Medicine Research Unit, Faculty of Tropical Medicine, Mahidol University, Bangkok, Thailand
Epicentre, Paris, France
Médecins Sans Frontières, Amsterdam, Netherlands
S van der Kam
Liverpool School of Tropical Medicine, Liverpool, UK
D J Terlouw
Kemri Wellcome Trust Research Programme, Kilifi, Kenya
Division of Clinical Pharmacology, Department of Medicine, University of Cape Town, Cape Town, South Africa
WorldWide Antimalarial Resistance Network (WWARN) Pharmacology, University of Cape Town, Cape Town, South Africa
Malawi-Liverpool Wellcome Trust Clinical Research Programme, Blantyre, Malawi
College of Medicine, University of Malawi, Blantyre, Malawi
You can also search for this author in PubMed Google Scholar
Contributions
PJG conceived the concept of the review and supervised and coordinated the project. DD and RM reviewed literatures and extracted data. KS and RM reviewed the methodology and data analysis. DD drafted the manuscript. KIB, RFG, EO, SK, KS and PJG reviewed and edited drafts of the manuscript. DJT and JT provided intellectual input on the review. All authors read and approved the final version of the manuscript.
Corresponding author
Correspondence to P J Guerin .
Ethics declarations
Ethics approval and consent to participate.
Not applicable.
Consent for publication
Competing interests.
The authors declare that they have no competing interests.
Publisher’s Note
Springer Nature remains neutral with regard to jurisdictional claims in published maps and institutional affiliations.
Additional files
Additional file 1:.
PubMed, Global Health, Cochrane database search terms (DOCX 15 kb)
Additional file 2:
PRISMA checklist (DOC 67 kb)
Additional file 3:
The methodological quality of the included studies (DOCX 33 kb)
Additional file 4:
Characteristics of the selected studies ( N = 33) (XLSX 12 kb)
Additional file 5:
Graphical presentation of reported risk estimates by nutritional status (DOCX 135 kb)
Rights and permissions
Open Access This article is distributed under the terms of the Creative Commons Attribution 4.0 International License ( http://creativecommons.org/licenses/by/4.0/ ), which permits unrestricted use, distribution, and reproduction in any medium, provided you give appropriate credit to the original author(s) and the source, provide a link to the Creative Commons license, and indicate if changes were made. The Creative Commons Public Domain Dedication waiver ( http://creativecommons.org/publicdomain/zero/1.0/ ) applies to the data made available in this article, unless otherwise stated.
Reprints and permissions
About this article
Cite this article.
Das, D., Grais, R.F., Okiro, E.A. et al. Complex interactions between malaria and malnutrition: a systematic literature review. BMC Med 16 , 186 (2018). https://doi.org/10.1186/s12916-018-1177-5
Download citation
Received : 24 April 2018
Accepted : 20 September 2018
Published : 29 October 2018
DOI : https://doi.org/10.1186/s12916-018-1177-5
Share this article
Anyone you share the following link with will be able to read this content:
Sorry, a shareable link is not currently available for this article.
Provided by the Springer Nature SharedIt content-sharing initiative
- Anthropometry
- Underweight
BMC Medicine
ISSN: 1741-7015
- Submission enquiries: [email protected]
- General enquiries: [email protected]
Open Access is an initiative that aims to make scientific research freely available to all. To date our community has made over 100 million downloads. It’s based on principles of collaboration, unobstructed discovery, and, most importantly, scientific progression. As PhD students, we found it difficult to access the research we needed, so we decided to create a new Open Access publisher that levels the playing field for scientists across the world. How? By making research easy to access, and puts the academic needs of the researchers before the business interests of publishers.
We are a community of more than 103,000 authors and editors from 3,291 institutions spanning 160 countries, including Nobel Prize winners and some of the world’s most-cited researchers. Publishing on IntechOpen allows authors to earn citations and find new collaborators, meaning more people see your work not only from your own field of study, but from other related fields too.
Brief introduction to this section that descibes Open Access especially from an IntechOpen perspective
Want to get in touch? Contact our London head office or media team here
Our team is growing all the time, so we’re always on the lookout for smart people who want to help us reshape the world of scientific publishing.
Home > Books > Malaria - Transmission, Diagnosis and Treatment
Malaria: Transmission, Diagnosis, Treatment and Prevention in Indonesia
Submitted: 19 June 2023 Reviewed: 23 August 2023 Published: 30 October 2023
DOI: 10.5772/intechopen.112982
Cite this chapter
There are two ways to cite this chapter:
From the Edited Volume
Malaria - Transmission, Diagnosis and Treatment
Edited by Linda Eva Amoah, Festus Kojo Acquah and Kwame Kumi Asare
To purchase hard copies of this book, please contact the representative in India: CBS Publishers & Distributors Pvt. Ltd. www.cbspd.com | [email protected]
Chapter metrics overview
90 Chapter Downloads
Impact of this chapter
Total Chapter Downloads on intechopen.com
Total Chapter Views on intechopen.com
Malaria is a disease caused by Plasmodium and is characterized by recurrent fever, anemia, and hepatosplenomegaly. There are five species of Plasmodium that can infect humans. P. falciparum causes the most deaths, as do P. vivax, P. ovale, and P. malariae which usually cause mild malaria. The aim of this research is to determine the meaning, classification, epidemiology, symptoms, pathogenesis, diagnosis, mode of transmission, prevention, and treatment of malaria. Research method: This research is a descriptive observational study with a literature review design using databases from Google Scholar, accredited national journal Sinta, and reputable international journals such as Scopus, PubMed, Web of Science, and others. The research results show that malaria cases are still high in Indonesia every year. There are several risk factors for malaria such as attitude, behavior, environment, and physical environmental factors where you live, such as (temperature, humidity, livestock pens, houses without screen ventilation, stagnant water, or breeding places). Malaria treatment depends on several factors, including the type of Plasmodium that causes infection, the severity of the disease, and the disease the individual is suffering from. Prevention efforts need to be made by addressing various risk factors for malaria.
- transmission
Author Information
Fitriani kahar *.
- Department of Health Analyst, Ministry of Health Polytechnic, Semarang, Indonesia
Yuwono Setiadi
- Department of Nutrition, Ministry of Health Polytechnic Semarang, Indonesia
S.Y. Didik Widiyanto
Depri ardiyansyah.
- Department of Environmental Health, Health Polytechnic Ministry of Health, Semarang, Indonesia
Nurul Qomariyah
*Address all correspondence to: [email protected]
1. Introduction
The disease caused by Plasmodium is malaria, which is characterized by recurrent fever, anemia, and hepatosplenomegaly. This disease varies from acute to chronic. During the acute phase, attacks of fever sometimes occur. During subsequent chronic stages, there are latent phases separated at relapse in recent times [ 1 ]. Malaria is also a health problem that causes death, especially in high-risk groups such as infants, pregnant women, children under five. Malaria also causes anemia and reduces work [ 2 ]. Malaria is an endemic disease in Indonesia and affects all components of the blood. The most common complications are anemia and thrombocytopenia. This is a concern of the scientific literature because it is associated with mortality [ 3 ]. Indonesia is a tropical country so that malaria is an infectious disease, especially in some areas which are said to be endemic, especially outside Java, such as Jayapura and others [ 4 ].
The type of Plasmodium that causes the infection determines the intensity of the symptoms of malaria. Four species of Plasmodium are known: Plasmodium vivax , is one of the most common infections causing vuvax or tertian malaria or vivax; Plasmodium falciparum , which causes tropical malaria or falciparum malaria, and causes malaria quartana or malriae, nephrotic syndrome and plasmodium ovale which are found in the West Pacific and Africa, resulting in milder outbreaks and frequent outbreaks [ 5 ]. There are other species that also cause malaria, that is Plasmodium knowlesi [ 6 ]. In severe cases will occur malaria cerebral which also has a fatal impact. Nationally, cases have decreased but are still frequently found throughout Indonesia. This disease requires expertise from an appropriate clinical perspective in determining the diagnosis and therapy in patients. Currently, the management of cerebral malaria in Indonesia is guided by the 2017 Malaria Case Management Book [ 5 ].
In many countries around the world, malaria is still a public health problem. Even though the Malaria Implementation and Eradication Program has been started since 1959, the mortality and morbidity rates are still high in this country of Indonesia. Every year, 300 million people are attacked and 2–4 million die. Therefore, the Ministry of Health assesses malaria as a very important problem [ 1 ].
In 2010 in Indonesia there were 65% of endemic districts where only about 45% of the population in these districts was at risk of contracting malaria. Based on the results of a community survey during 2007–2010, the prevalence of malaria in Indonesia decreased from 1.39% (Riskesdas 2007) to 0.6% (Riskesdas 2010). Meanwhile, based on reports received during 2000–2009, the malaria morbidity rate tended to decrease, namely 3.62 per 1000 population in 2000 to 1.85 per 1000 population in 2009 and 1.96 in 2010. Meanwhile, the death rate due to malaria reached 1.3% [ 2 , 7 ].
The national prevalence of malaria based on the 2010 Riskesdas results was 0.6% where provinces with API above the national average were West Nusa Tenggara, Maluku, North Maluku, Central Kalimantan, Bangka Belitung, Riau Islands, Bengkulu, Jambi, Central Sulawesi, Gorontalo and Aceh. The highest prevalence rates were found in eastern Indonesia, namely in West Papua (10.6%), Papua (10.1%) and East Nusa Tenggara (4.4%) [ 2 ].
Symptoms that patients show upon their arrival at Manado Central Hospital (now known as Bethesda Omolon Hospital and Prof.dr. R.D.Kandou Hospital. In 1993, malaria cases at Bethesda Tomohon Hospital showed objective symptoms of icterus 3.0%, hepatomegaly 43%, splenomegaly 40.7%, and pallor 6.6%.Other common symptoms are vomiting 31–37%, dizziness 75–82%, nausea 74–76%, chills 64–82%, and fever 92–96% [ 1 ].
In North Sulawesi, Indonesia, especially in North Sulawesi Hospitals and Health Centers, malaria itself is a disease that is often found. Malaria infection accounts for 9% of hospitalizations, there are 400 cases of mild malaria and 30–40 cases of severe malaria each year, and 6–7 of them die every year. There is a mortality rate from malaria reaching 15.7% in the most common problems that arise are jaundice and kidney failure in Manado City [ 1 ].
In South Jayapura District, Indonesia, it is an endemic area with the third highest malaria rate of the 5 districts in Jayapura city. Malaria cases in Jayapura City in 2019 were 28,648 cases with an API of 92.55/1000 population, in 2020 there were 28,075 cases with an API of 89.35/1000 population, while in 2021 there were 30,235 cases with an API of 99.49/1000 population [ 8 ].
Problem Formulation
What is the meaning or definition of malaria?
What is the epidemiology of malaria?
How is malaria classified?
What is the scope of malaria?
What are the symptoms of malaria?
What are the risk factors for malaria
What is the pathogenesis of malaria?
What is the immune response to malaria?
What are the diagnoses for malaria?
What are the modes of transmission of malaria?
What are the ways to prevent malaria?
What are the ways to treat malaria?
To understand the meaning of malaria
To understand the epidemiology of malaria
To understand the classification of malaria
To understand the scope of malaria
To understand the symptoms of malaria
To understand the risk factors for malaria
To understand the pathogenesis of malaria
To understand the immune response to malaria
To understand the diagnosis of malaria
To understand how malaria is transmitted
To understand how to prevent malaria
To understand how to treat malaria
It is hoped that writing this paper will be useful for readers, especially for people in endemic areas to prevent malaria from occurring. Become a source of scientific literature related to malaria.
2. Methodology
Research method: This research is a descriptive observational study with a literature review design with databases from Google Scholar, Sinta accredited national journals, and reputable international journals such as Scopus, Pubmed, Web of Science and others.
3. Result and discussion
3.1 definition of malaria.
Malaria is an infectious disease caused by the bite of the Anopheles mosquito and Plasmodium parasites. Headache, vomiting, chills, fever, and pain in joints and muscles are symptoms of malaria. If treated properly, certain drugs can cure malaria [ 9 ]. Malaria is a disease that attacks humans, birds, monkeys and other primates, reptiles and rodents caused by infection with protozoa of the genus Plasmodium. The incidence or transmission of infectious diseases is determined by risk factors/determinants called host, agent and environment [ 10 ].
The main cause of this disease is the female Anopheles mosquito which spreads the infection by biting. Anopheles mosquito bites contain parasites in their saliva which enter the blood of the humans they bite. Parasites migrate to the liver, where they mature and reproduce. There are five species of Plasmodium that infect and can infect humans. P. falciparum causes the most deaths, as do P. vivax , P. ovale and P. malaria usually cause milder forms of malaria. P. knowlesi rarely causes disease in humans. A rapid antigen-based test or a microscopic blood test of a blood sample is usually used to diagnose malaria. Due to cost and complexity, methods for detecting parasite DNA using polymerase chain reactions have not been widely used in areas where malaria is common [ 9 ].
3.2 Epidemiology of malaria
Even though there has been a reduction in Annual Parasite Incidence (API) nationally, in areas with high malaria cases the API rate is still very high compared to the national rate, whereas in areas with low malaria cases extraordinary events (KLB) often occur as a result of imported cases. In 2011 the number of reported malaria deaths was 388 case [ 2 ].
Information from the World Health Organization (World Health Organization) in 2013 reported that there were 197 million cases of malaria with 548,000 deaths, and 78% of these cases included child deaths under the age of 5 [ 11 ]. Furthermore, according to WHO, there were 198 million cases of malaria worldwide in 2014, namely 584. Malaria is widespread in many places around the world, especially in tropical and subtropical regions such as Indonesia. In Indonesia, about 35 percent of the population lives in malaria-prone areas. 584,000 deaths from severe malaria each year. Malaria epidemics occur almost every year in several endemic areas in Indonesia [ 4 ]. Areas such as East Nusa Tenggara, West Nusa Tenggara, Maluku, North Maluku, Central Kalimantan, Bangka-Belitung, Riau Islands and Bengkulu are included in the malaria red zone. Next are Jambi, Central Sulawesi, West Sulawesi, Gorontalo and Aceh [ 4 ].
Research results related to the prevalence of malaria show that Malaria sufferers were more at the age of 24–35 years, namely as many as 264 sufferers (41.1%), malaria sufferers were more in the female sex as many as 323 people (50.3%), malaria sufferers were more in patients who worked as private employees, namely 410 people (63.9%). More malaria sufferers were found living in urban areas, namely 447 sufferers (69.6%) [ 12 ].
Here are some common approaches to treating malaria: Malaria is a disease that is naturally transmitted by pathogens (Plasmodium spp.), definitive hosts (Anopheles spp. and intermediate hosts (humans) [ 4 ].
The epidemiological components of malaria consist of: the first pathogen, Plasmodium spp. parasites. Parasites that live in the human body reproduce by consuming red blood cells (RBC), causing anemia in the infected or the host. Second, there are two types of hosts: Humans as intermediate hosts (temporary, because sexual reproduction does not occur) and mosquitoes as definitive hosts (permanent, because sexual reproduction does not occur). Anopheles spp. is a species of mosquito that transmits malaria. However, not all species causes malaria. Plasmodium is spread by malaria, which is bitten by a mosquito (carrier) and then enters the carrier’s body via blood cells in various asexual stages. Endemic malaria [ 4 ].
3.3 Classification of malaria
Malaria is an infectious disease caused by Plasmodium parasites which can be characterized by fever, hepatosplenomegaly, and anemia. Plasmodium lives and reproduces in human red blood cells. This disease is naturally transmitted through the bite of a female Anopheles mosquito.
Plasmodium falciparum ( P. falciparum ).
Plasmodium vivax ( P. vivax )
Plasmodium ovale ( P. ovale )
Plasmodium malariae ( P. malariae )
Plasmodium knowlesi ( P. knowlesi )
The most common types of Plasmodium found in Indonesia are P. falciparum and P. vivax , while P. malariae can be found in several provinces, including Lampung, East Nusa Tenggara, and Papua. P ovale has been found in East Nusa Tenggara and Papua. In 2010 on the island of Borneo it was reported that P. knowlesi could infect humans where previously it only infected primates/monkeys and until now [ 2 ].
According to Harijanto [ 13 ], Malaria is further divided according to its Plasmodium type, including:
3.3.1 Plasmodium falciparum (tropical malaria)
Tropical malaria, also known as tropical falciparum malaria, is the most severe form of malaria. This disease is characterized by anemia, fever, blood parasites, and splenomegaly, often causing complications. The disease lasts 9–14 days. Tropical malaria affects all types of red blood cells caused by Plasmodium falciparum . The only Plasmodium species with duplicated nuclear chromatin in the form of a ring or small rings one-third the diameter of a normal red cell. Spread of tropical malaria is classified when Plasmodium falciparum infects red cells for life, often resulting in the formation of blood cell parasites that produce multiple protrusions that can adhere to the endothelial lining of capillary walls due to thrombotic occlusion and local ischemia. This infection is more serious than other infections and causes many complications such as cerebral malaria, gastrointestinal disorders and black hemorrhagic fever.
3.3.2 Plasmodium malariae (Kwartama malaria)
Tropozoites of Plasmodium malariae which are smaller than Plasmodium vivax have more compact or bluer cytoplasm. Mature trophozoites have dark brown to black grains and are often grouped in groups.
3.3.3 Plasmodium ovale (malaria ovale)
Malaria ovale, known as Plasmodium ovale , is similar in shape to Plasmodium malariae , but the schizont consists of only eight merozoites and has a black mass in the center. Red blood cells infected with Plasmodium ovale are usually oval or irregular in shape with a visible ciliated pattern. Of all the types of malaria caused by Plasmodium ovale , malaria ovale is the mildest. The incubation period varies from 11 to 16 days, but the latent period can be up to 4 years. Attacks last 3 to 4 days without treatment, rarely more than 10 days, and occur at night.
3.3.4 Plasmodium vivax (tertian malaria)
Plasmodium vivax infection, or tertian malaria, can sometimes affect the young red blood cells, which are larger than normal red blood cells. It resembles Plasmodium falciparum in appearance, but vivax trophozoites become amoebae with age. Consists of 12–24 oval merozoites with yellow pigment at the poles. Oval gametocytes occupy almost all of the red blood cells, eccentric chromatin and yellow pigment. Symptoms of this type of malaria last 48 hours as shown in the malaria triad, causing intermittent fever every 4 days, with a peak of fever occurring every 72 hours. Of all the Plasmodium and malaria species that invade the body, tropical malaria is the most important. It is manifested by unstable fever, anemia, splenomegaly, multiple parasites and frequent complications [ 13 ].
3.4 Scope malaria
Malaria is a disease in the world, especially in tropical and subtropical regions, the cause of which is the Plasmodium parasite, which is transmitted through the bite of the Anopheles mosquito [ 14 ].
Geographical breakdown: of 100 countries worldwide, mainly in sub-Saharan Africa, Latin America and parts of Asia. The region where malaria is most common is Africa where malaria is endemic.
The Anopheles mosquito is the main cause of malaria. They bite an infected person and then transmit the Plasmodium parasite to other people when they bite.
Causes and Types of Parasites: Five different types of Plasmodium cause malaria: Plasmodium malariae , Plasmodium vivax , Plasmodium ovale , Plasmodium falciparum , Plasmodium knowlesi is the main cause of malaria, the most dangerous of all.
Clinical Symptoms: Symptoms of malaria include fever, chills, severe headache, nausea, vomiting and fatigue. If left untreated, malaria can become a life-threatening disease. Prevention: Prevention of malaria involves controlling mosquito vectors through use of insecticide-treated nets, use of antimalarial drugs for prophylaxis, administration of vaccines (such as RTS, S vaccine), and use of mosquito bite prevention measures such as anti-mosquito lotions and repellents
Diagnostics and treatment: Diagnosis of malaria involves microscopic examination of blood for the detection of Plasmodium parasites or use of an antigen-based rapid malaria test. Treatment depends on the type of Plasmodium causing the infection and the severity of the disease. Effective antimalarial drugs such as artemisinin-based combination therapy (ACT) are used to treat malaria infection.
Social and economic impacts: Malaria has significant social and economic impacts, especially in areas with a high prevalence. Malaria can cause school and work absences, reduced productivity, and a large economic burden on individuals and communities. Tackling the malaria problem requires a comprehensive approach, including vector prevention, effective treatment, access to diagnosis and treatment, and research for the development of more effective vaccines. Global efforts such as vector control campaigns, distribution of insecticide-treated nets, and vaccination initiatives have helped reduce the global burden of malaria. Significant.
Genetic Aspects of Malaria: Several genetic factors are the main determinants for child survival in malaria endemic countries. Identification of the genes involved and how they affect the risk of malaria can provide a mechanism for studying the host-parasite relationship. Several gene polymorphisms associated with malaria are Human Red Blood Cell Polymorphisms [ 15 ].
3.5 Symptoms of malaria
Manifestations of malaria are fever, anemia and enlargement of the spleen [ 16 ].
In people who have been taking antimalarial drugs for prevention, symptoms of malaria may appear later, usually 8 to 25 days after infection. In all types of malaria, the illness is generally flu-like and can mimic sepsis, gastroenteritis, and viruses. Symptoms include: Headache, fever and chills, arthralgia, vomiting, hemolytic anemia, jaundice, urinary hemoglobin, retinal damage and seizures. The main symptoms of malaria are paroxysmal symptoms, including cyclic fever and persistent chills. Then infection with P. vivax and P. ovale on the second day, called tertiary fever, and every third day, called quarantine fever, with P. falciparum can cause recurring fever every 36 to 48 hours or less. One, almost constant fever. Plasmodium falciparum , commonly called falciparum malaria, is the main cause of severe malaria. Symptoms of falciparum malaria appear 9 to 30 days after infection. Neurologic symptoms such as nystagmus, postural disturbances, opisthotonos, seizures or coma are common in individuals with cerebral malaria [ 17 ].
3.6 Risk factors of malaria
3.6.1 characteristics of the physical environment.
Based on the results of the research that has been carried out, factors that can occur are caused by the roof/wall of the house that is not tightly closed due to the type of wall made of boards or plywood, there is no ceiling, the ventilation of the house does not use gauze, there is a pool of water or breeding place such as (gutters, ponds and swamps) as well as houses close to resting place or bushes. The factors that have been described will result in the presence of Anopheles sp. mosquitoes if not immediately addressed and corrected.
3.6.2 Behavioral characteristics
Lack of public knowledge about the importance of preventing malaria in their environment and lack of support for malaria cases. It can be concluded that the factors that cause malaria are related to the individual’s lack of concern for the environment around his home. Physical environment variables such as the density of the walls of the house, the screens on the ventilation, and the ceilings of the house haverelationship with malaria incidence. In addition, behavioral variables such as actions also play a role in the spread of the disease.
To reduce the risk of malaria, people are expected to keep their homes free of mosquitoes by installing tight walls, ceilings and screens for ventilation. In addition, they expect more attention to the environment around the house by adopting environmental management practices, that is, H. save, empty, clean and empty clogged drains and trim bushes.
Malaria control efforts involve environmental management, prevention of mosquito bites, treatment of infected cases, as well as education and community participation. This aims to reduce the presence of mosquito vectors and stop the Plasmodium transmission cycle in the human population [ 8 ].
3.7 Pathogenesis of malaria
The rupture of the blood schizont is caused by the release of several antigens and can cause fever in the body. Macrophage cells, monocytes and lymphocytes can be stimulated by antigens to release cytokine types including Tumor Necrosis Factor. And IL-6 V then enters the hypothalamus, the body’s temperature control center. In the four plasmodia it takes a different time for sizogony [ 2 , 18 ].
Excessive destruction of red blood cells in the malaria parasite is the cause of decreased hemoglobin values, and anemia also occurs due to disturbances in the spinal cord in forming red blood cell [ 19 ]. As a result of hemolysis, there is sequestration of erythrocytes in the spleen and other organs, and depression in the bone marrow [ 16 ]. In severe cases, cerebral malaria will occur in a febrile patient with decreased consciousness [ 5 ]. Cerebral malaria is an acute encephalopathy that meets three criteria, namely coma that cannot be awakened, or coma that persists for >30 minutes after the seizure and is accompanied by P. falciparum indicated by a blood smear [ 20 ].
Infected or uninfected red blood cells are damaged, causing anemia. Plasmodium ovale and Plasmodium vivax infect immature erythrocytes, making up 2% of total erythrocytes, and P. malariae only infects mature erythrocytes, making up 1% of total erythrocytes. All types of red blood cells are infected with Plasmodium falciparum , so anemia can occur in both acute and chronic infections. Plasmodium lesions are caused by splenic macrophages and lymphocytes, which are reticular endothelial cells. These inflammatory cells enlarge the spleen. Malignant malaria caused by P. falciparum has a unique pathogenesis. Once infected with P. falciparum , the parasite’s red blood cells spread through the capillaries of the body’s organs. In addition, the bumps that form on the surface of infected red blood cells contain various P. falciparum antigens. Cytokines such as TNF and IL-6, produced by macrophages, monocytes and lymphocytes, activate capillary endothelial cell receptor expression. Cell adhesion occurs when nodules attach to endothelial cell receptors in capillaries. This process causes tissue ischemia due to capillary occlusion. The “asterisk” method - clustering - also supports this inhibition ( Figure 1 ) [ 22 ].

Plasmodium life cycle in general [ 21 ].
3.8 Immune response against malaria
Initial stage: After the parasites enter the body, they will enter the liver and reproduce there. During this stage, the initial immune response will involve immune cells such as macrophages and dendritic cells that recognize the parasite and respond by secreting immune-stimulating molecules such as cytokines.
Erythrocyte phase: After leaving the liver, the parasite enters red blood cells (erythrocytes) and multiplies there. At this stage, the parasite changes shape and secretes waste products that can trigger an immune response.
T cell response: In the fight against malaria infection, T cells, also known as cytotoxic T cells and helper T cells, play an important role. They can recognize parasitic proteins on the surface of infected red blood cells and then act by killing those cells or sending signals to trigger a new immune response.
Antibody response: The immune system also produces antibodies to fight parasites. Antibodies are proteins made by plasma cells that can bind to parasites and destroy them, helping to stop them from growing and preventing them from invading more red blood cells.
Inflammation: Malaria infection often causes systemic inflammation involving the release of cytokines and other inflammatory molecules. This can cause malaria symptoms such as fever, aches, and malaise.
It is important to note that Plasmodium has the ability to evade or trick the human immune system by changing their protein surface on a regular basis. This allows them to evade detection by the immune system and makes it difficult to develop an effective immune response.
The immune response to malaria can be complex and varies depending on the type of parasite, individual immunity, and other factors. Because of this complexity the development of an effective vaccine for malaria has become a significant challenge in the management of this disease. However, research and efforts are continuing to understand the mechanisms of the immune response and develop effective vaccination strategies [ 15 , 23 ].
3.9 Diagnosis of malaria
Recent travel notes
The spleen develops
Low platelet count
Higher than normal blood bilirubin levels in combination with a normal white blood cell count.
Blood smear microscopy or rapid antigen-based test (RDT) is often used to confirm the diagnosis of malaria. In 2010, approximately 165 million meninges were tested for malaria, and microscopy is the most commonly used method of identifying malaria parasites. Despite its widespread use, microscopy has two major drawbacks [ 2 ].
In border areas, many testing facilities are not well equipped and the accuracy of results depends on the performance of blood membrane testing kits and the number of parasites in the blood. The sensitivity of blood samples varies between 75 and 90°, up to 50% under optimal conditions. Commercially available RDTs are often more accurate than blood films in predicting the presence of malaria parasites, but their diagnostic sensitivity and specificity vary widely between manufacturers and cannot be determined. Any healthy person who has traveled to a malaria endemic area should be suspected of having malaria and examined where tests are available. In places where laboratory diagnostic tests cannot be performed, the use of pre-existing fever as an indication for treatment of malaria has become widespread. As a result, the popular notion that “fever is synonymous with malaria if proven otherwise” has spread. Malaria over diagnosis and poor non-malarial therapy limit this approach, consume limited resources, reduce trust in the health system and increase drug resistance. Although assays that rely on polymerase chain reaction have been developed, their complexity has prevented their widespread use in areas where malaria is common. Increased resistance to polymerase chains has been developed, but because of its complexity it is not widespread in areas where malaria is common [ 2 ].
3.10 Transmission of malaria
The determinants of malaria transmission are divided into two broad categories. First, the factors that have a direct effect, the average mosquito bites humans in a day, the average Plasmodium gametocytes in the population, the length of the sporogonic cycle in the mosquito’s body, the average daily survival rate of mosquitoes. Second, indirect factors, including environment and climate, rainfall, drought, management of the artificial environment, changes in vector biting patterns, air temperature, humidity, importation of malaria parasites through population movements and migration of non-immune populations [ 24 ].
Anopheles mosquito bites: The main cause of malaria is the bite of the Anopheles mosquito. When a mosquito bites a person infected with malaria, Plasmodium in their blood can enter the mosquito’s body. When the mosquito bites another person, Plasmodium infects the person bitten and causes a malaria infection.
Blood transfusion: In rare cases, malaria can also be transmitted by blood transfusion. When a person with malaria donates blood, Plasmodium in the blood can infect the recipient.
The use of syringes that are contaminated with blood containing Plasmodium can also be a source of malaria transmission. This can happen if needles are used simultaneously by people infected with malaria and other people without adequate sterilization procedures.
Perinatal Transmission: It is possible for malaria to be transmitted from a pregnant woman who is infected with malaria to her baby during pregnancy or childbirth. This is known as perinatal transmission [ 4 ].
3.11 Prevention of malaria
Efforts to eradicate malaria in Indonesia have not achieved optimal results due to several factors such as the prevalence of malaria mosquitoes, the high number of cases, human resources, costs and infrastructure. Therefore, the best course of action is to prevent and stop the spread of the parasite. Many efforts can be made to prevent and eradicate the spread of malaria parasite [ 25 ].
Methods for preventing mosquito bites are particularly important in high prevalence areas. It is recommended to wear long sleeves and long pants when going out, especially at night, in rural or suburban areas with lots of rice fields, swamps or fish ponds (ideal breeding grounds for malaria-carrying mosquitoes).
Efforts to reduce morbidity and mortality are carried out through a malaria eradication program whose activities include early diagnosis, prompt and appropriate treatment, and vector surveillance and control in terms of public education and understanding of environmental health, all of which are aimed at breaking the chain of malaria transmission.
Resistance cases of malaria parasites to chloroquine were first discovered in East Kalimantan in 1973 for P. falciparum , and in 1991 for P. vivax in Nias. Since 1990, cases of resistance have been reported to have spread in all provinces in Indonesia. In addition, there have also been reports of resistance to Sulfadoxine-pyrimethamine (SP) in several places in Indonesia. This situation can increase the morbidity and mortality of malaria. Therefore, to overcome this problem of resistance (multiple drug resistance) and the existence of new anti-malarial drugs that are more patent, the government has recommended drugs of choice to replace chloroquine and SP, namely a combination of artemisinin derivatives with other anti-malarial drugs which are commonly referred to as Artemisinin based [ 2 ].
3.12 Treatment of malaria
Antimalarial drugs: Antimalarial drug therapy is the main step in the treatment of malaria. Several types of drugs are used including:
Artemisinin-based combination therapy (ACT) This is the standard treatment for malaria caused by Plasmodium falciparum . ACT combines artemisinin compounds with other antimalarial drugs to treat infections.
Chloroquine: Chloroquine is usually used to treat malaria caused by Plasmodium malariae , Plasmodium vivax and Plasmodium ovale . However, many areas of the world report resistance to chloroquine, limiting its use. Other drugs: There are other antimalarial drugs used in the treatment of malaria, such as mefloquine, doxycycline, atovaquone/proguanil, and kinin. The choice of drug depends on the type of Plasmodium and the level of resistance in the affected area [ 26 ].
Supportive therapy. In severe cases of malaria, supportive therapy may be required. This involves monitoring and managing symptoms such as high fever, dehydration, electrolyte disturbances, anemia, and organ dysfunction. In some cases, hospitalization may be required for more intensive monitoring and adequate treatment.
Prevention of complications: Malaria can cause serious complications, such as severe anemia, respiratory problems, kidney failure and neurological disorders. Prevention and treatment of these complications is also an important part of malaria management.
It is important to note that antimalarial drug resistance is becoming an increasingly serious problem in some areas. Therefore, it is important to follow medication recommendations and consult a doctor who is experienced in treating malaria. In addition to treatment, prevention of malaria is essential, including the use of insecticide-treated nets and the prophylactic use of antimalarial drugs for those living in or traveling to remote areas. Use of mosquito repellents and control of mosquito vectors through eradication programs or the use of chemical insecticides ( Table 1 ) [ 9 ].
| No | Researcher | Research title | Results | Discussion |
|---|---|---|---|---|
| 1 | Ragil Setiabudi, [ ] | Systematic Review: Risk of Malaria as an Infectious Disease in Indonesia | Based on the similarity of variables between researchers, there are 21 significant risk factors statistically, namely the presence of mosquito breeding places, without screens/barriers on ventilation of the house, not using mosquito coils, presence of bushes, presence of puddles water, presence of paddy fields, presence of ditches/gutches, presence of animal cages, poor housekeeping, house walls not tight, no ceiling, construction of non-permanent house floors, frequent activities outside the home at night, not using mosquito nets when sleeping, hanging clothes in the house, not using pesticides/insecticides, not using mosquito repellant/topical repellant, low education, income below the minimum wage, non-compliance with taking medication, malnutrition status with an average OR = 5.30. Minimum value OR = 0.26 and maximum value OR = 16.92. There are only two protective factors, namely frequent using mosquito nets on the bed (OR = 0.26) and having a ceiling (OR = 0.69). | Risk factors for malaria incidence in Indonesia which means statistically there are 21 namely the presence of mosquito breeding places, without gauze/barrier on ventilation house, do not use mosquito coils, the presence of bushes, the presence of standing water, there are rice fields, there are ditches/ditches, existence of animal cages, cleanliness bad house, the walls of the house are not tight, no ceiling house, construction house floors are not permanent, often outdoor activities at night did not use mosquito nets at the time sleep, hang clothes inside house, do not use pesticides/insecticides, do not use repellant/repellent topical medication mosquitoes, primary education, income in below the minimum wage, non-compliance taking medication, poor nutritional status. The average OR for the incidence of Malaria is 5.30 The protective factor for the occurrence of Malaria is the frequent use of mosquito nets on the bed and the presence of a ceiling |
| 2 | Utami, Tya Palpera Hasyim, Hamzah Kaltsum, Ummi Dwifitri, Uthu Meriwati, Yanti Yuniwarti, Yuniwarti Paridah, Yusro Zulaiha, Zulaiha [ ] | Risk Factors Causing Malaria in Indonesia: Literature Review | Malaria is still a disease with high cases in Indonesia for everyone the year. Factors that cause malaria in Indonesia consist of factors people’s behavior and attitudes (nighttime activities, use of anti-inflammatory drugs) mosquitoes and use of mosquito nets), environmental factors and the physical environment place of residence (presence of livestock pens, presence of bushes, presence of watery rice fields, temperature, humidity, presence of wires on ventilation, the condition of the ceiling of the residence, and the density of the walls of the house). One of ways to prevent and combat malaria by increasing individual and environmental sanitation. | Community behavior and attitudes Public awareness can be seen from the preventive measures taken such as [ ] The habit of staying out late at night, [ ] Carrying out environmental health activities, [ ] Using mosquito nets. The purpose of using mosquito nets while sleeping is to limit mosquitoes that are infected with bite healthy people and healthy mosquitoes bite sick people, [ ] Using household mosquito repellents. Household insecticides are anti-mosquito products that are often used by the community, such as mosquito coils and anti-mosquito sprays [ ] Use of mosquito repellents [ ]. Use of Body Cover, [ ] Installation of Gauze Wire on window doors to prevent mosquitoes from entering the house Environmental factor Physical environmental factors of the house (temperature, humidity, the presence of wires on the ventilation, the existence of the ceiling of the house, and the density of the walls of the house). The spread of malaria depends on the interaction between the carrier agent, the host and the environment. The environment that plays a role in the bionomic development of mosquitoes is the physical environment and the biological environment. The environment has a major influence on the incidence of malaria. The existence of brackish water lakes, stagnant water in forests, rice fields, fish ponds, clearing of forests and mining in an area will increase because these places are places where malaria mosquitoes spread. |
| 3 | Suwito Hadi, Upik Kesumawati Sigit, Singgih H Sukowati, Dan Supratman [ ] | Climate Relations, Density Anopheles mosquito and Genesis Malaria disease | mosquito is a type of mosquito that is influential in Rajabasa Subdistrict and Weather Mirror Field have no relationship means the number of Anopheles mosquitoes. | The Rajabasa sub-district found 10 species of Anopheles that came into contact with humans, namely , , , , , , , , and . The Padangcermin sub-district found eight species of Anopheles that came into contact with humans, namely , , , , , , and group. The mosquito is the dominant species in Rajabasa and Padang-mirror sub-districts, as shown by the very high number of bites per person per hour (MHD) compared to other species. The increase in air humidity and rainfall is directly proportional to the increase in mosquito density. Rainfall has a significant relationship with mosquito density Anopheles, while the density of Anopheles mosquitoes has a significant relationship with malaria cases 1 month later. |
| 4 | Permadani, Yudea Patungo, Viertianingsih Nompo, R [ ] | literature Review: Community Behavior in Malaria Prevention | Research result This literature shows that the level of knowledge, the attitudes and actions of the community in the prevention of malaria are still low so that it affects the low malaria prevention behavior such as the use of mosquito nets in the community and use of mosquito repellents and installation of wire netting on house ventilation. Public awareness in preventing malaria is shown in behavior community through keeping the environment clean, insecticide-treated mosquito nets, wire netting on ventilation houses, counseling health workers and the use of anti-mosquito drugs. This behavior delivers | The environment is very important in the prevention of malaria. The areas where people live mostly have bushes around the house, some people also live near rivers where there is still a lot of plastic waste scattered which causes mosquitoes to breed. The existence of malaria mosquitoes in an area is very dependent on the environment, where they are often found mosquito breeding around terraced rice fields and irrigation canals. Another effort is to do 3 M (draining, closing and burying) Draining is cleaning a place that is often used as a water reservoir such as a bathtub, water bucket, drinking water reservoir, refrigerator water reservoir and others. Installation of wire netting in the ventilation holes of the house is one step to limit the entry of malaria-transmitting mosquitoes into the house. The most widely used types of mosquito repellents are the types of mosquito coils and anti-mosquito lotions. People who are used to using mosquito repellents while sleeping or outside the home are aware of the dangers of malaria Apart from installing ventilation screens at home, health workers very rarely conduct counseling so that not much information is obtained by the community about the incidence of malaria |
| 5. | Fitriani Kahar, Djoko Priyatno, Beatrix Marta Meo [ ] | Study Of Erythrocyte Index In Malaria Positive Diagnosis Patients | Research on examining the value of the erythrocyte index in patients with a positive diagnosis of malaria using the manual method can be concluded that there is an MCV that is less than normal is 50%, normal is 50% and which is more than normal is 0%. MCH less than is 35%, normal 65%, and more than normal 0%. MCHC that is less than normal and more than normal is 0% while the normal is 100%. | In addition, a definite diagnosis of malaria is by microscopic examination and finding malaria parasites in the blood and supported by clinical symptoms in patients. On positive patient blood smears malaria, visible differences in blood cells red and forms of the malaria parasite. Next, check the quantity erythrocyte and hematocrit values. Malaria infection is one of the main infectious diseases that occur in the world that causes infection in humans humans with fever periodic occurrence of fever due to infection from malaria parasites (including protozoa) transmitted by Anopheles mosquitoes. Manifestations of malaria are fever, anemia and spleen enlargement. The life cycle of the parasite takes place in humans and in mosquitoes. |
Table of literature research results.
4. Conclusions
Tackling the malaria problem requires a comprehensive approach that includes vector prevention, effective treatment, access to diagnosis and treatment, and research to develop more effective vaccines. Global efforts such as vector control campaigns, distribution of insecticide-treated bed nets and vaccination initiatives have helped reduce the global burden of malaria.
There are several risk factors for the occurrence of malaria such as attitudes, behavior, environment and physical environmental factors of residence such as (temperature, humidity, presence of cattle pens, the house is not ventilated through gauze, there are stagnant water or breeding grounds. Treatment of Malaria Treatment of malaria depends on several factors, including the type of Plasmodium that causes the infection, the severity of the disease and the individual’s illness. It is necessary to carry out prevention efforts by addressing various risk factors for malaria to prevent cases of malaria. One way to prevent and overcome malaria is to improve individual and environmental sanitation.
Acknowledgments
Thank you to the Poltekkes Kemenkes Semarang who have contributed invaluable in writing this scientific paper, and to the team that has assisted in collecting data in this study.
Conflict of interest
No conflicts of interest are disclosed by the authors.
Notes/thanks/other declarations
The concept of this paper was developed by F.K, Y.S, S.Y.D.W, D.A, and NQ, who also wrote the script. The final manuscript submitted has been read and approved by all authors.
- 1. Purwanto DS, Ottay RI. Profile of malaria disease in inpatients at the regional general hospital in Bitung city. Journal of Biomedicine. 2013; 3 (3):172-178. Available from: file:///C:/Users/Amir/Downloads/jm_biomedik,+6.+Nu+Profil+penyakit+malaria+(7hal).pdf
- 2. Republic of Indonesia Ministry of Health. Regulation of the minister of health of the Republic of Indonesia No. 5 of 2013 concerning guidelines for malaria management. In: Regulation of the Minister of Health of the Republic of Indonesia. Jakarta: RI Ministry of Health; 2013. pp. 5-62. Available from: www.djpp.depkumham.go.id
- 3. Natalia D. The role of platelets in the pathogenesis of malaria. Majalah Kedokteran Andalas. 2015; 37 (3):219
- 4. Hakim L. Malaria: Epidemiology and diagnosis. Aspirator. 2011; 3 (2):107-116. Available from: https://media.neliti.com/media/publications-test/53932-malaria-epidemiologi-dan-diagnosis-cad38e4c.pdf
- 5. Mawuntu AHP. Cerebral malaria. Journal of Synapse. 2018; 1 (3):1-21
- 6. Singh B, Daneshvar C. Human infection and detection of plasmodium knowlesi. Clinical Microbiology Reviews. 2013; 26 :165-184
- 7. WHO. World Malaria Report 2005 [Internet]. WHO. 1AD. Available from: https://www.malariaconsortium.org/userfiles/file/Malariaresources/WMReport_lr.pdf
- 8. Madayanti S, Raharjo M, Purwanto H. Risk factors affecting malaria incidents in the South Jayapura district, Jayapura city. Journal of Indonesian Environmental Health. 2022; 21 (3):358-365
- 9. Supranelfy Y, Oktarina R. Description of malaria disease prevention behavior in South Sumatra (advanced analysis of Riskesdas 2018). Balaba J R & D for Control of Animal-Based Diseases of Banjarnegara. 2021; 17 (1):19-28. Available from: http://ejournal2.bkpk.kemkes.go.id/index.php/blb/article/view/3556
- 10. Sitepu R, Lukito A, Tarigan E. Determinant analysis of malaria disease in Kutambaru District in 2017. Journal of Medicine and Health Sciences. 2018; 5 (3):165-173. Available from: https://ejurnalmalahayati.ac.id/index.php/kesehatan/article/view/165-173/pdf
- 11. World Health Organization. World Malaria Report. WHO Global Malaria Programme; 2012. p. 195. [Internet]. ISBN: 9789241564533. Available from: http://www.who.int/malaria/world_malaria_report_2012/en/ , https://www.who.int/publications/i/item/9789241564533
- 12. Alim A, Adam A, Dimi B. Prevalence of malaria based on socio demographic characteristics. Journal of Health Sciences. 2020; 19 (1):4-9
- 13. Harijanto P. Malaria, Epidemiology, Pathogenesis, Clinical Manifestations and Treatment. Jakarta: EGC; 2000. Available from: http://elib.unisa-bandung.ac.id/index.php?p=show_detail&id=4309
- 14. Ngambut K, Sila O. Environmental factors and community behavior about malaria in East Kupang District, Kupang regency. National Public Health Journal. 2013; 7 (6):271-278. Available from: https://jurnalkesmas.ui.ac.id/kesmas/article/view/37
- 15. Wahyuni S. Gene polymorphism in malaria. Averrous Journal Medical and Health Malikussaleh. 2018; 2 (1):35. Available from: https://ojs.unimal.ac.id/averrous/article/view/411/335
- 16. Fitriany J, Sabiq A. Malaria. Journal of Averrous. 2018; 4 :2
- 17. Selvia D. Leaving the house at night and using insecticide nets for malaria in Lempasing village. Journal of Health Sciences. 2019; 1 (2):88-95. Available from: https://salnesia.id/jika/article/view/29
- 18. Miller LH, Baruch DI, Marsh K, Doumbo OK. The pathogenic basis of malaria. Pathogesis Basis Malar. 2002; 415 (6872):673-679. Available from:. DOI: 10.1038/415673a
- 19. Isnaini H, Kristinawati E, Rohmi A. Hemoglobin levels and platelet counts on malaria positivity at the Meninting and Gunung sari health centers in West Lombok. Jurnal Analis Medika Biosains (JAMBS) [Journal of Medical Analysts Biosciences]. 2018; 5 (2):107-113. Available from: http://jambs.poltekkes-mataram.ac.id/index.php/home/article/view/114
- 20. Husna M, Prasetyo BH. Review of biomolecular aspects and updates on cerebral malaria therapy. MNJ. 2016; 2 (2):79-88
- 21. CDC. Malaria: Biology. Centers For Disease Control and Prevention (CDC); 2020. p. 1. Available from: https://www.cdc.gov/malaria/about/biology/index.html
- 22. Dinata A. Plasmodium and the Life Cycle of the Malaria Parasite (World Malaria Day Records). Indonesia: Publikasi; 2022. p. 1. Available from: https://litbangkespangandaran.litbang.kemkes.go.id/plasmodium-dan-daur-hidup-parasit-malaria-catatan-hari-malaria-sedunia/
- 23. Mukh S. The role of immune factors and protein profiles in research and development of irradiated malaria vaccines. Biosaintifika: Journal of Biology & Biology Education. 2014; 6 (1):8-17
- 24. Solikhah S. Identification of malaria vectors. Public Health National Public Health Journal. 2013; 7 (9):402-407
- 25. WHO. Future Malaria Treatment. South-East Asia Indonesia: WHO; 2021. Available from: https://www.who.int/indonesia/news/campaign/world-malaria-day-2021/pengobatan-malaria-masa-depan
- 26. Guerin PJ, Olliaro P, Nosten F, Druilhe P, Ramanan Laxminarayan Binka F, Kilama WL, et al. Malaria: Current status of control, diagnosis, treatment, and a proposed agenda for research and development. Lancet. 2002; 2 (9):567-573. Available from: https://www.thelancet.com/journals/laninf/article/PIIS1473-3099(02)00372-9/fulltext
- 27. Setiabudi R. Risk factors for malaria as an infectious disease. Medicines Journal Ilm Health Sciences. 2016; 14 (1):53-64
- 28. Utami TP, Hasyim H, Kaltsum U, Dwifitri U, Meriwati Y, Yuniwarti Y, et al. Risk factors causing malaria in Indonesia: Literature review. Journal of Surya Medicine. 2022; 7 (2):96-107
- 29. Suwito HUK, Sigit SH, Sukowati DS. Relationship of climate, density of anopheles mosquitoes and malaria disease incidence. Journal Entomology Indonesia. 2010; 7 (1):42-53
- 30. Permadani Y, Patungo V, Nompo RS. Literature review: Community behavior in preventing malaria. Sentani Nursing Journal. 2022; 5 (2798-5075):21-28. Available from: https://ejournal.stikesjypr.ac.id/index.php/snj
- 31. Kahar F, Priyatno D, Meo BM. Study of erythrocyte index in patients with positive diagnosis of malaria. Journal of Sololipu Community Media Akad and Community Community. 2020; 20 (2):175-182
© 2023 The Author(s). Licensee IntechOpen. This chapter is distributed under the terms of the Creative Commons Attribution 3.0 License , which permits unrestricted use, distribution, and reproduction in any medium, provided the original work is properly cited.
Continue reading from the same book
Edited by Linda Eva Amoah
Published: 03 April 2024
By Jonas Bedford Danquah and Jennifer Afua Afrifa Yam...
275 downloads
By Fred Anangwe Amimo
107 downloads
By Emery Metelo, Josue Zanga, Doudou Batumbo, Bien-ai...
68 downloads
IntechOpen Author/Editor? To get your discount, log in .
Discounts available on purchase of multiple copies. View rates
Local taxes (VAT) are calculated in later steps, if applicable.
Support: [email protected]
A lightweight deep learning architecture for malaria parasite-type classification and life cycle stage detection
- Original Article
- Open access
- Published: 08 August 2024
Cite this article
You have full access to this open access article

- Hafiza Ayesha Hoor Chaudhry ORCID: orcid.org/0000-0001-5932-0103 1 ,
- Muhammad Shahid Farid 2 ,
- Attilio Fiandrotti 1 &
- Marco Grangetto 1
Malaria is an endemic in various tropical countries. The gold standard for disease detection is to examine the blood smears of patients by an expert medical professional to detect malaria parasite called Plasmodium . In the rural areas of underdeveloped countries, with limited infrastructure, a scarcity of healthcare professionals, an absence of sufficient computing devices, and a lack of widespread internet access, this task becomes more challenging. A severe case of malaria can be fatal within one week, so the correct detection of the malaria parasite and its life cycle stage is crucial in treating the disease correctly. Though computer vision-based malaria detection has been adequately explored lately, the malaria life cycle stage classification is still a relatively unexplored field. In this paper, we introduce a fast and robust deep learning methodology to not only classify the malaria parasite-type detection but also the life cycle stage identification of the infected cell. The proposed deep learning architecture is more than twenty times lighter than the widely used DenseNet and has less than 0.4 million parameters, making it a good candidate to be used in the mobile applications of such economically challenged states for malaria detection. We have used four different publicly available malaria datasets to test the proposed architecture and gained significantly better results than the current state of the art on malaria parasite-type and malaria life cycle classification.
Avoid common mistakes on your manuscript.
1 Introduction
Malaria is a fatal disease caused by the Plasmodium parasite. It is endemic in Pakistan, with 3.4 million suspected cases of malaria from January to August in year 2022. These numbers rose rapidly as compared with the 2.6 million cases reported in 2021, due to a surge of floods in the country, and are expected to rise again in 2023 [ 1 ]. Other regions with the highest outbreaks of malaria are sub-Saharan Africa, South-East Asia, Western Pacific, and Eastern Mediterranean [ 2 ]. Malaria has been labeled as the disease of poverty, resulting from lower socio-economic and hygiene circumstances [ 3 ].
The malaria parasite is introduced into the host’s body by a carrier mosquito and uses the red blood cells (RBCs) to carry out its life cycle. There are four types of malaria parasite known as Plasmodium (P.) falciparum , P. vivax , P. ovale , and P. malariae ; the first two are the most common [ 4 ]. These parasite types target RBCs of a specific age, i.e., malariae targets old RBCs, whereas vivax targets young RBCs [ 5 ]. These types also have different lifespans and maturing ages than each other; some types can lay dormant for weeks and even relapse after the first infection [ 6 ]. Hence, it is important to diagnose not only the infection but also the parasite type in infected cells. Each parasite type has four stages in its life cycle: gametocyte, ring, schizont, and trophozoite [ 7 ]. The correct diagnosis of the parasite life cycle stage is crucial for the proper treatment of this disease as various life cycle stages need more imminent care. Ring and trophozoite are the early stages of the parasite where the patients are mostly asymptotic (showing no symptoms of disease); hence, catching the disease at this stage ensures organ safety and patient survival chances [ 8 ]. However, there is little work done in classifying all the life cycle stages of the different types of malaria parasites as compared to the identification and detection of malaria parasite.
The standard malaria diagnosis method includes manually examining the blood slides under a microscope; if the parasite is found within red blood cells, then further investigation is done to detect the type, life cycle stage, and the total number of infected RBCs [ 9 ]. The accuracy of this method is directly dependent on the pathologists’ expertise and the available infrastructure. Examining hundreds of large samples can be time-consuming, and a shortage of skilled pathologists could result in a misdiagnosis, especially in the already overwhelmed medical centers in endemic flooded areas like Pakistan [ 10 ]. The test procedure is not only time-consuming but also expensive given the costs of man-hours being used for this task. Computer-aided diagnosis (CAD) systems can relieve this load to a great extent while ensuring a lesser error rate and faster results at a cheaper cost. Previously traditional image processing techniques have been used to detect the malaria parasite and its types depending upon the morphological features of cells and image intensity values [ 11 , 12 ]. Now there are more robust machine learning and deep learning architectures like convolutional neural networks (CNNs) that provide better results and are more preferred [ 13 ]. However, these deep learning architectures also require good-quality network coverage and hardware to function accurately. In countries facing economic disparities, where rural and remote areas encounter challenges in accessing reliable computer hardware and good internet connectivity, CAD systems cannot be incorporated due to their high computation cost. Thus, there is a need for a deep learning methodology that works with minimal computational cost, is lightweight to be embedded in mobile devices, and requires no internet or additional digital tools.
In this paper, we use deep learning to classify the various malaria parasite types and life cycle stages using a lightweight model that can be easily integrated into mobile applications for broad and enhanced user accessibility in remote and financially challenged areas. The main contributions and advantages of this paper are:
Introduction of a novel lightweight deep learning (DL) architecture to classify both malaria parasite type and life cycle stage.
Unlike most existing proposals which use multiple DL architecture pipelines for malaria classification and stage detection, e.g., [ 14 ], the proposed model is a single, lightweight architecture.
Ablation study and experiments conducted to show the proposed architecture give better results than the state of the art while being less computationally expensive.
2 Literature review
Several computer-aided diagnosis (CAD) systems have been developed for the classification of malaria parasites from the blood slide images [ 15 , 16 , 17 ]. These systems take blood slide images of patients as input and classify the blood cells as infected or not infected, also called the binary classification of malaria [ 18 ]. Most public malaria datasets also have only two labels, healthy and infected, along with the blood slide images [ 19 , 20 ].
The conventional classification of malaria includes using the morphological features of blood cells to identify the infected cells [ 21 ], along with improving the image acquisition method [ 22 ], and incorporating the image intensity information with the size of cells [ 23 ]. Some studies have altered full image color spaces to find the number of healthy and infected red blood cells [ 24 ], whereas color-based pixel discrimination has also been used for malaria cell detection [ 25 ]. The research in [ 26 ] uses histogram equalization and connected components to estimate the malaria parasite density. These traditional image processing methods are time-consuming and dependent on the features that vary between different datasets, e.g., intensity, prominent image color due to the staining technique used, etc. To further improve the results and speed up the process, machine learning and deep learning architectures were introduced as a much faster and more efficient alternative for the purpose of image classification.
The machine learning techniques range from using stacked CNNs for binary classification of malaria [ 27 ] to more sophisticated deep learning architectures for better accuracy [ 28 ]. Pre-trained neural networks along with optimization techniques have been used to achieve a higher accuracy in binary classification of malaria [ 29 , 30 ] and to automatically detect malaria parasite from the given blood slide images [ 19 ].
Moving toward the multiclass classification of malaria parasite types, a few datasets provide the multiclass labels for various types of malaria parasites [ 31 ] and the area is relatively less explored. Kassim et al. [ 32 ] have worked on classifying P. Falciparum and P. Vivax from thick smear images. Recently, new datasets have been published that include not only the type of malaria parasite with blood slides images but also have the multiclass labels for the life cycle stage, e.g., [ 14 ]. Their proposed method segments and classifies the malaria life cycle stage using deep learning architectures of pre-trained neural networks. Loddo et al. [ 33 ] also worked on a subset of [ 31 ] for the multiclass classification of life cycle stage using only the blood slide images of P. Falciparum malaria type. Several pre-trained networks were used, and DenseNet outperformed all the other networks for this task. Another malaria life cycle classifier is presented in [ 34 ] which classifies the malaria parasite using the ring, schizont, and trophozoite stages. Recent studies have used AlexNet and GoogleNet for the life cycle classification of Plasmodium parasite using data collected from the Hospital Universiti Sains Malaysia (HUSM). The GoogleNet Network and AlexNet showed an accuracy of 91.1% and 89.1% on test data respectively [ 35 ]. Another study used deep neural networks for the classification of the Plasmodium parasite into four known life cycle stages (ring, schizont, trophozoite, and gametocyte) where the Efficient Net B7 achieved an accuracy of 87.95% outperforming the other networks [ 36 ].
Most of the reviewed studies in this literature use traditional image processing techniques that are dependent on the features of a specific dataset and hence can’t be used on others. Some recent studies have, however, used deep learning models on a malaria dataset that is too small or on a subset of the existing malaria dataset, eliminating some classes of either the malaria parasite type or life cycle stage. Our study provides a comprehensive network that classifies all the common classes of malaria parasite type and life cycle stage classification. Moreover, the deep learning networks used in recent studies are computationally expensive to be embedded in the inferior quality hardware available in remote areas of lower economically developed countries. Furthermore, a huge literature gap exists due to the high imbalance between the amount of work done in binary classification versus the multiclass classification of malaria parasite type. This research not only fills this gap but also provides more insight into the life cycle stages of malaria-infected cells. This malaria life cycle stage detection is an important key in planning the correct treatment and dosage of medicine, and ultimately saving many lives. Besides, there is a need for a methodology that is robust and independent of the varying features between different datasets. We also cater to this issue by using various public datasets and validating our methodology on all those. The rest of the paper is organized as follows, the benchmark malaria datasets used for testing the proposed technique are introduced in Sect. 3 . Section 4 introduces the proposed methodology for malaria detection and classification. The experimental evaluations and discussion are presented in Sect. 5 , and conclusions are drawn in Sect. 6 .
In this section, we briefly introduce the benchmark malaria datasets MP-IDB, MP-IDB2, IML_Malaria, and Malaria-Detection-2019 that we used in our experiments and performance evaluations.
The MP-IDB [ 31 ] is a publicly available Footnote 1 malaria dataset collected at Centre Hospitalier Universitaire Vaudois (CHUV) using an optical laboratory microscope coupled with a built-in camera. There are a total of 229 full-slide blood images of four types of malaria parasites, P. falciparum , P. vivax , P. malariae , and P. ovale . These full-slide images have a resolution of \(2592 \times 1944\) and are stored in PNG format with 24-bit color depth. The sample images of MP-IDB full-slide blood images are presented in Fig. 1 .

Sample images from MP-IDB dataset: a Falciparum , b Vivax , c Ovale , and d Malariae
Each parasite type is further divided into four life cycle stages, called ring, schizont, trophozoite, and gametocyte. For the life cycle stages, cell crops of varying resolutions are provided in PNG format, this dataset is referred to as MP-IDB2. The same microscope is used for acquiring all the images but the images vary in terms of illumination, background uniformity, and image border overexposure. The sample images of cell crops are presented in Fig. 2 .

Sample images from MP-IDB2 dataset: a Falciparum Ring, b Falciparum Gametocyte, c Vivax Schizont, and d Vivax Trophozoite
3.2 IML_Malaria
The IML_Malaria [ 14 ] is a benchmark dataset for malaria life cycle classification in thin blood smear images containing Giesema-stained full blood slide images of the malaria parasite. The dataset was first published in 2021 and contains 345 microscopic images. The images have a resolution of \(1280 \times 960\) and are provided in a JPG format. An annotation file is also given along with the dataset that contains JSON arrays for each image. There are two keys for each JSON object, named as ‘image_name’ and ‘objects’. The objects array further has the ‘type’ of each cell visible on the image and its bounding box called ’bbox’. The types of blood cell range from ‘red blood cell’, ‘ring’, ‘schizont’, ‘trophozoite’, ‘gametocyte’, and ‘difficult’. The dataset is publicly available. Footnote 2 Sample images of this dataset are shown in Fig. 3 .

Sample images from IML_Malaria dataset: a ring, b schizont, c trophozoite, and d vivax trophozoite
3.3 Malaria-Detection-2019
The Malaria-Detection-2019 dataset [ 34 ] is publicly available. Footnote 3 It contains 883 Giesema-stained full blood slide images from the malaria parasite. The images have a resolution of \(1382 \times 1030\) in PNG format. The life cycle stage labels are provided along with the dataset. There are a total of eight labels for life cycle stages including early trophozoite (LR-ET), mid trophozoite (MT), ring (R), late ring, segmenter (Seg), early schizont (Esch), late schizont (Lsch), white blood cells (WBC), and debris. In their work [ 34 ], distinguishing between all eight stages was becoming very difficult, especially the early and late labels of each life cycle stage. Therefore, these eight stages were merged and finalized into three stages instead, ring, schizont, and trophozoite to increase the accuracy. We will also follow the same strategy in this research. A few images of these three stages are shown in Fig. 4 .
Sample images from Malaria-Detection-2019: a ring, b schizont, and c trophozoite
4 Methodology
Our multiclass malaria classification methodology is divided into two parts. Firstly, we classify the malaria parasite type using the MP-IDB dataset. Secondly, we classify the malaria parasite life cycle stage using MP-IDB, IML_Malarai, and Malaria-Detection-2019 datasets. In this section, we explain all the preprocessing steps taken to prepare the dataset for both of the multi-class classification tasks. We also introduce the proposed architecture and other compared models used in the experiments section and the parameters chosen for training the datasets. For both malaria parasite type and life cycle stage classification we have used the same training pipeline as shown in Fig. 7 . A pseudo-code of the proposed pipeline is also shown in Algorithm 1 for a better understanding of the process.
4.1 Preprocessing
All the datasets were randomly divided into training and testing sets with an 80:20 ratio. For both multi-class classification tasks, we normalize the images using mean and standard deviation. For the malaria parasite-type classification, we used the full-slide blood smear images as shown in the sample images of the previous section. Whereas, in the malaria life cycle stage classification, we cropped the IML_Malaria and Malaria-Detection-2019 datasets around the infected labeled cells using the location information provided in the annotation files of these datasets. As MP-IDB2 dataset with life cycle stage classification explained in section 3.1 was already provided in crops around the infected labeled cells. The images of all three datasets used for malaria life cycle stage classification (IML_Malaria, Malaria-Detection-2019, and MP-IDB2) become symmetrical. The sample images of crops obtained from these datasets can be seen in Fig. 5 .

Malaria life cycle stage crops obtained from parasite location anchors, a schizont, b gametocyte, c ring, and d trophozoite. Here a and b are derived from IML_Malaria dataset, and c and d are derived from the Malaria-Detection-2019 dataset
Due to the high imbalance of classes in most datasets, there was a high probability of the networks overfitting on the most represented classes in the training dataset. Hence several different augmentations were used to overcome this issue. The augmentations used in our study include random crop, random pad, and horizontal and vertical flips. These augmentations were applied independently for each batch with a probability of 0.5. After the augmentations, the input images (both full-slide images and crops) are resized to \(224\times 224\) for all the other architectures and \(299 \times 299\) for InceptionV3. These preprocessing and augmentation steps are also defined in line 3 of our methodology Algorithm 1. The images are then converted to tensors as a standard input format. The statistical details of all the datasets used in our study, including the total number of full-slide images, crop images, and augmented images, are presented in Table 1 .
4.2 Proposed architecture
We propose a less complicated yet efficient deep learning architecture for malaria-type classification and life cycle detection. The first layers of this network are the convolution layers and are translation invariant. Hence they can detect objects (cells in our case) even when the image is augmented. In our convolution layers, we have used a kernel size of \(3 \times 3\) as the smaller kernels have proved to be more efficient in grasping meaningful information. We have used five convolutional layers in our network followed by MaxPool and ReLu layers. The MaxPool layers further reduce the feature map dimensions and the activation function ReLu (Rectified Linear Unit) converts all negative values to zero while keeping the positive values unchanged. Afterward, we use a global average pooling (GAP) layer. Global average pooling (Eq. 1 ) down-samples the feature maps to a single average value, reducing the spatial dimensionality while saving the important information.
Here GAP(c) represents the average value of channel c , H and W stand for the height and width of the feature map, and the feature map F ( i , j , c ) gives the value at the location of (i,j) in channel c .
In our case, the input of the global average pool is \(256\times 7\times 7\) feature maps and it outputs an average of all 7 feature maps as \(256\times 1\times 1\) . This GAP layer is used to replace the fully connected layers and reduce the number of parameters. GAP layers also help in eliminating overfitting and are useful in cases where the dataset is small. Lastly, the feature maps are flattened and passed to a linear layer to be classified into the four class labels. The proposed architecture is shown pictorially in Fig. 6 .

Proposed malaria classification and life cycle detection architecture

Proposed malaria classification and life cycle detection pipeline
We also used several deep learning architectures and conducted numerous experiments using the pre-trained networks already available in PyTorch [ 37 ], including ResNet18 [ 38 ], Densenet121 [ 39 ], Alexnet [ 40 ], Squeezenet [ 41 ], VGG11 [ 42 ], and Inceptionv3 [ 43 ]. Details of these architectures and the proposed model are given in Table 7 . It can be noted that the proposed model has the least number of trainable parameters, making it three times lighter than SqueezeNet and twenty times lighter than DenseNet. Having less than 0.4 million parameters, this network becomes the optimal lightweight network to be deployed in mobile applications and computer-aided diagnosis systems.

Algorithm for malaria classification
4.3 Training
Initially, we used the architectures mentioned in the above section with two different optimizers for training over the multiclass classification of malaria parasite type, called stochastic gradient descent (SGD) and adaptive moment estimation (Adam). The Adam optimizer gave us better results so we used it in the multiclass classification of malaria life cycle stage as well. The LR of 0.001 was used with a Scheduler of step size=1. For the loss calculation, we used cross-entropy loss. It is particularly useful for unbalanced classes and works with non-normalized logits as input for each class. For both malaria parasite type and life cycle stage classification, this training and testing describes the steps in second half of our pipeline, as shown in Fig. 7 . However, the output label classes may vary depending on the dataset used.
All the training was done for 100 epochs and different metrics were computed to gauge the model’s performance. A test can result in one of four possible outcomes: true positive (TP), false positive (FP), true negative (TN), and false negative (FN). A TP occurs when the model correctly predicts the presence of malaria parasites, aligning with the actual positive label. Conversely, an FP happens when the model incorrectly predicts the presence of parasites in an image labeled as negative. This might lead to a misdiagnosis, indicating parasites where there are none. On the other side, a TN signifies the correct identification of an absence of parasites in an image labeled as negative. Finally, an FN occurs when the model fails to detect parasites in an image labeled as positive. We use accuracy, precision, sensitivity, and F1-score to evaluate the performance of the classifiers.
Accuracy is a common metric used to evaluate the overall performance of a classification model. It is defined as the ratio of correctly predicted instances (both true positives and true negatives) to the total number of instances in the dataset.
The sensitivity is the rate of true positive, in disease detection a positive refers to the patient having that disease. So, the sensitivity (aka recall) is the model’s ability to correctly diagnose an ill patient as such.
Precision measures the accuracy of the positive predictions made by the model.
The F1-score is a valuable metric in image classification problems because it considers both false positives and false negatives, providing a balanced assessment of a model’s performance, particularly in situations with imbalanced datasets.
5 Results and discussion
The first part of our methodology, multiclass classification of malaria parasite type uses the MP-IDB dataset mentioned in sect. 3.1 . After training for 100 epochs using the proposed architecture, we checked the classification accuracy on the test set. The multiclass classification of malaria parasite type reached an average accuracy of 99%. The individual precision, sensitivity, and F1-scores of each four classes along with the index (count frequency) of each class are shown in Table 2 . The confusion matrix of each class is also represented separately in Fig. 8 . It is worth noting that only one image is misclassified over the entire dataset.

Multi-class classification confusion matrix of the proposed algorithm malaria parasite-type classification on MP-IDB dataset
The second part of our methodology corresponds to the multi-class classification of malaria life cycle stages. The proposed architecture is also trained and tested on the cell images of the MP-IDB dataset with the life cycle stage labels. The test set achieves an overall accuracy of 96% for the four mentioned life cycle stages. The indexes of all the classes, along with their individual precision sensitivity and F1-scores, are presented in Table 3 . Furthermore, Fig. 9 shows the confusion matrices for this classification. These statistics show a low F1-score for the Trophozoite class. It is because this dataset is highly unbalanced as the Trophozoite and Gametocyte classes are severely under-represented. It is also worth mentioning here that current state of the art, e.g., Loddo et al. [ 33 ] only considered the falciparum class, we contrastingly include all the dataset cell images instead of using only the life cycle stages of the falciparum class.

Multi-class classification confusion matrix of the proposed algorithm on MP-IDB2 dataset
The second dataset we used in our multiclass classification of the malaria life cycle stage is IML_Malaria. This dataset has four balanced life cycle stages. We used the proposed network initialized from scratch for training on this dataset. Due to the balanced nature of the dataset, the individual scores of each class are better, with an overall accuracy of 92%. Table 4 refers to the individual scores of each class using all four performance parameters. The corresponding confusion matrices are shown in Fig. 10 .

Multi-class classification confusion matrix of the proposed algorithm on IML_Malaria dataset
Lastly, we used the Malaria-Detection-2019 dataset. The given eight life stage classes are merged to make three final classes, called ring, schizont, and trophozoite. The overall accuracy achieved by our proposed network is 82%, which is comparable to Abbas et al. [ 34 ]. Although Abbas et al. [ 34 ] collected and used 112 features along with random forests to classify this dataset, the tailored collection of features is highly dependent upon the dataset and can vary when applied to other datasets. Hence our methodology is more robust and generalizable. The individual scores of each class are mentioned in Table 5 , and the corresponding confusion matrices are shown in Fig. 11 .

Multi-class classification confusion matrix of the proposed algorithm on Malaria-Detection-2019 dataset
In Table 6 , we provide a performance comparison between the proposed method and the state-of-the-art representative method for each dataset. On malaria-type classification problems, the proposed method achieves 99% compared to 91% of Yang [ 44 ]. On life cycle stage detection, the proposed method outperforms the Arshad [ 14 ] method by significant margins and gives comparable results to Abbas [ 34 ] without any tailored collection of features. The performance of the proposed method on MP-IDB2 is also appreciable as it achieves 96% accuracy on the entire dataset when compared to Luddo [ 33 ] which achieved 99% accuracy but only for falciparum class of the dataset.
All the results acquired using our novel deep learning approach beat the previous state-of-the-art results by a clear margin. The convolution layers in our network focus on the vital information present in the input images and the GAP layer averages this information while preserving the spatial dimension. Due to the combination of these layers, our network is able to provide better results in a cost-efficient manner while avoiding overfitting. The state-of-the-art deep learning architectures rely on large datasets to learn better and give optimal results. In this problem, as the datasets are small, these deep learning architectures overfit and gave better results than our architecture on the training set images but worse on the test set. The comparison between the previous state of the art and our results is presented in Table 7 . Our proposed architecture gives better accuracy results than ResNet (the closest competitor) on MP-IDB dataset, with six times lower Flops (floating point operations per second) and 13% faster inference time proving that our architecture is more cost and time-efficient.
Furthermore, as these datasets are highly unbalanced the state-of-the-art architectures only gave good results for the most represented classes, i.e., falciparum and vivax in the malaria parasite type, and ring in the malaria life cycle stage. On the other hand, as seen in the confusion matrices, our proposed architecture emphasizes the under-represented classes and gives better precision and sensitivity values for them as compared to the other architectures. This trait makes our architecture the most suitable candidate for the unbalanced healthcare and medical datasets.
5.1 Ablation study
The main motive of this research is to propose a lightweight deep learning model that gives optimal results for the multiclass classification of malaria. To this end, we trained the proposed method on two different input resolutions, \(224\times 224\) and \(112\times 112\) . The number of parameters for both input resolutions is the same, i.e., 393K, but the main measure of difference is floating point operations per second (FLOPS). FLOPS play an integral part in measuring the complexity of a deep learning model, as a higher number of FLOPS leads to more training time and slower inference speed. To save computational resources while maintaining a high accuracy score is an active research field in deep learning. In our experiments, we observed that the lower-resolution input image decreases the FLOPS considerably and is computationally more cost-effective. We present the results of this ablation in Table 8 .
The image input resolution of \(224\times 224\) achieved the highest accuracy scores for all datasets. However, by reducing this input resolution to \(112\times 112\) , the FLOPS decrease by four times. This reduction in computational complexity is achieved by trading off only 2 to 3% average accuracy.
6 Conclusion
In this paper, we have presented a lightweight technique for multiclass classification of malaria parasite type and life cycle stage. Our proposed architecture achieves better results than the state of the art on four benchmark malaria datasets. It also focuses on the classes with low counts, making it an ideal choice for unbalanced datasets. Moreover, our architecture is light enough to be embedded in mobile applications which will be very beneficial for the understaffed hospitals of the developing countries that lack advanced computer tools to support heavy deep learning models. To the best of our knowledge, this is the most vast and diverse study conducted for both multiclass malaria parasite type and life cycle stage classification on different datasets using a novel cost-efficient model. However, it can be observed from the results that the proposed life cycle classification approach struggles to achieve the desired accuracy in the Schizont and Trophozoite stages. From the initial investigations, we observed that the reasons for this limiting performance are the limited or biased dataset which results in restricted learning of the model. Furthermore, these two types appear visually similar, particularly under low-resolution imaging systems and the model fails to distinguish them. We believe that this limitation can be overcome if a sufficient dataset for training is available. In future, we would like to add more balanced datasets to our experiments to eliminate any accidental bias and embed our architecture in mobile applications and CAD systems.
Data availability
All the data used in our study are publicly available and referenced in their relevant sections.
https://github.com/andrealoddo/MP-IDB-The-Malaria-Parasite-Image-Database-for-Image-Processing-and-Analysis .
https://github.com/QaziAmmar/A-dataset-and-benchmark-for-malaria-life-cycle-classification-in-thin-blood-smear-images .
https://data.mendeley.com/datasets/5bf2kmwvfn/1 .
World Health Organization (2022) World malaria report 2022. World Health Organization
World Health Organization (2022) Malaria - Pakistan. https://www.who.int/emergencies/disease-outbreak-news/item/2022-DON413 , [Online; accessed 07-July-2023]
Wafula ST, Habermann T, Franke MA et al (2023) What are the pathways between poverty and malaria in sub-saharan africa? A systematic review of mediation studies. Infect Dis Poverty 12(03):13–30. https://doi.org/10.1186/s40249-023-01110-2
Article Google Scholar
Price RN, Commons RJ, Battle KE et al (2020) Plasmodium vivax in the era of the shrinking P. falciparum map. Trends Parasitol 36(6):560–570. https://doi.org/10.1016/j.pt.2020.03.009
Neveu G, Lavazec C (2021) Erythroid cells and malaria parasites: it’s a match! Curr Opin Hematol 28(3):158–63
Bousema T, Drakeley C (2011) Epidemiology and infectivity of plasmodium falciparum and plasmodium vivax gametocytes in relation to malaria control and elimination. Clin Microbiol Rev 24(2):377–410. https://doi.org/10.1128/cmr.00051-10
Adegoke JA, Raper H, Gassner C et al (2022) Visible microspectrophotometry coupled with machine learning to discriminate the erythrocytic life cycle stages of P. falciparum malaria parasites in functional single cells. Analyst 147:2662–2670. https://doi.org/10.1039/D2AN00274D
Kochan K, Bedolla DE, Perez-Guaita D et al (2021) Infrared spectroscopy of blood. Appl Spectrosc 75(6):611–646
White NJ (2022) Severe malaria. Malar J 21(1):284. https://doi.org/10.1186/s12936-022-04301-8
Mohammed HA, Abdelrahman IAM (2017) Detection and classification of malaria in thin blood slide images. In: 2017 international conference on communication, control, computing and electronics engineering (ICCCCEE), IEEE, pp 1–5, https://doi.org/10.1109/ICCCCEE.2017.7866700
Komagal E, Kumar K, Vigneswaran A (2013) Recognition and classification of malaria plasmodium diagnosis. Int J Eng Res Technol 2(1):1–4
Google Scholar
Punitha S, Logeshwari P, Sivaranjani P et al (2017) Detection of malarial parasite in blood using image processing. Asian J Appl Sci Technol 1(2):211–213
Razzak MI (2015) Automatic detection and classification of malarial parasite. Int J Biom Bioinform (IJBB) 9(1):1–12
Arshad QA, Ali M, Hassan SU et al (2021) A dataset and benchmark for malaria life-cycle classification in thin blood smear images. Neural Comput Appl 34(6):4473–4485. https://doi.org/10.1007/s00521-021-06602-6
Liang Z, Powell A, Ersoy I, et al (2016) Cnn-based image analysis for malaria diagnosis. In: 2016 IEEE international conference on bioinformatics and biomedicine (BIBM), IEEE, pp 493–496
Pan WD, Dong Y, Wu D (2018) Classification of malaria-infected cells using deep convolutional neural networks, vol 159, IntechOpen
Fatima T, Farid MS (2019) Automatic detection of plasmodium parasites from microscopic blood images. J Parasit Dis 44(1):69–78. https://doi.org/10.1007/s12639-019-01163-x
Rahman A, Zunair H, Rahman MS, et al (2019) Improving malaria parasite detection from red blood cell using deep convolutional neural networks. arXiv preprint arXiv:1907.10418 arXiv:1907.10418 [eess.IV]
Rajaraman S, Antani SK, Poostchi M et al (2018) Pre-trained convolutional neural networks as feature extractors toward improved malaria parasite detection in thin blood smear images. PeerJ 6:e4568
Quinn JA, Nakasi R, Mugagga PKB, et al (2016) Deep convolutional neural networks for microscopy-based point of care diagnostics. In: Doshi-Velez F, Fackler J, Kale D, et al (eds) Proceedings of the 1st Machine Learning for Healthcare Conference, Proceedings of Machine Learning Research, vol 56. PMLR, Northeastern University, Boston, MA, USA, pp 271–281, https://proceedings.mlr.press/v56/Quinn16.html
Savkare S, Narote S (2015) Automated system for malaria parasite identification. In: 2015 international conference on communication, information & computing technology (ICCICT), IEEE, pp 1–4
Fn KT, Daniel T, Pierre E et al (2016) Automated diagnosis of malaria in tropical areas using 40x microscopic images of blood smears. Int J Biom Bioinforma 10(2):12
Kareem S, Kale I, Morling RC (2012) Automated malaria parasite detection in thin blood films:-a hybrid illumination and color constancy insensitive, morphological approach. In: 2012 IEEE Asia Pacific Conference on Circuits and Systems, IEEE, pp 240–243, https://doi.org/10.1109/APCCAS.2012.6419016
May Z, Mohd Aziz SSA, Salamat R (2013) Automated quantification and classification of malaria parasites in thin blood smears. In: 2013 IEEE International Conference on Signal and Image Processing Applications, pp 369–373, https://doi.org/10.1109/ICSIPA.2013.6708035
Roy K, Sharmin S, Mukta RM et al (2018) Detection of malaria parasite in giemsa blood sample using image processing. Int J Comput Sci Inform Technol 10(1):55–65
Arco J, Górriz J, Ramírez J et al (2015) Digital image analysis for automatic enumeration of malaria parasites using morphological operations. Expert Syst Appl 42(6):3041–3047
Umer M, Sadiq S, Ahmad M et al (2020) A novel stacked cnn for malarial parasite detection in thin blood smear images. IEEE Access 8:93782–93792. https://doi.org/10.1109/ACCESS.2020.2994810
Gautam K, Jangir SK, Kumar M, et al (2020) Malaria detection system using convolutional neural network algorithm. In: Machine learning and deep learning in real-time applications. IGI Global, p 219–230. https://doi.org/10.4018/978-1-7998-3095-5.ch010
Maqsood A, Farid MS, Khan MH et al (2021) Deep malaria parasite detection in thin blood smear microscopic images. Appl Sci 11(5):2284. https://doi.org/10.3390/app11052284
Imran T, Khan MA, Sharif M et al (2022) Malaria blood smear classification using deep learning and best features selection. Computers, Materials Continua. 70(1):1875–1891. https://doi.org/10.32604/cmc.2022.018946
Loddo A, Di Ruberto C, Kocher M, et al (2019) MP-IDB: the malaria parasite image database for image processing and analysis. In: Processing and Analysis of Biomedical Information: First International SIPAIM Workshop, SaMBa 2018, Held in Conjunction with MICCAI 2018, Granada, Spain, September 20, 2018, Revised Selected Papers 1, Springer, pp 57–65
Kassim YM, Yang F, Yu H et al (2021) Diagnosing malaria patients with plasmodium falciparum and vivax using deep learning for thick smear images. Diagnostics 11(11):1994. https://doi.org/10.3390/diagnostics11111994
Loddo A, Fadda C, Di Ruberto C (2022) An empirical evaluation of convolutional networks for malaria diagnosis. J Imaging 8(3):66
Abbas SS, Dijkstra TMH (2020) Detection and stage classification of plasmodium falciparum from images of giemsa stained thin blood films using random forest classifiers. Diagn Pathol 15(1):130. https://doi.org/10.1186/s13000-020-01040-9
Azhar MS, Mashor MY, Kanafiah A, et al (2023) Development of life cycle classification system for plasmodium knowlesi malaria species using deep learning. In: AIP Conference Proceedings, AIP Publishing
Araujo F, Colares N, Carvalho U, et al (2023) Plasmodium life cycle-stage classification on thick blood smear microscopy images using deep learning: A contribution to malaria diagnosis. In: 2023 19th International Symposium on Medical Information Processing and Analysis (SIPAIM), IEEE, pp 1–4
Paszke A, Gross S, Massa F, et al (2019) Pytorch: An imperative style, high-performance deep learning library. In: Wallach H, Larochelle H, Beygelzimer A, et al (eds) Advances in Neural Information Processing Systems, vol 32. Curran Associates, Inc., https://proceedings.neurips.cc/paper_files/paper/2019/file/bdbca288fee7f92f2bfa9f7012727740-Paper.pdf
He K, Zhang X, Ren S, et al (2016) Deep residual learning for image recognition. In: Proceedings of the IEEE conference on computer vision and pattern recognition. (CVPR), pp 770–778, https://doi.org/10.1109/CVPR.2016.90
Huang G, Liu Z, Maaten LVD, et al (2017) Densely connected convolutional networks. In: Proceedings of the IEEE conference on computer vision and pattern recognition. (CVPR). IEEE Computer Society, Los Alamitos, CA, USA, pp 2261–2269, https://doi.org/10.1109/CVPR.2017.243 ,
Krizhevsky A, Sutskever I, Hinton GE (2017) Imagenet classification with deep convolutional neural networks. Commun ACM 60(6):84–90. https://doi.org/10.1145/3065386
Iandola FN, Han S, Moskewicz MW, et al (2016) Squeezenet: Alexnet-level accuracy with 50x fewer parameters and<1mb model size. arXiv preprint arXiv:1602.07360
Simonyan K, Zisserman A (2014) Very deep convolutional networks for large-scale image recognition. arXiv preprint arXiv:1409.1556
Szegedy C, Vanhoucke V, Ioffe S, et al (2016) Rethinking the inception architecture for computer vision. In: Proc. IEEE Conf. Comput. Vis. Pattern Recognit. (CVPR), pp 2818–2826, https://doi.org/10.1109/CVPR.2016.308
Yang Z, Benhabiles H, Hammoudi K et al (2022) A generalized deep learning-based framework for assistance to the human malaria diagnosis from microscopic images. Neural Comput Appl 34(17):14223–14238. https://doi.org/10.1007/s00521-021-06604-4
Download references
Open access funding provided by Università degli Studi di Torino within the CRUI-CARE Agreement.
Author information
Authors and affiliations.
Department of Computer Science, University of Turin, Torino, 10149, Italy
Hafiza Ayesha Hoor Chaudhry, Attilio Fiandrotti & Marco Grangetto
Department of Computer Science, University of the Punjab, Lahore, 54590, Pakistan
Muhammad Shahid Farid
You can also search for this author in PubMed Google Scholar
Corresponding author
Correspondence to Hafiza Ayesha Hoor Chaudhry .
Ethics declarations
Conflict of interest.
No conflict of interest or funding to declare.
Additional information
Publisher's note.
Springer Nature remains neutral with regard to jurisdictional claims in published maps and institutional affiliations.
Rights and permissions
Open Access This article is licensed under a Creative Commons Attribution 4.0 International License, which permits use, sharing, adaptation, distribution and reproduction in any medium or format, as long as you give appropriate credit to the original author(s) and the source, provide a link to the Creative Commons licence, and indicate if changes were made. The images or other third party material in this article are included in the article's Creative Commons licence, unless indicated otherwise in a credit line to the material. If material is not included in the article's Creative Commons licence and your intended use is not permitted by statutory regulation or exceeds the permitted use, you will need to obtain permission directly from the copyright holder. To view a copy of this licence, visit http://creativecommons.org/licenses/by/4.0/ .
Reprints and permissions
About this article
Chaudhry, H.A.H., Farid, M.S., Fiandrotti, A. et al. A lightweight deep learning architecture for malaria parasite-type classification and life cycle stage detection. Neural Comput & Applic (2024). https://doi.org/10.1007/s00521-024-10219-w
Download citation
Received : 14 December 2023
Accepted : 12 July 2024
Published : 08 August 2024
DOI : https://doi.org/10.1007/s00521-024-10219-w
Share this article
Anyone you share the following link with will be able to read this content:
Sorry, a shareable link is not currently available for this article.
Provided by the Springer Nature SharedIt content-sharing initiative
- Medical image classification
- Deep learning
- Malaria detection
- Malaria life cycle stage classification
- Find a journal
- Publish with us
- Track your research
- Environment
- Science & Technology
- Business & Industry
- Health & Public Welfare
- Topics (CFR Indexing Terms)
- Public Inspection
- Presidential Documents
- Document Search
- Advanced Document Search
- Public Inspection Search
- Reader Aids Home
- Office of the Federal Register Announcements
- Using FederalRegister.Gov
- Understanding the Federal Register
- Recent Site Updates
- Federal Register & CFR Statistics
- Videos & Tutorials
- Developer Resources
- Government Policy and OFR Procedures
- Congressional Review
- My Clipboard
- My Comments
- My Subscriptions
- Sign In / Sign Up
- Site Feedback
- Search the Federal Register
This site displays a prototype of a “Web 2.0” version of the daily Federal Register. It is not an official legal edition of the Federal Register, and does not replace the official print version or the official electronic version on GPO’s govinfo.gov.
The documents posted on this site are XML renditions of published Federal Register documents. Each document posted on the site includes a link to the corresponding official PDF file on govinfo.gov. This prototype edition of the daily Federal Register on FederalRegister.gov will remain an unofficial informational resource until the Administrative Committee of the Federal Register (ACFR) issues a regulation granting it official legal status. For complete information about, and access to, our official publications and services, go to About the Federal Register on NARA's archives.gov.
The OFR/GPO partnership is committed to presenting accurate and reliable regulatory information on FederalRegister.gov with the objective of establishing the XML-based Federal Register as an ACFR-sanctioned publication in the future. While every effort has been made to ensure that the material on FederalRegister.gov is accurately displayed, consistent with the official SGML-based PDF version on govinfo.gov, those relying on it for legal research should verify their results against an official edition of the Federal Register. Until the ACFR grants it official status, the XML rendition of the daily Federal Register on FederalRegister.gov does not provide legal notice to the public or judicial notice to the courts.
Design Updates: As part of our ongoing effort to make FederalRegister.gov more accessible and easier to use we've enlarged the space available to the document content and moved all document related data into the utility bar on the left of the document. Read more in our feature announcement .

Guidelines for the Use of Doxycycline Post-Exposure Prophylaxis for Bacterial Sexually Transmitted Infection (STI) Prevention; Request for Comment and Informational Presentation
A Notice by the Centers for Disease Control and Prevention on 10/02/2023
This document has been published in the Federal Register . Use the PDF linked in the document sidebar for the official electronic format.
- Document Details Published Content - Document Details Agencies Department of Health and Human Services Centers for Disease Control and Prevention Agency/Docket Number Docket No. CDC-2023-0080 Document Citation 88 FR 67754 Document Number 2023-21725 Document Type Notice Pages 67754-67755 (2 pages) Publication Date 10/02/2023 Published Content - Document Details
- View printed version (PDF)
- Document Dates Published Content - Document Dates Comments Close 11/16/2023 Dates Text Written comments must be received on or before November 16, 2023. An Informational Presentation has been pre-recorded and is available at https://npin.cdc.gov/ . Published Content - Document Dates
This table of contents is a navigational tool, processed from the headings within the legal text of Federal Register documents. This repetition of headings to form internal navigation links has no substantive legal effect.
FOR FURTHER INFORMATION CONTACT:
Supplementary information:, public participation.
Comments are no longer being accepted. See DATES for details.
Additional information is not currently available for this document.
- Sharing Enhanced Content - Sharing Shorter Document URL https://www.federalregister.gov/d/2023-21725 Email Email this document to a friend Enhanced Content - Sharing
- Print this document
Document page views are updated periodically throughout the day and are cumulative counts for this document. Counts are subject to sampling, reprocessing and revision (up or down) throughout the day.
This document is also available in the following formats:
More information and documentation can be found in our developer tools pages .
This PDF is the current document as it appeared on Public Inspection on 09/29/2023 at 8:45 am.
It was viewed 121 times while on Public Inspection.
If you are using public inspection listings for legal research, you should verify the contents of the documents against a final, official edition of the Federal Register. Only official editions of the Federal Register provide legal notice of publication to the public and judicial notice to the courts under 44 U.S.C. 1503 & 1507 . Learn more here .
Document headings vary by document type but may contain the following:
- the agency or agencies that issued and signed a document
- the number of the CFR title and the number of each part the document amends, proposes to amend, or is directly related to
- the agency docket number / agency internal file number
- the RIN which identifies each regulatory action listed in the Unified Agenda of Federal Regulatory and Deregulatory Actions
See the Document Drafting Handbook for more details.
Department of Health and Human Services
Centers for disease control and prevention.
- [Docket No. CDC-2023-0080]
Centers for Disease Control and Prevention (CDC), Department of Health and Human Services (HHS).
Notice with comment period.
The Centers for Disease Control and Prevention (CDC) in the Department of Health and Human Services (HHS) announces the opening of a docket to obtain comment on proposed guidelines for the use of doxycycline post-exposure prophylaxis (PEP) for prevention of bacterial sexually transmitted infections (STI). The proposed guidelines for bacterial STI prevention include post-exposure prophylaxis with doxycycline (doxycycline PEP) because it has demonstrated benefit in reducing chlamydia, gonorrhea, and syphilis infections and represents a new approach to addressing STI prevention in populations at increased risk for these infections. Doxycycline PEP, when offered, should be implemented in the context of a comprehensive sexual health approach including risk reduction counseling, STI screening and treatment, recommended vaccination, and linkage to HIV pre-exposure prophylaxis (PrEP), HIV care, or other services, as appropriate. The purpose of the proposed guidelines is to provide updated clinical guidance for healthcare providers to inform the use of doxycycline PEP for preventing bacterial STI infections. CDC has made available a pre-recorded informational presentation to provide information about the studies considered when developing the proposed guideline, explain the public comment process, and provide an overview of important monitoring for antibiotic use and antibiotic resistance that the agency will be considering to address potential risks.
Written comments must be received on or before November 16, 2023. An Informational Presentation has been pre-recorded and is available at https://npin.cdc.gov/ .
You may submit comments, identified by Docket No. CDC-2023-0080 by either of the methods listed below. Do not submit comments by email. CDC does not accept comments by email.
- Federal eRulemaking Portal: http://www.regulations.gov . Follow the instructions for submitting comments.
- Mail: [Division of STD Prevention, Centers for Disease Control and Prevention, 1600 Clifton Road NE, Mailstop US12-2, Atlanta, GA 30329, Attn: Docket No. CDC-2023-0080].
Instructions: All submissions received must include the agency name and Docket Number. All relevant comments received will be posted without change to http://regulations.gov , including any personal information provided. For access to the docket to read background documents or comments received, go to http://www.regulations.gov .
The informational presentation can be accessed at https://npin.cdc.gov/ .
John R. Papp, Centers for Disease Control and Prevention, 1600 Clifton Road NE, Mailstop U12-3, Atlanta, GA 30329; Telephone: 404-639-8000; Email: [email protected] .
CDC's proposed guidelines for the use of post-exposure prophylaxis with doxycycline for bacterial STI prevention in the United States is available under the Supporting and Related Materials tab in the docket for this notice, Docket No. CDC-2023-0080, on http://www.regulations.gov .
Interested persons or organizations are invited to participate by submitting written views, recommendations, and data. In addition, CDC invites comments specifically on the following questions proposed in this Notice:
- Based on the evidence presented in the full guidelines document (see the Supporting and Related Materials tab in the docket), does the evidence support the proposed guidelines for the use of post-exposure prophylaxis with doxycycline for bacterial STI prevention, including but not limited to risks and benefits? If not, please state the reason why and, if available, provide additional evidence for consideration.
- Are CDC's proposed guidelines for the use of post-exposure prophylaxis with doxycycline bacterial STI prevention clearly written? If not, what changes do you propose to make it clear?
- If implemented as currently drafted, do you believe the proposed guidelines for the use of post-exposure prophylaxis with doxycycline for bacterial STI prevention would result in improved prevention of bacterial STIs in the United States? If not, please provide an explanation and supporting data or evidence.
- How can these proposed guidelines most effectively reach and be received by populations who would benefit from this intervention?
Please note that comments received, including attachments and other supporting materials, are part of the public record and are subject to public disclosure. Comments will be posted on https://www.regulations.gov . Therefore, do not include any information in your comment or supporting materials that you consider confidential or inappropriate for public disclosure. If you include your name, contact information, or other information that identifies you in the body of your comments, that information will be on public display. CDC will review all submissions and may choose to redact, or withhold, submissions containing private or proprietary information such as Social Security numbers, medical information, inappropriate language, or duplicate/near duplicate examples of a mass-mail campaign.
Incidence of sexually transmitted infections (STIs) caused by Neisseria gonorrhoeae (causative agent of gonorrhea), Chlamydia trachomatis (causative agent of chlamydia), and Treponema pallidum (causative agent of syphilis) continues to increase in the United States. Novel approaches are needed to address the STI epidemic, especially for populations disproportionately affected (1). Post-exposure prophylaxis (PEP) involves taking a medication to prevent an infection after a possible exposure and is a common strategy for prevention of HIV and other infections. PEP is a form of chemoprophylaxis and distinct from pre-exposure prophylaxis (PrEP) which involves taking a medication before exposure occurs. Doxycycline, a broad-spectrum tetracycline antibiotic, is used as pre- or post-exposure prophylaxis to prevent infections such as malaria and Lyme disease (2). Doxycycline is well absorbed and tolerated, with a half-life of approximately 12 hours (3). Adverse effects most associated with doxycycline are photosensitivity and gastrointestinal symptoms including esophageal erosion and ulceration (4). Most adverse effects resolve when the medication is stopped. Doxycycline is the recommended treatment regimen for chlamydia and an alternative treatment for syphilis in non-pregnant patients with severe penicillin allergy or when penicillin is not available (5).
The 2021 CDC STI Treatment Guidelines included a systematic review of the available literature on STI PEP and concluded that further studies were necessary to determine whether it would be an effective strategy for bacterial STI prevention (5). Since that time, promising results from several randomized trials on doxycycline PEP indicated the need to re-address this topic (6, 7). The new guidelines will offer an important resource for healthcare providers to inform the use of doxycycline PEP for preventing bacterial STI infections. CDC plans to use multiple surveillance systems to monitor impacts of the proposed guidelines including potential impacts on antibiotic use and antibiotic resistance in both STI and non-STI pathogens.
All comments received will be carefully reviewed and considered. The proposed guidelines are also undergoing peer review. All comments will be addressed in the final guidelines and the proposed guidelines will be revised as appropriate. CDC will publish another notice announcing the availability of the final guidelines.
1. STI National Strategic Plan, 2021-2025 [internet]. Available from: www.hhs.gov/programs/topic-sites/sexually-transmitted-infections/plan-overview/index.html .
2. Nadelman RB, Nowakowski J, Fish D, Falco RC, Freeman K, McKenna D, et al. Prophylaxis with single-dose doxycycline for the prevention of Lyme disease after an Ixodes scapularis tick bite. N Engl J Med. 2001 Jul 12;345(2):79-84.
3. Peyriere H, Makinson A, Marchandin H, Reynes J. Doxycycline in the management of sexually transmitted infections. J Antimicrob Chemother. 2018 Mar 1;73(3):553-63.
4. Sloan B, Scheinfeld N. The use and safety of doxycycline hyclate and other second-generation tetracyclines. Expert Opin Drug Saf. 2008 Sep;7(5):571-7.
5. Workowski K, Bachmann L, Chan P, Johnston C, Muzny C, Park I, et al. Sexually Transmitted Infections Treatment Guidelines, 2021. MMWR. 2021; 70:1-187.
6. Luetkemeyer AF, Donnell D, Dombrowski JC, Cohen S, Grabow C, Brown CE, et al. Postexposure Doxycycline to Prevent Bacterial Sexually Transmitted Infections. N Engl J Med. 2023 Apr 6;388(14):1296-306.
7. Jean-Michel Molina, Beatrice Bercot, Lambert Assoumou, Algarte-Genin Michele, Emma Rubenstein, Gilles Pialoux, et al. ANRS 174 DOXYVAC: An Open-Label Randomized Trial to Prevent STIs in MSM on PrEP. CROI [internet]. 2023 Feb 19; Seattle, Washington. Available from: https://www.croiconference.org/abstract/anrs-174-doxyvac-an-open-label-randomized-trial-to-prevent-stis-in-msm-on-prep/ .
Dated: September 27, 2023.
Kathryn L. Wolff,
Chief of Staff, Centers for Disease Control and Prevention.
[ FR Doc. 2023-21725 Filed 9-29-23; 8:45 am]
BILLING CODE 4163-18-P
- Executive Orders
Reader Aids
Information.
- About This Site
- Legal Status
- Accessibility
- No Fear Act
- Continuity Information
Disclaimer: Early release articles are not considered as final versions. Any changes will be reflected in the online version in the month the article is officially released.
Volume 30, Number 9—September 2024
Research Letter
Powassan virus encephalitis after tick bite, manitoba, canada.
Suggested citation for this article
A case of Powassan encephalitis occurred in Manitoba, Canada, after the bite of a black-legged tick. Awareness of this emerging tickborne illness is needed because the number of vector tick species is growing. No specific treatment options exist, and cases with illness and death are high. Prevention is crucial.

Figure . Black-legged tick ( Ixodes scapularis ) after removal with tweezers from a patient in Manitoba, Canada, who was later diagnosed with Powassan virus.
On October 2, 2022, a 60-year-old male hobbyist outdoor photographer in southern Manitoba, Canada, noticed a black-legged tick ( Ixodes scapularis ) attached to his neck ( Figure ). The patient sought treatment for possible Lyme disease and was prescribed doxycycline.
On October 16, 2 weeks after the tick bite, the patient had complaints of diarrhea, nausea, and malaise. He also had a fever that reached 40°C (104°F), a 10–15-pound weight loss, difficulty concentrating, and a bilateral headache, and he became bedbound from weakness and ataxia. He was admitted to a hospital in Winnipeg, Manitoba on November 1. He had a history of hypertension for which he was taking ramipril and right arm thrombosis for which he was taking apixaban.
The patient complained of radicular pain in his arms and legs requiring opioids. He recalled no recent travel, immunizations, or mosquito bites. Physical examination revealed tachycardia, confusion, dysarthria, and difficulty following commands. He did not have fever, rash, or nuchal rigidity. A neurologic examination demonstrated a bilateral intention tremor, twitching, dysmetria, and ataxia.
Laboratory testing of the patient’s blood samples showed mild hypokalemia and leukopenia (4.1 cells/μL). Magnetic resonance imaging of the patient’s brain revealed a punctate T2 hyperintensity in the right frontal lobe white matter. Electroencephalography revealed mild bilateral fronto-temporal cerebral dysfunction. Cerebrospinal fluid (CSF) examination showed 41 nucleated cells/mm 3 (89% lymphocytes) and a protein level of 1.41 g/L (reference range 0.2–0.4 g/L); glucose level was within reference range. Results of laboratory testing of the CSF was negative for West Nile virus IgM, Epstein-Barr virus, cytomegalovirus, herpes simplex virus 1 and 2, and varicella zoster virus; bacterial and viral cultures yielded negative results. PCR testing of the CSF was negative for human herpesvirus 6. Additional serum testing was negative for HIV, syphilis, hepatitis B and C, and Lyme disease. PCR testing on a stool sample was negative for enteroviruses.
We ordered Powassan virus (POWV) testing of convalescent serum, and results were positive for IgM. A 90% plaque reduction neutralization test (PRNT 90 ) resulted in antibody neutralization at a dilution of 1:80 on November 3 and then 1:160 on November 6. On the basis of clinical symptoms, timeline from tick attachment to symptom onset, and confirmatory PRNT 90 , we made a diagnosis of Powassan encephalitis. After 1 week, the patient improved and was discharged. Repeat serologic testing on July 14, 2023, showed that PRNT 90 had decreased to 1:20.
POWV is a flavivirus transmitted by tick species that also act as reservoirs ( 1 ). The most consequential vectors are black-legged ticks, which are known to bite humans and can spread other tickborne pathogens such as Borrelia burgdorferi (Lyme disease), Anaplasma phagocytophilum (anaplasmosis), and Babesia microti (babesiosis) ( 2 ). Those pathogens require tick attachment periods > 24 hours ( 2 ), but according to animal studies, the transmission time of POWV from vector to host can occur in 15 minutes ( 2 ), although transmission typically occurs after 3 hours in humans ( 3 ). No human-to-human transmission has been reported.
POWV is found in Canada, the United States, and Russia ( 1 ). In the northeastern United States, > 200 cases have been reported. The highest incidence is in Wisconsin and Minnesota, both bordering Manitoba ( 1 , 4 ). Cases occur predominantly in May–November, when ticks are active ( 4 ). Only 21 cases have been reported in Ontario, New Brunswick, and Quebec ( 1 ), Canada. The true prevalence in Canada is unknown because POWV is not a reportable disease. Serologic surveys from 1968–1969 in British Columbia found antibodies in 0.129% of those tested and higher rates of 12.4% in outdoor workers ( 5 ). Studies in Ontario from the 1970s found antibodies in 0.70% of persons tested ( 1 ). The range of black-legged ticks is expanding up to 46 km annually, so exposure is likely increasing ( 6 ). No data on the prevalence of POWV in black-legged ticks in Manitoba have been published.
The incubation period of POWV is 7–34 days, after which 1–3 days of influenza-like prodrome occurs ( 7 ). Central nervous system infection with encephalitis is common ( 7 ). During 2011–2020, the United States reported 194 cases; 91.75% were neuroinvasive, and 10%–15% resulted in death ( 4 , 7 ). Fevers, weakness, headaches, and altered sensorium are the most common patient complaints reported ( 7 , 8 ). Other complaints include gastrointestinal involvement, focal neurologic signs, seizures, ataxia, twitching, tremors, and radiculitis ( 7 ). Magnetic resonance imaging findings commonly include T2/flair hyperintensities in the brainstem, cortex, and deep gray structures ( 9 ). Electroencephalography slowing has been described ( 8 ). Those findings are corroborated by autopsy results showing high POWV RNA levels in brain tissue ( 10 ). Neurologic sequelae occur in > 50% of survivors. In the case we report, the patient reported persistent ataxia for months. Because no specific antiviral drug is available, disease management consists of supportive measures for airway protection and cerebral edema and analgesia for radiculitis.
A lack of reporting, limited awareness of POWV as a causative agent of encephalitis, expanding tick range, and incomplete knowledge of prevalence has led to a lack of action against this emerging virus. Prevention strategies include avoiding ticks, using insect repellant, treating clothing with 0.5% permethrin in endemic areas, and frequent tick checks.
Dr. Smith is a second-year core internal medicine resident with the Max Rady College of Medicine at the University of Manitoba. Research interests include infectious disease and general internal medicine.
- Corrin T , Greig J , Harding S , Young I , Mascarenhas M , Waddell LA . Powassan virus, a scoping review of the global evidence. Zoonoses Public Health . 2018 ; 65 : 595 – 624 . DOI PubMed Google Scholar
- Eisen L . Pathogen transmission in relation to duration of attachment by Ixodes scapularis ticks. Ticks Tick Borne Dis . 2018 ; 9 : 535 – 42 . DOI PubMed Google Scholar
- Feder HM Jr , Telford S III , Goethert HK , Wormser GP . Powassan virus encephalitis following brief attachment of Connecticut deer ticks. Clin Infect Dis . 2021 ; 73 : e2350 – 4 . DOI PubMed Google Scholar
- Centers for Disease Control and Prevention . Powassan virus [ cited 2022 Dec 1 ]. https://www.cdc.gov/powassan/statistics.html .
- Kettyls GD , Verrall VM , Wilton LD , Clapp JB , Clarke DA , Rublee JD . Arbovirus infections in man in British Columbia. Can Med Assoc J . 1972 ; 106 : 1175 – 9 . PubMed Google Scholar
- Clow KM , Leighton PA , Ogden NH , Lindsay LR , Michel P , Pearl DL , et al. Northward range expansion of Ixodes scapularis evident over a short timescale in Ontario, Canada. PLoS One . 2017 ; 12 : e0189393 . DOI PubMed Google Scholar
- Kemenesi G , Bányai K . Tickborne flaviviruses, with a focus on Powassan virus. Clin Microbiol Rev . 2018 ; 32 : e00106 – 17 . DOI PubMed Google Scholar
- El Khoury MY , Camargo JF , White JL , Backenson BP , Dupuis AP II , Escuyer KL , et al. Potential role of deer tick virus in Powassan encephalitis cases in Lyme disease-endemic areas of New York, U.S.A. Emerg Infect Dis . 2013 ; 19 : 1926 – 33 . DOI PubMed Google Scholar
- Piantadosi A , Rubin DB , McQuillen DP , Hsu L , Lederer PA , Ashbaugh CD , et al. Emerging cases of Powassan virus encephalitis in New England: clinical presentation, imaging, and review of the literature. Clin Infect Dis . 2016 ; 62 : 707 – 13 . DOI PubMed Google Scholar
- Normandin E , Solomon IH , Zamirpour S , Lemieux J , Freije CA , Mukerji SS , et al. Powassan virus neuropathology and genomic diversity in patients with fatal encephalitis. Open Forum Infect Dis . 2020 ; 7 : ofaa392 . DOI PubMed Google Scholar
- Figure . Black-legged tick (Ixodes scapularis) after removal with tweezers from a patient in Manitoba, Canada, who was later diagnosed with Powassan virus.
Suggested citation for this article : Smith N, Keynan Y, Wuerz T, Sharma A. Powassan virus encephalitis after tick bite, Manitoba, Canada. Emerg Infect Dis. 2024 September [ date cited ]. https://doi.org/10.3201/eid3009.231344
DOI: 10.3201/eid3009.231344
Original Publication Date: August 09, 2024
1 These senior authors contributed equally to this article.
Table of Contents – Volume 30, Number 9—September 2024
| EID Search Options |
|---|
| – Search articles by author and/or keyword. |
| – Search articles by the topic country. |
| – Search articles by article type and issue. |
Please use the form below to submit correspondence to the authors or contact them at the following address:
Nathan Smith, University of Manitoba, 561 Trent Ave, Winnipeg, MB R2K1G2, Canada
Comment submitted successfully, thank you for your feedback.
There was an unexpected error. Message not sent.
Metric Details
What is the altmetric attention score.
The Altmetric Attention Score for a research output provides an indicator of the amount of attention that it has received. The score is derived from an automated algorithm, and represents a weighted count of the amount of attention Altmetric picked up for a research output.
- Alzheimer's disease & dementia
- Arthritis & Rheumatism
- Attention deficit disorders
- Autism spectrum disorders
- Biomedical technology
- Diseases, Conditions, Syndromes
- Endocrinology & Metabolism
- Gastroenterology
- Gerontology & Geriatrics
- Health informatics
- Inflammatory disorders
- Medical economics
- Medical research
- Medications
- Neuroscience
- Obstetrics & gynaecology
- Oncology & Cancer
- Ophthalmology
- Overweight & Obesity
- Parkinson's & Movement disorders
- Psychology & Psychiatry
- Radiology & Imaging
- Sleep disorders
- Sports medicine & Kinesiology
- Vaccination
- Breast cancer
- Cardiovascular disease
- Chronic obstructive pulmonary disease
- Colon cancer
- Coronary artery disease
- Heart attack
- Heart disease
- High blood pressure
- Kidney disease
- Lung cancer
- Multiple sclerosis
- Myocardial infarction
- Ovarian cancer
- Post traumatic stress disorder
- Rheumatoid arthritis
- Schizophrenia
- Skin cancer
- Type 2 diabetes
- Full List »
share this!
August 5, 2024
This article has been reviewed according to Science X's editorial process and policies . Editors have highlighted the following attributes while ensuring the content's credibility:
fact-checked
trusted source
New safety checklist aims to prevent side effects in patients with arthritis
by Line Rønn, Aarhus University

Inappropriate prescription of an antirheumatic drug for an unsuitable patient can lead to severe side effects such as intestinal perforations, blood clots, heart failure, or liver damage.
To address this issue, researchers from the Department of Biomedicine at Aarhus University and the Rheumatology Department at the University Clinic for Innovative Patient Pathways in Silkeborg have developed a comprehensive safety checklist for the newer medications used in treating rheumatic diseases.
"With the increasing number of medications on the market, it becomes more challenging for health care professionals to make prescriptions without risking serious side effects," explains Associate Professor Tue Wenzel Kragstrup, one of the researchers behind the study and article recently published in the journal Drug Safety.
The article presents the checklist designed to help prevent patients from receiving medications they cannot tolerate.
"With over 20 antirheumatic drugs, each with up to 10 specific contraindications or precautions, there is an urgent need for advanced support tools to assist doctors and pharmacists in navigating the medical landscape," adds Tue Kragstrup.
The checklist enables doctors to quickly determine if a patient has comorbidities that limit the use of certain medications.
The principles can be applied across other disease areas
This checklist is the first of its kind, created by analyzing all available patient information leaflets and international treatment guidelines in Europe and the U.S. It is based on data from both the European Medicines Agency (EMA) and the Food and Drug Administration (FDA) in the U.S..
Primarily intended for doctors prescribing medications to patients with rheumatic diseases, the study is also relevant to other doctors and patients as it highlights the risks associated with medical treatments and the need for tools to improve prescription safety in general. Dr. Lykke Skaarup, one of the researchers behind the data extraction in the study, explains.
"The principles behind the checklist can be applied across other disease areas because we have documented a method to systematically identify contraindications and precautions for a group of medications," she says.
For example, similar checklists could be created for antihypertensive drugs, migraine medications, or cholesterol-lowering drugs using the same approach.
The study has made a wide range of medication information clear, accessible, and user-friendly, enabling doctors to make more informed decisions. Consequently, they can reduce the risk of side effects and enhance patient safety for those treated for inflammatory rheumatic diseases, both now and in the future.
Tue Wenzel Kragstrup notes that the results align with previous studies highlighting the need for better medication safety.
"We hope our work can contribute to safer and more effective treatment of rheumatic diseases ," he says.
The checklist will, of course, need to be continuously updated with new research and the latest reported side effects. The researchers are already working on implementing AI-driven support tools to handle much of this task.
Explore further
Feedback to editors

Study finds baked potatoes can improve heart health for diabetics
6 hours ago

National study shows how internal medicine chief residency has changed over 20 years

Vegan diet better than Mediterranean, finds new research

Memory problems in old age linked to a key enzyme, study in mice finds

Key factor found in drug-context links, relapse

Researchers outline promises, challenges of understanding AI for biological discovery

The dengue vaccine is effective and safe: Confirmation from the first global meta-analysis
8 hours ago

'PTNM' system provides new classification for Peyronie's disease and penile curvature
9 hours ago

Researchers crack a key celiac mystery: Where the gluten reaction begins

How did mental health parity laws affect new moms?
Related stories.

One step closer to tailored treatment of severe rheumatic diseases
Jan 29, 2020

Taking too many medications can pose health risks. Here's how to avoid them
Jul 3, 2024

Systematic literature review provides evidence base for new therapeutic avenues in vasculitis
Jun 8, 2021

ACR updates guidelines for peri-TJA med use in rheumatic disease
Mar 21, 2022

Seniors, FDA has 5 medication tips to keep you safe
Feb 19, 2024

A high concentration of ACE2 in the blood may increase the risk of serious COVID-19
Jun 7, 2021
Recommended for you

New prediction model could help inform patients of their risks of having shoulder replacement surgery
Aug 1, 2024

Arthritis drugs may relieve long COVID lung symptoms
Jul 30, 2024

Study finds biosimilars offer improved outcome and lower cost for rheumatoid arthritis treatment
Jul 25, 2024

Osteoarthritis may double risk of speedy progression to severe multimorbidity, study finds
Jul 9, 2024

World's first CAR-T cell therapy for a child with lupus
Jul 8, 2024

Shoring up blood vessels may offer new approach for treating autoimmune rheumatic diseases
Jun 17, 2024
Let us know if there is a problem with our content
Use this form if you have come across a typo, inaccuracy or would like to send an edit request for the content on this page. For general inquiries, please use our contact form . For general feedback, use the public comments section below (please adhere to guidelines ).
Please select the most appropriate category to facilitate processing of your request
Thank you for taking time to provide your feedback to the editors.
Your feedback is important to us. However, we do not guarantee individual replies due to the high volume of messages.
E-mail the story
Your email address is used only to let the recipient know who sent the email. Neither your address nor the recipient's address will be used for any other purpose. The information you enter will appear in your e-mail message and is not retained by Medical Xpress in any form.
Newsletter sign up
Get weekly and/or daily updates delivered to your inbox. You can unsubscribe at any time and we'll never share your details to third parties.
More information Privacy policy
Donate and enjoy an ad-free experience
We keep our content available to everyone. Consider supporting Science X's mission by getting a premium account.
E-mail newsletter
- Open access
- Published: 13 December 2017
Systematic literature review and meta-analysis of the efficacy of artemisinin-based and quinine-based treatments for uncomplicated falciparum malaria in pregnancy: methodological challenges
- Makoto Saito 1 , 2 , 3 ,
- Mary Ellen Gilder 3 ,
- François Nosten 2 , 3 ,
- Rose McGready 2 , 3 &
- Philippe J. Guérin 1 , 2
Malaria Journal volume 16 , Article number: 488 ( 2017 ) Cite this article
5060 Accesses
19 Citations
9 Altmetric
Metrics details
There is no agreed standard method to assess the efficacy of anti-malarials for uncomplicated falciparum in pregnancy despite an increased risk of adverse outcomes for the mother and the fetus. The aim of this review is to present the currently available evidence from both observational and interventional cohort studies on anti-malarial efficacy in pregnancy and summarize the variability of assessment and reporting found in the review process.
Efficacy methodology and assessment of artemisinin-based treatments (ABT) and quinine-based treatments (QBT) were reviewed systematically using seven databases and two clinical trial registries (protocol registration—PROSPERO: CRD42017054808). Pregnant women in all trimesters with parasitologically confirmed uncomplicated falciparum malaria were included irrespective of symptoms. This review attempted to re-calculate proportions of treatment success applying the same definition as the standard WHO methodology for non-pregnant populations. Aggregated data meta-analyses using data from randomized control trials (RCTs) comparing different treatments were performed by random effects model.
A total of 48 eligible efficacy studies were identified including 7279 treated Plasmodium falciparum episodes. While polymerase chain reaction (PCR) was used in 24 studies for differentiating recurrence, the assessment and reporting of treatment efficacy was heterogeneous. When the same definition could be applied, PCR-corrected treatment failure of ≥ 10% at any time points was observed in 3/30 ABT and 3/7 QBT arms. Ten RCTs compared different combinations of ABT but there was a maximum of two published RCTs with PCR-corrected outcomes for each comparison. Five RCTs compared ABT and QBT. Overall, the risk of treatment failure was significantly lower in ABT than in QBT (risk ratio 0.22, 95% confidence interval 0.07–0.63), although the actual drug combinations and outcome endpoints were different. First trimester women were included in 12 studies none of which were RCTs of ABT.
Conclusions
Efficacy studies in pregnancy are not only limited in number but use varied methodological assessments. In five RCTs with comparable methodology, ABT resulted in higher efficacy than QBT in the second and third trimester of pregnancy. Individual patient data meta-analysis can include data from observational cohort studies and could overcome some of the limitations of the current assessment given the paucity of data in this vulnerable group.
Approximately 60% of all pregnancies worldwide take place in malaria endemic areas, leading to 125 million pregnant women at risk of malaria every year [ 1 ]. Malaria in pregnancy, regardless of whether it is clinically symptomatic or not, has been reported to be associated with a higher risk of preterm birth, low birth weight for gestational age, miscarriage, stillbirth and maternal anaemia [ 2 , 3 , 4 , 5 ]. These adverse outcomes lead to a higher risk of perinatal mortality and maternal mortality in areas with low or declining malaria prevalence compared to high transmission areas because of lower levels of premunition [ 6 , 7 ].
In order to mitigate these adverse effects, efficacious treatments need to be clearly identified for pregnant women. However, several factors have limited the available evidence on anti-malarials efficacy during pregnancy. Pregnant women are usually excluded from randomized control trials (RCTs) of new anti-malarials mainly because of concerns about the safety for the fetus. Safety concerns were particularly critical for artemisinin derivatives, as fetal resorption was observed in animal studies [ 8 , 9 , 10 , 11 , 12 , 13 ]. Quinine-based treatment (QBT) is still recommended as the first-line treatment for uncomplicated falciparum malaria in the first trimester [ 14 ], despite limited clinical data on its safety in the first trimester [ 15 , 16 ]. Quinine’s poor side effect profile and long treatment course of 5–7 days make it an undesirable choice for patients [ 15 , 16 , 17 ]. Recently, data from prospective observational cohort studies suggest that artemisinin use in the first trimester did not increase the risks of stillbirth or congenital abnormality compared to quinine [ 3 , 18 , 19 , 20 , 21 ], bringing the question of comparative efficacy into center stage.
Efficacy of anti-malarial drugs for treating uncomplicated malaria in non-pregnant patients has traditionally been assessed over a fixed follow-up period set by the current World Health Organization (WHO) recommendations at 28–42 days [ 22 ]. However, this fixed period does not accommodate the pregnant condition as the placenta may become or remain parasitized (placental sequestration) after treatment completion [ 23 ]. There are currently no standard guidelines on parasitological efficacy studies in pregnancy [ 24 ].
With this in mind, this systematic literature review aims to update the currently available efficacy data of artemisinin-based treatments (ABT) and QBT from both observational and interventional cohort studies in all trimesters with uncomplicated falciparum malaria. Methodological challenges will also be summarized to improve future efficacy studies in pregnancy.
A systematic literature review following PRISMA statement [ 25 ] was conducted to identify studies measuring the efficacy of ABT or QBT in pregnant women with parasitologically confirmed uncomplicated falciparum malaria, regardless of trimester or clinical symptoms. Seven databases (MEDLINE, Embase, Global Health, Cochrane Library, Scopus, Web of Science and LILACS) and two clinical trial registries (ICTRP and ClinicalTrial.gov) were used. This review is registered to PROSPERO (CRD42017054808), and the search terms and conditions are available in Additional file 1 .
The search (conducted 9 July 2016–10 January 2017) combined five components: malaria; pregnancy; treatment or names of anti-malarial drugs; study design (interventional or observational cohort studies); and outcome types (efficacy) without limitation on publication year or language. Two reviewers (MS and MEG) assessed eligibility independently, and discrepant results were resolved by a second assessment.
Both interventional and observational cohort studies were included. Studies without any active follow-up in the first 28 days were excluded. Studies with fewer than ten pregnant women were excluded, as they could not be included in further meta-analyses. Systematic reviews on the anti-malarial treatment in pregnancy [ 15 , 26 , 27 , 28 , 29 ] were checked for any other possible missing articles that should be included.
Uncomplicated Plasmodium falciparum malaria was defined as malaria infection without features of severe malaria [ 14 ]. Pregnancy was described by trimesters: the first as < 13 completed weeks, the second as from 14 weeks to 27 completed weeks, and the third from 28 weeks until delivery.
After screening, the following data were extracted: demographic information of study (year, country, study design, study drugs and eligibility criteria), availability of outcome assessment (clinical outcomes, parasitological outcomes) and the methodology of assessment of variables (definition of treatment success and statistical method). Information was sought from published articles, clinical trial registry and protocols if available. Missing information was supplemented by personal correspondence to authors of the original studies if possible. This review describes the methodology of assessment and reporting, and summarizes the reported efficacy results. Comparisons were made only if the same or similar assessment methods were used.
The WHO recommends that treatment failure and completion of follow-up without treatment failure (adequate clinical and parasitological response, ACPR) be used as efficacy endpoints in non-pregnant populations, and that results be expressed as the proportion of ACPR or the cumulative success using Kaplan–Meier survival analysis. WHO advises patients with polymerase chain reaction (PCR)-confirmed reinfection with P. falciparum , infection with other malaria species, or loss to follow-up to be censored on the day of these events in the survival analysis and to be excluded from the proportional ACPR analysis [ 22 ]. Patients without PCR results or with indeterminate PCR results are to be excluded from both PCR-corrected survival analysis and PCR-corrected proportional ACPR analysis.
For the comparability across studies, PCR-corrected proportional ACPR was recalculated using the WHO guideline for non-pregnant populations [ 22 ], with the exception of cases with non-falciparum malaria infection which could not be excluded without detailed individual patient data. When the number of patients with ACPR was unavailable, it was estimated from the presented results and included for reference. PCR-corrected ACPR of 90% was used as the cut-off value to judge whether the treatment was satisfactory or not [ 14 ]. The 95% confidence interval (CI) for the proportion was calculated by the Wilson method [ 30 ]. Random effects meta-analyses using aggregated results from RCTs were conducted if there were more than two RCTs. Heterogeneity was assessed using I 2 [ 31 ]. If there was no treatment failure, a continuity correction was made by adding 0.5 for both treatment success group and failure group. The quality of data at both the study level and each outcome level was assessed using the GRADE system [ 32 ]. GRADEpro was used for making an evidence profile table [ 33 ]. For assessing publication bias, funnel plots of the proportions were drawn with log odds for the x-axis and study size (number of patients in each treatment arm) for the y-axis [ 34 ]. Asymmetry was judged visually, as formal statistical tests have not been developed for this method [ 34 ]. For odds ratios, Egger’s test was used for checking the asymmetry of funnel plots [ 35 ]. STATA MP 14.2 (Stata Corp, Texas, US) was used for the statistical analyses.
A total of 48 study cohorts assessing treatment efficacy for uncomplicated falciparum malaria in pregnancy were identified (see Additional file 2 ) evaluating at least 7279 episodes of parasitologically confirmed uncomplicated falciparum. Studies based on the same cohort were considered as a single study. Forty-one studies were published, five presented at conferences, and two were registered on a public trials database but not yet published. Twenty-six studies (54%) were from sub-Saharan Africa, 19 (40%) from Southeast Asia, two (4%) from Latin America and one (2%) from India (Fig. 1 ). As of January 2017, all unpublished registered trials assessing anti-malarial efficacy in pregnancy were either completed (n = 2) or withdrawn (n = 3): two trials (NCT00331708, NCT01082731) were terminated because of slow recruitment, and the other (NCT01082718) was withdrawn before enrolment.
Number of studies on treatment efficacy of malaria in pregnancy per 5 years (1985–2016). The first year of study period was used for categorization. No studies were identified after 2015
The study designs comprised 22 RCTs comparing two or more treatment regimens [ 17 , 36 , 37 , 38 , 39 , 40 , 41 , 42 , 43 , 44 , 45 , 46 , 47 , 48 , 49 , 50 , 51 , 52 , 53 , 54 , 55 , 56 , 57 ], 10 pharmacokinetic (PK) studies including clinical outcome assessment [ 58 , 59 , 60 , 61 , 62 , 63 , 64 , 65 , 66 , 67 , 68 ], six single arm interventional studies [ 69 , 70 , 71 , 72 , 73 , 74 ] and 10 observational cohort studies [ 75 , 76 , 77 , 78 , 79 , 80 , 81 , 82 , 83 , 84 , 85 ] (Table 1 and Additional file 3 ). Blinding varied with one double-blind study [ 54 ] and one study using placebo but with unspecified blinding [ 17 ] (see Additional file 4 ). In seven studies, assessors and laboratory staff (n = 2) [ 45 , 48 ] or only laboratory staff (e.g. microscopists) (n = 5) [ 44 , 46 , 50 , 52 , 57 ] were blinded.
Study drugs
Fourteen studies included women treated with QBT, 40 studies included ABT, and six studies included both. Altogether, 6244 and 1035 episodes were treated with ABT or QBT, respectively.
Quinine was administered at 30 mg/kg/day for 7 days in nine studies (64%, 9/14). The other five studies gave similar dosing with slight variations: one study administered for 7- or more-days depending on the clinical condition [ 39 ]; one study started with intravenous quinine until oral therapy was tolerated [ 36 ]; and one study compared standard dose with lower dose (20 mg/kg/day) for 7 days [ 43 ]; one study administered 30 mg/kg/day for 5 days [ 17 ]; one study gave 1800 mg/day for 7 days [ 37 ]. Artesunate was given at 10–16 mg/kg/course (600–900 mg/course) over 3–7 days except in two PK studies: one PK study administered 200 mg of artesunate once [ 60 ], and the other PK study administered total 28 mg/kg over 7 days (1 day intravenously and 6 days orally) [ 61 ]. Artesunate–amodiaquine (ASAQ) was given as a fixed dose combination in four studies (57%, 4/7) and as a non-fixed dose combination with 30 mg/kg of amodiaquine in three studies (43%, 3/7). Artesunate–mefloquine (ASMQ) was given as a fixed dose combination in four studies (36%, 4/11) and as a non-fixed dose combination with 25 mg/kg of mefloquine in six studies (55%, 6/11). Non-fixed dose combination of an unknown dose was assumed to be used in one study [ 81 ]. Artemether–lumefantrine (AL) was administered for 3 days (88%, 14/16) except two studies: one for 4 days [ 57 ] and the other for 5 days [ 53 ]. Supervision of treatments also varied (see Additional file 5 ).
Five RCTs compared QBT and ABT but only two of them used the same ABT (i.e. non-fixed dose combination ASMQ) [ 39 , 40 , 41 , 42 , 48 ]. Ten RCTs compared different combinations of ABT [ 38 , 45 , 49 , 50 , 52 , 53 , 54 , 55 , 56 , 57 ] (see Additional file 6 ). Two RCTs compared different regimens of QBT [ 17 , 43 ], two compared quinine versus non-ABT [ 36 , 37 ] and three compared ABT versus non-ABT (e.g. sulfadoxine–pyrimethamine (SP) or chlorproguanil–dapsone) [ 44 , 46 , 47 ].
Inclusion criteria
The demographic background of patients is summarized (see Additional file 7 ). Asymptomatic patients were included in 55% (12/22) of RCTs and 50% (13/26) of non-RCTs. Two of them included only asymptomatic women [ 52 , 60 ]. Fifteen studies (31%, 15/48) intentionally included patients who failed previous treatment, but only three of them were RCTs [ 38 , 43 , 45 ].
Overall, twelve studies (25%, 12/48) included first trimester women (see Additional file 3 ), describing at least 599 parasitologically confirmed first-trimester malaria episodes treated with ABT (n = 108) or QBT (n = 491). Only one RCT intentionally included first trimester women; it was published in 1990 and compared quinine versus mefloquine [ 37 ].
In 26 studies from Africa, three studies gave two doses of intermittent preventive treatment in pregnancy (IPTp)-SP [ 54 , 63 , 66 ], and one study gave three doses [ 84 ]. One study reported the percentage of women who received IPTp [ 83 ]. IPTp-SP was not administered during the whole pregnancy in one study [ 48 ] and during the study period in two other studies [ 50 , 52 ]. In one study, enrolled patients systematically received the study drug 4 weeks after the initial treatment instead of IPTp-SP [ 44 ].
Assessment of treatment efficacy
Duration of follow-up.
The primary endpoint for assessing anti-malarial efficacy varied: less than 28 days (n = 2), day 28 (n = 18), day 42 (n = 10), day 56 (n = 2), day 63 (n = 5) and until delivery (n = 10) (Table 1 ). The duration of follow-up was unclear for one conference abstract [ 81 ]. After the primary endpoint of 28–63 days, a further 14 studies continued assessing parasitaemia until delivery but with different schedules and five other studies did not continue but assessed parasitaemia only at delivery.
Methodology of reporting efficacy
For handling treatment failure, the majority of the studies (96%, 46/48) followed WHO standards for non-pregnant populations, except two studies which excluded cases who developed severe malaria after the treatment (i.e. early treatment failure) from the final result [ 40 , 47 ].
Twenty-seven studies (56%, 27/48) showed only the proportional ACPR or the number of patients with ACPR (or failure). Ten studies [ 40 , 41 , 42 , 45 , 57 , 61 , 62 , 75 , 77 , 82 ] derived cumulative success (or failure) by survival analysis instead of or in addition to proportional ACPR. Five other studies [ 44 , 48 , 50 , 54 , 68 ] used survival analysis to compare the different groups, but the proportional ACPR was presented as the point estimates. Two studies did not report ACPR but reported time to parasite clearance based on daily parasitaemia measurements [ 36 ] or time to recurrence [ 78 ]. Information was not available from four unpublished studies.
PCR was used in 24 studies (50%, 24/48) for differentiating recurrences (Table 1 ), although in one of the studies PCR results were considered not to be reliable because of technical problems [ 52 ]. Thirteen studies (27%, 13/48) used three standard molecular markers (i.e. msp - 1 , msp - 2 and glurp ). Three of the studies adopted sequential genotyping strategy [ 48 , 50 , 63 ], while the remaining ten studies ran all three markers for all recurrences. Four studies (8%, 4/48) used one of the three markers [ 44 , 46 , 65 , 68 ]. Two studies (4%, 2/48) used six microsatellite markers [ 66 , 85 ]. Two published studies and two registered trials (8%, 4/48) did not specify the details of molecular markers [ 56 , 57 , 59 , 82 ]. An additional six studies (13%, 6/48) did not observe any late treatment failure [ 39 , 47 , 49 , 70 , 72 , 73 ], so a total of 29 (60%, 29/48) studies contained adequate information to obtain PCR-corrected results.
There was substantial heterogeneity in how reinfections and indeterminate PCR results were handled in deriving proportional ACPR. WHO recommends excluding these cases from proportional ACPR calculations in non-pregnant populations [ 22 ]. Reinfection was excluded except in two studies in which reinfections were included as treatment success [ 44 , 50 ]. One study did not clearly report whether there were any reinfections [ 43 ]. Two studies excluded indeterminate outcomes from the calculation [ 48 , 50 ], and one of them also presented results with imputation for indeterminate cases for reference [ 50 ]. Two studies using survival analysis regarded indeterminate results as recrudescence as the worst case scenario [ 40 , 82 ]. One study did not explain how they dealt with missing PCR results [ 46 ]. For proportional ACPR, no studies clearly excluded patients infected with other species of malaria before recurrence of falciparum, as recommended by the WHO non-pregnant guideline. Only one study presented results of a model which censored patients infected with Plasmodium vivax before recurrence of P. falciparum , and this result was provided as additional information and not the primary analysis (which did not account for P. vivax infection) [ 45 ].
Gametocyte carriage is summarized in Additional file 8 . Interruption of treatment and associated adverse symptoms are summarized in Additional file 5 .
Fever and parasite clearance
Fever was assessed daily or more frequently in 27 studies (56%, 27/48) and time to fever clearance was reported in 12 studies (25%, 12/48). Prevalence of clearance of fever at fixed points (on day 2, 3 or 4) was reported in other 12 studies (25%, 12/48). Blood smear was assessed for parasitaemia daily or more frequently at least for the first 3 days in 30 studies (63%, 30/48) and time to parasite clearance was reported in 16 studies (33%, 16/48). The proportion of women who cleared parasitaemia at fixed points (i.e. by 12 h, on day 1, 2 or 3) was reported in another 14 studies (29%, 14/48).
The variability of reporting parasite and fever clearance limited comparisons across studies. In five RCTs comparing ABT and QBT, three and five RCTs reported the comparison of fever clearance and parasite clearance, respectively. One RCT reported that the mean time to fever clearance was significantly shorter by ASMQ than quinine (4.47 days vs 8.04 days, p < 0.001), although this time was from the appearance of fever according to the patients’ history rather than from the treatment [ 39 ]. Another two studies reported no difference in the proportion of febrile patients or the proportion of fever clearance by day 2 or 3 between ABT and QBT [ 42 , 48 ]. On the other hand, all five RCTs reported faster parasite clearance by ABT than by QBT. The mean or median time to parasite clearance was shorter by ABT than by quinine in two RCTs [ 39 , 42 ]. Similarly, the proportion of parasite clearance by 48 h [ 40 , 41 ] and negative parasitaemia on day 2 [ 48 ] were higher with ABT than QBT, although this difference was not observed on day 3 [ 48 ].
Between different ACTs, lower parasite clearance on day 1 was reported with AL compared to ASAQ, ASMQ and dihydroartemisinin–piperaquine (DP), although this was not significant on day 2 [ 50 ]. Other two RCTs also showed no difference in parasite clearance on day 3 between AL and ASAQ [ 54 , 55 ]. The median or mean time to fever and parasite clearance were not different between artesunate monotherapy and AL [ 45 ], and between intramuscular artemether with or without mefloquine, respectively [ 38 ].
Summary of reported ACPR
PCR-corrected treatment failure of ≥ 10% at any time points was observed in 3 (10%, 3/30) ABT arms and 3 (43%, 3/7) QBT arms (Figs. 2 , 3 ). On day 28, two study arms had PCR-corrected treatment failure of ≥ 10%. One of them used a lower dose quinine (10 mg/kg twice daily rather than thrice daily) [ 43 ]. In the other study which reported the low efficacy of AL, 33% of the enrolled patients were under retreatment, having failed previous treatment [ 45 ]. If retreatments were excluded, the cumulative success of AL on day 42 was > 90% [ 45 ]. Other study arms with PCR-corrected treatment failure of ≥ 10% were observed on day 63 (one quinine arm [ 40 ] and one artesunate monotherapy arm [ 61 ]) and until delivery (one quinine arm [ 42 ] and one AL arm [ 85 ]). The funnel plots for PCR-corrected ACPR on ABT and QBT did not show apparent asymmetry (see Additional file 9 ).
The PCR-corrected proportional adequate clinical and parasitological response (ACPR) for each study. ACPR are shown by treatment group and the duration of follow-up (i.e. day 28, 42, 63 and at delivery) with 95% confidence intervals. *ACPR at later follow-up day is available. AAP artesunate + atovaquone–proguanil, AC artesunate + clindamycin, AL artemether–lumefantrine, AM artemether, AS artesunate, AQ amodiaquine, DP : dihydroartemisinin–piperaquine, FDC : fixed dose combination, MQ mefloquine, NFDC non-fixed dose combination, Q quinine, QC quinine + clindamycin, SP sulfadoxine–pyrimethamine
The PCR-corrected proportional adequate clinical and parasitological response (ACPR) for each study (continued). ACPR are shown by treatment group and the duration of follow-up (i.e. day 28, 42, 63 and at delivery) with 95% confidence intervals. AAP artesunate + atovaquone–proguanil, AC artesunate + clindamycin, AL artemether–lumefantrine, AM artemether, AS artesunate, AQ amodiaquine, DP : dihydroartemisinin–piperaquine, FDC : fixed dose combination, MQ mefloquine, NFDC non-fixed dose combination, Q quinine, QC quinine + clindamycin, SP sulfadoxine–pyrimethamine
PCR-uncorrected ACPR was available in 14 QBT arms and 47 ABT arms (see Additional file 10 ). PCR-uncorrected ACPR at different time points was available in some studies, and if it was not reported on day 28 but was > 80% on day 42, 63 or at delivery, it was assumed to be > 80% on day 28. Although different levels of the risk of reinfection due to the time and location complicate comparison between studies, at least 50% (7/14) of QBT arms showed ≤ 80% protection within 28 days while at least 79% (37/47) of ABT arms showed > 80% protection within 28 days. Two ABT arms reporting ≤ 80% protection within 28 days were both conducted in high endemic areas and used AL or artesunate + SP [ 44 , 74 ]. PCR-uncorrected ACPR on day 28 was not available but it was ≤ 80% after day 28 in other eight arms from six studies [ 45 , 50 , 61 , 75 , 77 , 82 ]. ABT went on to provide protection in > 80% of patients at 42 days in at least 73% (22/30) of the study arms which followed for 42 days or longer.
PCR-corrected ACPR comparing different treatments
Overall, the risk of treatment failure in the five RCTs available for meta-analysis was significantly lower in patients treated with ABT compared to QBT (risk ratio 0.22, 95% confidence interval 0.07–0.63) (Fig. 4 ), although the compared treatments and methodologies differed (see Additional file 11 ). This increased risk of failure with QBT was prominent when the patients were followed up longer. There was no evidence for asymmetry of the funnel plot suggesting publication bias (p = 0.7) (see Additional file 12 ). None of these five RCTs included pregnant women in the first trimester.
Meta-analysis of risk of PCR-corrected treatment failure comparing quinine-based treatment and artemisinin-based treatment. The outcome of longest duration of follow-up was used. Random effects model was used for meta-analyses. Continuity correction was made for two studies without treatment failure by adding 0.5. AAP artesunate–atovaquone–proguanil, AL artemether–lumefantrine, AS artesunate, ASMQ artesunate–mefloquine, CI confidence interval, Q quinine, QC quinine-clindamycin, NFDC non-fixed dose combination
The limited number of available studies with PCR-corrected outcome comparing different ABTs precluded aggregated data meta-analysis. One RCT reported that PCR-corrected ACPR on day 63 was lower for AL than DP, ASAQ and ASMQ, although the absolute difference was < 5% [ 50 ]. Lower efficacy of AL than artesunate for 7 days was also reported when used for treating recrudescent infections [ 45 ].
Time to recrudescence
Recrudescence in pregnancy occurred after day 28 or 42, the fixed follow-up periods recommended by WHO for non-pregnant populations. In one study, one-third of the recrudescence following AL or artesunate monotherapy occurred after day 42 [ 45 ], and four studies reported recrudescence after 100 days with a maximum of 138 days [ 42 , 44 , 48 , 78 ]. These long intervals were reported from both sub-Saharan Africa and Southeast Asia.
Risk factors for recrudescence in pregnancy
Baseline characteristics were assessed as risk factors of parasite clearance (n = 1) [ 36 ], recrudescence (n = 2) [ 51 , 65 ] and recurrence (n = 3) [ 52 , 67 , 71 ]. One study reported gestation (early second trimester) to be associated with faster parasite clearance than late second trimester but not fever clearance [ 36 ]. Gravidity was not associated with parasite or fever clearance [ 36 ].
For recrudescence, higher baseline parasitaemia and younger maternal age were associated with higher risk in one study [ 51 ], while the other study did not find significant association with parasitaemia [ 65 ]. Gestational age (n = 2) [ 51 , 65 ], gravidity (n = 1) [ 51 ], haemoglobin concentration (n = 1) [ 51 ], body mass index (n = 1) [ 65 ] and symptomatic infection (n = 1) [ 51 ] were not significant risk factors of recrudescence.
For recurrence, higher baseline parasitaemia [ 71 ], younger age [ 71 ] and lower haemoglobin concentration [ 67 ] each were associated with higher risk in one of the studies, while the other two studies did not show the associations with parasitaemia [ 52 , 67 ], age [ 52 , 67 ] or baseline haemoglobin concentration [ 52 , 71 ]. Lower body weight was shown to be associated with higher risk of recurrence [ 71 ]. Gestational age (n = 3) [ 52 , 67 , 71 ], gravidity (n = 3) [ 52 , 67 , 71 ], parity (n = 1) [ 71 ], body temperature (n = 1) [ 71 ] were not associated with the risk of recurrence.
The risk of recrudescence was higher when the drugs were used for retreatment (artemisinins [ 77 ] and quinine [ 76 ]) or recrudescence (AL) [ 45 ] than for novel infection.
Placental malaria
Placental malaria was assessed in 14 studies (29%, 14/48) in various ways (see Additional file 13 ). Placental histopathology is the gold standard and was examined in at least six studies [ 39 , 44 , 48 , 50 , 57 , 84 ], but the reporting and interpretation of the results varied with at least four different definitions [ 86 , 87 , 88 , 89 ]. The prevalence of placental malaria after treatment ranged from < 10% [ 45 , 48 , 62 , 80 ] to 44.8% [ 44 ], and was not different among different ABTs [ 50 , 52 ] or between AL and quinine [ 48 ].
Congenital malaria
The peripheral blood of the newborn was assessed for malaria in six studies, of which three assessed all newborns systematically at delivery and reported the results [ 38 , 45 , 48 ]. Another two studies reported congenital malaria as a possible reason for neonatal deaths but did not report whether they tested for congenital malaria systematically [ 40 , 42 ]. One further study assessed congenital malaria but did not report the results [ 63 ]. No studies specified further parasitological monitoring of infants for congenital malaria diagnosed after the perinatal period.
This review revealed the variability of study design, drugs, treatment regimens for the same drug, inclusion criteria, determination of parasitological efficacy, follow-up duration and detection of parasites in mother, placenta and newborn at delivery. The design of studies to assess the efficacy of anti-malarials during pregnancy is not standardized, and investigators are using varied adapted versions of the protocol for the non-pregnant populations currently recommended by WHO [ 22 ].
The efficacy of ABT was generally satisfactory with ACPR of > 90%, although aggregated efficacy results are limited by heterogeneous methods as well as differences in patient immunity, background, symptoms, time and study site. If aggregated results are used, only a maximum of two RCTs was available for each comparison. Slightly lower efficacy of AL than other ABTs was reported in two studies [ 45 , 50 ], and this may be explained by differences in the pharmacokinetics and pharmacodynamics of lumefantrine in pregnant women [ 45 , 48 , 66 , 67 , 90 , 91 , 92 , 93 ]. On the Thailand–Myanmar border, the proportion of PCR-corrected ACPR of AL was markedly low in a study of pregnant women (< 85%) [ 45 ] and not comparable to that (> 95%) reported from studies in non-pregnant populations [ 94 , 95 ]. Monitoring of efficacy in pregnancy remains a useful assessment in its own right. Optimal dosing for pregnant women should be sought and extending treatment course can be an option to improve the efficacy [ 96 ]. The results of two studies assessing longer duration and higher doses of AL [ 53 , 57 ] are awaited.
The available data implied QBT has two major but not unexpected drawbacks compared to ABT (see Additional file 11 ): lower treatment efficacy and lower adherence. In at least 50% (7/14) of the study arms, one in five pregnant women or more suffered another episode of malaria parasitaemia (either recrudescence or reinfection) within 28 days after treatment by quinine. Although these studies were conducted mostly in Southeast Asia, the risk of recurrence of malaria is expected to be even higher in the high endemic areas in sub-Saharan Africa considering the short half-life of quinine. This finding is important as repetitive malaria infections during pregnancy increase adverse effects of miscarriage, small for gestational age and preterm birth cumulatively [ 18 , 97 ]. Adherence to a 7-day treatment outside of a clinical trial context is difficult for pregnant women due to the common side effect of tinnitus, which is particularly intolerable in the first 4 months of pregnancy when morning sickness peaks [ 17 ]. Adding clindamycin to quinine might provide satisfactory efficacy equivalent to ABT, but it will not overcome the poor adherence.
Several components of efficacy evaluation should be standardized for future studies. Duration of the follow-up period needs to be optimized for pregnant women considering physiological variations related to pregnancy [ 15 , 23 , 40 , 78 ]: placenta sequestration [ 98 ]; different drug metabolism and distribution [ 99 , 100 ]; and altered immunity profile [ 98 ]. The current WHO recommendation of follow-up for 28–42 days [ 22 ] is based on the fact that the proportion of recrudescence after 28–42 days is negligible in the non-pregnant populations [ 101 ]. However, recrudescence in pregnancy was relatively commonly observed after 42 days, demonstrating the need for prolonged follow-up in pregnancy studies. In the small number of studies that have collected relevant data, recrudescence even after 100 days has been reported in pregnant women both in Africa [ 44 , 48 , 102 ] and Southeast Asia [ 42 , 78 ]. The duration of parasitological follow-up after delivery also needs to be considered when delivery occurs before the end of the recommended follow-up.
Two problems were encountered with proportional ACPR for pregnancy studies. The lack of a standard led to inconsistent handling of reinfections in proportional ACPR calculations making comparisons across studies difficult. In non-pregnant populations, WHO recommends excluding those with reinfection or indeterminate PCR results from the calculation of PCR-corrected proportional ACPR [ 22 ]. However, higher proportions of reinfection and lost-to-follow-up are anticipated if longer follow-up is recommended for pregnant women. If proportional ACPR is calculated, much information will be lost. Survival analysis with censorship of these cases is likely to be a preferable approach for pregnancy studies [ 103 ].
Data on efficacy in the first trimester are limited to information from observational studies, precluding comparison of the outcomes using aggregated results. In addition, the published results were rarely presented separately by trimester, and the methods and quality of gestational age assessment were limited [ 104 ].
Finally, and importantly, it needs to be emphasized that pregnant women may experience several episodes of malaria during pregnancy. The relationship between placental malaria, which is a direct consequence of malaria infection, and treatment outcomes for each malaria episode is not fully understood and may be heavily biased by gestational age at infection [ 105 ]. In this context, PCR-uncorrected ACPR, in which the half-life of drugs will play a key role, becomes an important indicator for choosing treatment options especially in high endemic settings [ 51 ]. Efficacy cannot be discussed separately from pregnancy outcomes as drugs may affect the fetus. Ideally, the safety of drugs should be assessed and reported within efficacy studies, using a standard which has been reviewed elsewhere [ 106 ]. Inclusion rather than exclusion of pregnant women into routine therapeutic efficacy studies could be a key change to address the paucity of data in the future when drugs have a clean teratogenicity profile. This would also permit comparison of efficacy and drug levels in pregnant and non-pregnant females. Recommendations specific to the determination of anti-malarial efficacy of uncomplicated P. falciparum infection in pregnancy beyond the WHO guideline for non-pregnant populations are listed in Table 2 .
The assessment of anti-malarial efficacy presented here is limited by the paucity of data, the heterogeneity of studies, and the constraints of aggregated data meta-analysis. With no new RCTs on efficacy in pregnancy notified in trial registries, the treatment episodes in the cohort of studies described here will be the only data available in the near future to describe the efficacy of anti-malarials in pregnancy. Because of the paucity of studies, different methodologies and backgrounds (regional endemicity, seasonality of infection) of patients, conventional meta-analysis using aggregated data will not allow an optimal assessment of the findings. Reviews attempting aggregated data meta-analysis, including this work, should be interpreted with caution considering the different endpoints and drugs used. In addition, RCTs comparing ABT and QBT were mostly conducted in Southeast Asia. Though the conclusion of the comparison between ABT and QBT is unlikely to change considering the large magnitude of the effect, assessing smaller differences between ABTs would be valuable and cannot be effectively done by aggregated data meta-analysis. Individual patient data meta-analyses offer a better methodological approach to summarize the currently available data, integrating the data from non-comparative studies. A new study group at the WorldWide Antimalarial Resistance Network [ 107 ] is proposed to tackle these issues by conducting individual patient data meta-analyses.
Although this and other reviews of ABTs and QBTs for malaria in pregnancy suggest ABTs are superior, further aggregated meta-analysis was hampered by inconsistencies in measurement and reporting. A standard framework for anti-malarial efficacy studies in pregnancy is warranted and will be a foundation for research with more comparable and reliable outputs.
Abbreviations
artemisinin-based treatments
artesunate + clindamycin
adequate clinical and parasitological response
artemether–lumefantrine
artesunate–amodiaquine
artesunate–mefloquine
confidence interval
dihydroartemisinin–piperaquine
intermittent preventive treatment in pregnancy
polymerase chain reaction
pharmacokinetic
quinine-based treatments
quinine + clindamycin
randomized control trial
sulfadoxine–pyrimethamine
World Health Organization
Dellicour S, Tatem AJ, Guerra CA, Snow RW, ter Kuile FO. Quantifying the number of pregnancies at risk of malaria in 2007: a demographic study. PLoS Med. 2010;7:e1000221.
Article PubMed PubMed Central Google Scholar
Desai M, ter Kuile FO, Nosten F, McGready R, Asamoa K, Brabin B, et al. Epidemiology and burden of malaria in pregnancy. Lancet Infect Dis. 2007;7:93–104.
Article PubMed Google Scholar
McGready R, Lee SJ, Wiladphaingern J, Ashley EA, Rijken MJ, Boel M, et al. Adverse effects of falciparum and vivax malaria and the safety of antimalarial treatment in early pregnancy: a population-based study. Lancet Infect Dis. 2012;12:388–96.
Article CAS PubMed PubMed Central Google Scholar
Moore KA, Fowkes FJI, Wiladphaingern J, Wai NS, Paw MK, Pimanpanarak M, et al. Mediation of the effect of malaria in pregnancy on stillbirth and neonatal death in an area of low transmission: observational data analysis. BMC Med. 2017;15:98.
Cottrell G, Moussiliou A, Luty AJ, Cot M, Fievet N, Massougbodji A, et al. Submicroscopic Plasmodium falciparum infections are associated with maternal anemia, premature births, and low birth weight. Clin Infect Dis. 2015;60:1481–8.
Rijken MJ, McGready R, Boel ME, Poespoprodjo R, Singh N, Syafruddin D, et al. Malaria in pregnancy in the Asia–Pacific region. Lancet Infect Dis. 2012;12:75–88.
Mayor A, Bardaji A, Macete E, Nhampossa T, Fonseca AM, Gonzalez R. Changing trends in P. falciparum burden, immunity, and disease in pregnancy. N Engl J Med. 2015;373:1607–17.
Article CAS PubMed Google Scholar
Clark RL. Embryotoxicity of the artemisinin antimalarials and potential consequences for use in women in the first trimester. Reprod Toxicol. 2009;28:285–96.
Li Q, Weina PJ. Severe embryotoxicity of artemisinin derivatives in experimental animals, but possibly safe in pregnant women. Molecules. 2010;15:40–57.
Article CAS Google Scholar
White TE, Clark RL. Sensitive periods for developmental toxicity of orally administered artesunate in the rat. Birth Defects Res B Dev Reprod Toxicol. 2008;83:407–17.
Clark RL, White TE, Clode SA, Gaunt I, Winstanley P, Ward SA. Developmental toxicity of artesunate and an artesunate combination in the rat and rabbit. Birth Defects Res B Dev Reprod Toxicol. 2004;71:380–94.
Clark RL, Arima A, Makori N, Nakata Y, Bernard F, Gristwood W, et al. Artesunate: developmental toxicity and toxicokinetics in monkeys. Birth Defects Res B Dev Reprod Toxicol. 2008;83:418–34.
Gomes C, Boareto AC, Dalsenter PR. Clinical and non-clinical safety of artemisinin derivatives in pregnancy. Reprod Toxicol. 2016;65:194–203.
WHO. Guidelines for the treatment of malaria. 3rd ed. Geneva: World Health Organization; 2015.
Google Scholar
Nosten F, McGready R, d’Alessandro U, Bonell A, Verhoeff F, Menendez C, et al. Antimalarial drugs in pregnancy: a review. Curr Drug Saf. 2006;1:1–15.
Achan J, Talisuna AO, Erhart A, Yeka A, Tibenderana JK, Baliraine FN, et al. Quinine, an old anti-malarial drug in a modern world: role in the treatment of malaria. Malar J. 2011;10:144.
Nosten F, ter Kuile F, Thwai KL, Maelankirri L, White NJ. Spiramycin does not potentiate quinine treatment of falciparum malaria in pregnancy. Trans R Soc Trop Med Hyg. 1993;87:305–6.
Moore KA, Simpson JA, Paw MK, Pimanpanarak M, Wiladphaingern J, Rijken MJ, et al. Safety of artemisinins in first trimester of prospectively followed pregnancies: an observational study. Lancet Infect Dis. 2016;16:576–83.
Mosha D, Mazuguni F, Mrema S, Sevene E, Abdulla S, Genton B. Safety of artemether–lumefantrine exposure in first trimester of pregnancy: an observational cohort. Malar J. 2014;13:197.
Article PubMed PubMed Central CAS Google Scholar
Dellicour S, Desai M, Aol G, Oneko M, Ouma P, Bigogo G, et al. Risks of miscarriage and inadvertent exposure to artemisinin derivatives in the first trimester of pregnancy: a prospective cohort study in western Kenya. Malar J. 2015;14:461.
Dellicour S, Sevene E, McGready R, Tinto H, Mosha D, Manyando C, et al. First-trimester artemisinin derivatives and quinine treatments and the risk of adverse pregnancy outcomes in Africa and Asia: a meta-analysis of observational studies. PLoS Med. 2017;14:e1002290.
WHO. Methods for surveillance of antimalarial drug efficacy. Geneva: World Health Organization; 2009.
Nosten F, Rogerson SJ, Beeson JG, McGready R, Mutabingwa TK, Brabin B. Malaria in pregnancy and the endemicity spectrum: what can we learn? Trends Parasitol. 2004;20:425–32.
Nosten F, McGready R, Mutabingwa T. Case management of malaria in pregnancy. Lancet Infect Dis. 2007;7:118–25.
Liberati A, Altman DG, Tetzlaff J, Mulrow C, Gotzsche PC, Ioannidis JP. The PRISMA statement for reporting systematic reviews and meta-analyses of studies that evaluate health care interventions: explanation and elaboration. PLoS Med. 2009;6:e1000100.
McGready R, Nosten F. Which drug is effective and safe for acute malaria in pregnancy? Reviewing the evidence. Drug Dev Res. 2010;71:56–68.
McGready R, White NJ, Nosten F. Parasitological efficacy of antimalarials in the treatment and prevention of falciparum malaria in pregnancy 1998 to 2009: a systematic review. BJOG. 2011;118:123–35.
Manyando C, Kayentao K, D’Alessandro U, Okafor HU, Juma E, Hamed K. A systematic review of the safety and efficacy of artemether–lumefantrine against uncomplicated Plasmodium falciparum malaria during pregnancy. Malar J. 2012;11:141.
Burger RJ, van Eijk AM, Bussink M, Hill J, Ter Kuile FO. Artemisinin-based combination therapy versus quinine or other combinations for treatment of uncomplicated Plasmodium falciparum malaria in the second and third trimester of pregnancy: a systematic review and meta-analysis. Open Forum Infect Dis. 2016;3:ofv170.
Brown LD, Cai TT, DasGupta A. Interval estimation for a binomial proportion. Stat Sci. 2001;16:101–17.
Higgins JP, Thompson SG. Quantifying heterogeneity in a meta-analysis. Stat Med. 2002;21:1539–58.
Guyatt G, Oxman AD, Akl EA, Kunz R, Vist G, Brozek J, et al. GRADE guidelines: 1. Introduction—GRADE evidence profiles and summary of findings tables. J Clin Epidemiol. 2011;64:383–94.
McMaster University. GRADEpro GDT: GRADEpro Guideline Development Tool [Software]. 2015. https://gradepro.org . Accessed 10 Feb 2017.
Hunter JP, Saratzis A, Sutton AJ, Boucher RH, Sayers RD, Bown MJ. In meta-analyses of proportion studies, funnel plots were found to be an inaccurate method of assessing publication bias. J Clin Epidemiol. 2014;67:897–903.
Egger M, Davey Smith G, Schneider M, Minder C. Bias in meta-analysis detected by a simple, graphical test. Br Med J. 1997;315:629–34.
Naing T, Win H, Nwe YY. Falciparum malaria and pregnancy: relationship and treatment response. Southeast Asian J Trop Med Public Health. 1988;19:253–8.
Harinasuta T, Kietinun S, Somlaw SB, Somlaw SP, Bunnag D, Sheth UK, et al. A clinical trial of mefloquine on multi-resistant falciparum malaria in pregnant women in Thailand. Bulletin de la Societe Francaise de Parasitologie. 1990:419.
Sowunmi A, Oduola AM, Ogundahunsi OA, Fehintola FA, Ilesanmi OA, Akinyinka OO, et al. Randomised trial of artemether versus artemether and mefloquine for the treatment of chloroquine/sufadoxine–pyrimethamine-resistant falciparum malaria during pregnancy. J Obstet Gynaecol. 1998;18:322–7.
Bounyasong S. Randomized trial of artesunate and mefloquine in comparison with quinine sulfate to treat P. falciparum malaria pregnant women. J Med Assoc Thai. 2001;84:1289–99.
CAS PubMed Google Scholar
McGready R, Brockman A, Cho T, Cho D, van Vugt M, Luxemburger C, et al. Randomized comparison of mefloquine–artesunate versus quinine in the treatment of multidrug-resistant falciparum malaria in pregnancy. Trans R Soc Trop Med Hyg. 2000;94:689–93.
McGready R, Cho T, Samuel Villegas L, Brockman A, van Vugt M, et al. Randomized comparison of quinine–clindamycin versus artesunate in the treatment of falciparum malaria in pregnancy. Trans R Soc Trop Med Hyg. 2001;95:651–6.
McGready R, Ashley EA, Moo E, Cho T, Barends M, Hutagalung R, et al. A randomized comparison of artesunate–atovaquone–proguanil versus quinine in treatment for uncomplicated falciparum malaria during pregnancy. J Infect Dis. 2005;192:846–53.
Adam I, Ibrahim MH, Aelbasit IA, Elbashir MI. Low-dose quinine for treatment of chloroquine-resistant falciparum malaria in Sudanese pregnant women. East Mediterr Health J. 2004;10:554–9.
Kalilani L, Mofolo I, Chaponda M, Rogerson SJ, Alker AP, Kwiek JJ, et al. A randomized controlled pilot trial of azithromycin or artesunate added to sulfadoxine–pyrimethamine as treatment for malaria in pregnant women. PLoS ONE. 2007;2:e1166.
McGready R, Tan SO, Ashley EA, Pimanpanarak M, Viladpai-Nguen J, Phaiphun L, et al. A randomised controlled trial of artemether–lumefantrine versus artesunate for uncomplicated Plasmodium falciparum treatment in pregnancy. PLoS Med. 2008;5:e253.
Mutabingwa TK, Muze K, Ord R, Briceño M, Greenwood BM, Drakeley C, et al. Randomized trial of artesunate + amodiaquine, sulfadoxine–pyrimethamine + amodiaquine, chlorproguanal–dapsone and SP for malaria in pregnancy in Tanzania. PLoS ONE. 2009;4:e5138.
Kaye DK, Nshemerirwe R, Mutyaba TS, Ndeezi G. A randomized clinical trial comparing safety, clinical and parasitological response to artemether–lumefantrine and chlorproguanil–dapsone in treatment of uncomplicated malaria in pregnancy in Mulago hospital, Uganda. J Infect Dev Ctries. 2008;2:135–9.
Piola P, Nabasumba C, Turyakira E, Dhorda M, Lindegardh N, Nyehangane D, et al. Efficacy and safety of artemether–lumefantrine compared with quinine in pregnant women with uncomplicated Plasmodium falciparum malaria: an open-label, randomised, non-inferiority trial. Lancet Infect Dis. 2010;10:762–9.
Carmona-Fonseca J, Agudelo-García OM, Arango-Flórez E. [Therapeutic efficacy and adverse events of treatments for vivax and falciparum malaria in pregnant women in the regions of Uraba and Alto San Jorge, Colombia, 2008–2011] (in Spanish). Rev Colomb Obstet Ginecol. 2013;64:27–37.
Pregact Study Group, Pekyi D, Ampromfi AA, Tinto H, Traoré-Coulibaly M, Tahita MC, et al. Four artemisinin-based treatments in African pregnant women with malaria. N Engl J Med. 2016;374:913–27.
Nambozi M, Kabuya J-BB, Hachizovu S, Mwakazanga D, Mulenga J, Kasongo W, et al. Artemisinin-based combination therapy in pregnant women in Zambia: efficacy, safety and risk of recurrent malaria. Malar J. 2017;16:199.
Osarfo J, Tagbor H, Cairns M, Alifrangis M, Magnussen P. Dihydroartemisinin–piperaquine versus artesunate–amodiaquine for treatment of malaria infection in pregnancy in Ghana: an open-label, randomised, non-inferiority trial. Trop Med Int Health. 2017;22:1043–52.
Onyamboko MA, Fanello CI, Turner G, Jackson N, Tarning J, Nosten F, et al. Comparison of two regimens of artemether–lumefantrine for the treatment of uncomplicated Plasmodium falciparum malaria in pregnant women in the Democratic Republic of Congo. Am J Trop Med Hyg. 2015;93(4 Supplement):6.
Ukah M, Badejoko O, Ogunniyi S, Loto O, Aboderin O, Fatusi A. A randomized trial of artesunate–amodiaquine versus artemether–lumefantrine for the treatment of acute uncomplicated malaria in pregnancy. Int J Gynaecol Obstet. 2015;131:41–4.
Iribhogbe OI, Emmanuel I, Odianosen M. Comparative analysis of the safety and tolerability of fixed-dose artesunate/amodiaquine versus artemether/lumefantrine combinations for uncomplicated falciparum malaria in pregnancy: a randomized open label study. Clin Pharmacol. 2017;9:45–54.
PubMed PubMed Central Google Scholar
Anvikar A. Effective and safe treatment for malaria in pregnancy in India: a randomised controlled trial (CTRI/2009/091/001055). 2010.
McGready R. Randomised trial of 3 artemisinin combination therapy for malaria in pregnancy (NCT01054248). 2010.
McGready R, Stepniewska K, Edstein MD, Cho T, Gilveray G, Looareesuwan S, et al. The pharmacokinetics of atovaquone and proguanil in pregnant women with acute falciparum malaria. Eur J Clin Pharmacol. 2003;59:545–52.
Adam I, Tarning J, Lindegardh N, Mahgoub H, McGready R, Nosten F. Pharmacokinetics of piperaquine in pregnant women in Sudan with uncomplicated Plasmodium falciparum malaria. Am J Trop Med Hyg. 2012;87:35–40.
Onyamboko MA, Meshnick SR, Fleckenstein L, Koch MA, Atibu J, Lokomba V, et al. Pharmacokinetics and pharmacodynamics of artesunate and dihydroartemisinin following oral treatment in pregnant women with asymptomatic Plasmodium falciparum infections in Kinshasa DRC. Malar J. 2011;10:49.
McGready R, Phyo AP, Rijken MJ, Tarning J, Lindegardh N, Hanpithakpon W, et al. Artesunate/dihydroartemisinin pharmacokinetics in acute falciparum malaria in pregnancy: absorption, bioavailability, disposition and disease effects. Br J Clin Pharmacol. 2012;73:467–77.
Rijken MJ, McGready R, Phyo AP, Lindegardh N, Tarning J, Laochan N, et al. Pharmacokinetics of dihydroartemisinin and piperaquine in pregnant and nonpregnant women with uncomplicated falciparum malaria. Antimicrob Agents Chemother. 2011;55:5500–6.
Valea I, Tinto H, Traore-Coulibaly M, Toe LC, Lindegardh N, Tarning J, et al. Pharmacokinetics of co-formulated mefloquine and artesunate in pregnant and non-pregnant women with uncomplicated Plasmodium falciparum infection in Burkina Faso. J Antimicrob Chemother. 2014;69:2499–507.
Juma EA, Ogutu BR, Oloo F, Barwa T, Aman R. Pharmacokinetics of artemether–lumefantrine in pregnant and non-pregnant women with uncomplicated Plasmodium falciparum malaria in western Kenya. Am J Trop Med Hyg. 2014;91(5 Supplement):587.
Mosha D, Guidi M, Mwingira F, Abdulla S, Mercier T, Decosterd LA, et al. Population pharmacokinetics and clinical response for artemether–lumefantrine in pregnant and nonpregnant women with uncomplicated Plasmodium falciparum malaria in Tanzania. Antimicrob Agents Chemother. 2014;58:4583–92.
Nyunt MM, Nguyen VK, Kajubi R, Huang L, Ssebuliba J, Kiconco S, et al. Artemether–lumefantrine pharmacokinetics and clinical response are minimally altered in pregnant Ugandan women treated for uncomplicated falciparum malaria. Antimicrob Agents Chemother. 2016;60:1274–82.
Article CAS PubMed Central Google Scholar
Mutagonda RF, Kamuhabwa AAR, Minzi OMS, Massawe SN, Maganda BA, Aklillu E. Malaria prevalence, severity and treatment outcome in relation to day 7 lumefantrine plasma concentration in pregnant women. Malar J. 2016;15:278.
Mutagonda RF, Kamuhabwa AAR, Minzi OMS, Massawe SN, Asghar M, Homann MV, et al. Effect of pharmacogenetics on plasma lumefantrine pharmacokinetics and malaria treatment outcome in pregnant women. Malar J. 2017;16:267.
Adam I, Idris HM, Elbashir MI. Quinine for chloroquine-resistant falciparum malaria in pregnant Sudanese women in the first trimester. East Mediterr Health J. 2004;10:560–5.
Adam I, Elwasila E, Mohammed Ali DA, Elansari E, Elbashir MI. Artemether in the treatment of falciparum malaria during pregnancy in eastern Sudan. Trans R Soc Trop Med Hyg. 2004;98:509–13.
Adegnika AA, Breitling LP, Agnandji ST, Chai SK, Schütte D, Oyakhirome S, et al. Effectiveness of quinine monotherapy for the treatment of Plasmodium falciparum infection in pregnant women in Lambaréné, Gabon. Am J Trop Med Hyg. 2005;73:263–6.
Adam I, Ali DM, Abdalla MA. Artesunate plus sulfadoxine–pyrimethamine in the treatment of uncomplicated Plasmodium falciparum malaria during pregnancy in eastern Sudan. Trans R Soc Trop Med Hyg. 2006;100:632–5.
Ndiaye JL, Ndiaye A, Faye B, Ba M, Tine R, Ndiaye D, et al. Open-label in vivo drug study to evaluate the safety and efficacy of artesunate plus amodiaquine combination in pregnant women with uncomplicated P. falciparum malaria in Senegal. Trop Med Int Health. 2011;16(Supplement 1):140.
Iribhogbe OI, Igue EO, Odianosen M. Assessment of the safety of non-fixed-dose combination of artesunate and amodiaquine for uncomplicated falciparum malaria in pregnancy: a nonrandomized open-label study. J Pharm Health Serv Res. 2017;8:31–8.
Article Google Scholar
McGready R, Cho T, Cho JJ, Simpson JA, Luxemburger C, Dubowitz L, et al. Artemisinin derivatives in the treatment of falciparum malaria in pregnancy. Trans R Soc Trop Med Hyg. 1998;92:430–3.
McGready R, Cho T, Hkirijaroen L, Simpson J, Chongsuphajaisiddhi T, White NJ, et al. Quinine and mefloquine in the treatment of multidrug-resistant Plasmodium falciparum malaria in pregnancy. Ann Trop Med Parasitol. 1998;92:643–53.
McGready R, Cho T, Keo NK, Thwai KL, Villegas L, Looareesuwan S, et al. Artemisinin antimalarials in pregnancy: a prospective treatment study of 539 episodes of multidrug-resistant Plasmodium falciparum . Clin Infect Dis. 2001;33:2009–16.
Laochan N, Zaloumis SG, Imwong M, Lek-Uthai U, Brockman A, Sriprawat K, et al. Intervals to Plasmodium falciparum recurrence after anti-malarial treatment in pregnancy: a longitudinal prospective cohort. Malar J. 2015;14:221.
McGready R, Thwai KL, Cho T, Samuel Looareesuwan S, White NJ, et al. The effects of quinine and chloroquine antimalarial treatments in the first trimester of pregnancy. Trans R Soc Trop Med Hyg. 2002;96:180–4.
McGready R, Keo NK, Villegas L, White NJ, Looareesuwan S, Nosten F. Artesunate–atovaquone–proguanil rescue treatment of multidrug-resistant Plasmodium falciparum malaria in pregnancy: a preliminary report. Trans R Soc Trop Med Hyg. 2003;97:592–4.
Villegas L, Hernandez N, Vasquez C, Veliz F, Guevara M-E, Salazar B, et al. Treatment of multi drug-resistant falciparum malaria during pregnancy with mefloquine–artesunate in Venezuela: preliminary results. Am J Trop Med Hyg. 2005;73(6 Supplement):225.
Rijken MJ, McGready R, Boel ME, Barends M, Proux S, Pimanpanarak M, et al. Dihydroartemisinin–piperaquine rescue treatment of multidrug-resistant Plasmodium falciparum malaria in pregnancy: a preliminary report. Am J Trop Med Hyg. 2008;78:543–5.
Rulisa S, Kaligirwa N, Agaba S, Karema C, Mens PF, de Vries PJ. Pharmacovigilance of artemether–lumefantrine in pregnant women followed until delivery in Rwanda. Malar J. 2012;11:225.
Kalilani-Phiri L, Thesing PC, Nyirenda OM, Mawindo P, Madanitsa M, Membe G, et al. Timing of malaria infection during pregnancy has characteristic maternal, infant and placental outcomes. PLoS ONE. 2013;8:e74643.
Cohee LM, Kalilani-Phiri L, Mawindo P, Joshi S, Adams M, Kenefic L, et al. Parasite dynamics in the peripheral blood and the placenta during pregnancy-associated malaria infection. Malar J. 2016;15:483.
Ismail MR, Ordi J, Menendez C, Ventura PJ, Aponte JJ, Kahigwa E, et al. Placental pathology in malaria: a histological, immunohistochemical, and quantitative study. Hum Pathol. 2000;31:85–93.
Muehlenbachs A, Fried M, McGready R, Harrington WE, Mutabingwa TK, Nosten F, et al. A novel histological grading scheme for placental malaria applied in areas of high and low malaria transmission. J Infect Dis. 2010;202:1608–16.
Bulmer JN, Rasheed FN, Francis N, Morrison L, Greenwood BM. Placental malaria. I. Pathological classification. Histopathology. 1993;22:211–8.
Rogerson SJ, Mkundika P, Kanjala MK. Diagnosis of Plasmodium falciparum malaria at delivery: comparison of blood film preparation methods and of blood films with histology. J Clin Microbiol. 2003;41:1370–4.
Kloprogge F, Piola P, Dhorda M, Muwanga S, Turyakira E, Apinan S, et al. Population pharmacokinetics of lumefantrine in pregnant and nonpregnant women with uncomplicated Plasmodium falciparum malaria in Uganda. CPT Pharmacometrics Syst Pharmacol. 2013;2:e83.
McGready R, Stepniewska K, Lindegardh N, Ashley EA, La Y, Singhasivanon P, et al. The pharmacokinetics of artemether and lumefantrine in pregnant women with uncomplicated falciparum malaria. Eur J Clin Pharmacol. 2006;62:1021–31.
Tarning J, Kloprogge F, Dhorda M, Jullien V, Nosten F, White NJ, et al. Pharmacokinetic properties of artemether, dihydroartemisinin, lumefantrine, and quinine in pregnant women with uncomplicated Plasmodium falciparum malaria in Uganda. Antimicrob Agents Chemother. 2013;57:5096–103.
Tarning J, McGready R, Lindegardh N, Ashley EA, Pimanpanarak M, Kamanikom B, et al. Population pharmacokinetics of lumefantrine in pregnant women treated with artemether–lumefantrine for uncomplicated Plasmodium falciparum malaria. Antimicrob Agents Chemother. 2009;53:3837–46.
Hutagalung R, Paiphun L, Ashley EA, McGready R, Brockman A, Thwai KL, et al. A randomized trial of artemether–lumefantrine versus mefloquine–artesunate for the treatment of uncomplicated multi-drug resistant Plasmodium falciparum on the western border of Thailand. Malar J. 2005;4:46.
Vugt MV, Wilairatana P, Gemperli B, Gathmann I, Phaipun L, Brockman A, et al. Efficacy of six doses of artemether–lumefantrine (benflumetol) in multidrug-resistant Plasmodium falciparum malaria. Am J Trop Med Hyg. 1999;60:936–42.
Woodrow CJ, White NJ. The clinical impact of artemisinin resistance in Southeast Asia and the potential for future spread. FEMS Microbiol Rev. 2017;41:34–48.
Moore KA, Simpson JA, Wiladphaingern J, Min AM, Pimanpanarak M, Paw MK, et al. Influence of the number and timing of malaria episodes during pregnancy on prematurity and small-for-gestational-age in an area of low transmission. BMC Med. 2017;15:117.
Rogerson SJ, Hviid L, Duffy PE, Leke RF, Taylor DW. Malaria in pregnancy: pathogenesis and immunity. Lancet Infect Dis. 2007;7:105–17.
Costantine MM. Physiologic and pharmacokinetic changes in pregnancy. Front Pharmacol. 2014;5:65.
Ward SA, Sevene EJ, Hastings IM, Nosten F, McGready R. Antimalarial drugs and pregnancy: safety, pharmacokinetics, and pharmacovigilance. Lancet Infect Dis. 2007;7:136–44.
Stepniewska K, Taylor WR, Mayxay M, Price R, Smithuis F, Guthmann JP, et al. In vivo assessment of drug efficacy against Plasmodium falciparum malaria: duration of follow-up. Antimicrob Agents Chemother. 2004;48:4271–80.
Mayor A, Serra-Casas E, Bardají A, Sanz S, Puyol L, Cisteró P, et al. Sub-microscopic infections and long-term recrudescence of Plasmodium falciparum in Mozambican pregnant women. Malar J. 2009;8:9.
Stepniewska K, White NJ. Some considerations in the design and interpretation of antimalarial drug trials in uncomplicated falciparum malaria. Malar J. 2006;5:127.
Moore KA, Simpson JA, Thomas KH, Rijken MJ, White LJ, Lu Moo Dwell S, et al. Estimating gestational age in late presenters to antenatal care in a resource-limited setting on the Thai–Myanmar border. PLoS ONE. 2015;10:e0131025.
McGready R, Davison BB, Stepniewska K, Cho T, Shee H, Brockman A, et al. The effects of Plasmodium falciparum and P. vivax infections on placental histopathology in an area of low malaria transmission. Am J Trop Med Hyg. 2004;70:398–407.
PubMed Google Scholar
Saito M, Gilder ME, Nosten F, Guérin PJ, McGready R. Methodology of assessment and reporting of safety in anti-malarial treatment efficacy studies of uncomplicated falciparum malaria in pregnancy: a systematic literature review. Malar J. 2017. https://doi.org/10.1186/s12936-017-2136-x
Malaria in Pregnancy Treatment Efficacy Study Group (WorldWide Antimalarial Resistance Network). Assessing the efficacy of a range of antimalarials used for the treatment of P. falciparum malaria in all trimesters of pregnancy in Africa and Asia. 2016. http://www.wwarn.org/working-together/study-groups/malaria-pregnancy-treatment-efficacy-study-group . Accessed 10 Feb 2017.
Download references
Authors’ contributions
MS and MEG did literature search. MS analysed the extracted information and wrote the first draft of the manuscript. MEG, FN, RM and PJG contributed significantly to the writing of the manuscript. All authors read and approved the final manuscript.
Acknowledgements
We would like to thank Prabin Dahal for his valuable advice particularly regarding statistical analyses. Finally, the authors thank all the healthcare workers and pregnant women who contributed to this body of research.
Competing interests
The authors declare that they have no competing interests.
Availability of data and materials
The extracted data will be available at WWARN website ( http://www.wwarn.org/ ).
Consent for publication
Not applicable.
Ethics approval and consent to participate
WWARN is supported by the Bill & Melinda Gates Foundation. SMRU is part of the Mahidol Oxford University Research Unit supported by the Wellcome Trust of Great Britain. MS is currently supported by the University of Oxford Clarendon Fund. The funding bodies do not have roles in this review.
Publisher’s Note
Springer Nature remains neutral with regard to jurisdictional claims in published maps and institutional affiliations.
Author information
Authors and affiliations.
WorldWide Antimalarial Resistance Network (WWARN), Oxford, UK
Makoto Saito & Philippe J. Guérin
Centre for Tropical Medicine and Global Health, Nuffield Department of Medicine, University of Oxford, Old Road Campus, Roosevelt Drive, Oxford, OX3 7FZ, UK
Makoto Saito, François Nosten, Rose McGready & Philippe J. Guérin
Shoklo Malaria Research Unit (SMRU), Mahidol-Oxford Tropical Medicine Research Unit, Faculty of Tropical Medicine, Mahidol University, Mae Sot, Tak, Thailand
Makoto Saito, Mary Ellen Gilder, François Nosten & Rose McGready
You can also search for this author in PubMed Google Scholar
Corresponding author
Correspondence to Makoto Saito .
Additional files
Additional file 1. search terms for literature review., additional file 2. prisma flowchart., additional file 3. summary of the study design and reported outcomes., additional file 4. summary of the quality of studies., additional file 5. summary of treatment administration and interruption., additional file 6. the number of study arms with pcr-corrected outcomes for each comparison of drugs., additional file 7. background information of patients at inclusion., additional file 8. summary of gametocyte carriage., additional file 9. funnel plots by quinine-based and artemisinin-based treatments., additional file 10. the pcr-uncorrected proportional adequate clinical and parasitological response (acpr)., additional file 11. summary of evidence profile comparing artemisinin-based and quinine-based treatment., 12936_2017_2135_moesm12_esm.pdf.
Additional file 12. Funnel plot of odds ratio of PCR-corrected treatment failure comparing quinine-based and artemisinin-based treatments.
Additional file 13. The methodology of assessing placental malaria.
Rights and permissions.
Open Access This article is distributed under the terms of the Creative Commons Attribution 4.0 International License ( http://creativecommons.org/licenses/by/4.0/ ), which permits unrestricted use, distribution, and reproduction in any medium, provided you give appropriate credit to the original author(s) and the source, provide a link to the Creative Commons license, and indicate if changes were made. The Creative Commons Public Domain Dedication waiver ( http://creativecommons.org/publicdomain/zero/1.0/ ) applies to the data made available in this article, unless otherwise stated.
Reprints and permissions
About this article
Cite this article.
Saito, M., Gilder, M.E., Nosten, F. et al. Systematic literature review and meta-analysis of the efficacy of artemisinin-based and quinine-based treatments for uncomplicated falciparum malaria in pregnancy: methodological challenges. Malar J 16 , 488 (2017). https://doi.org/10.1186/s12936-017-2135-y
Download citation
Received : 23 October 2017
Accepted : 05 December 2017
Published : 13 December 2017
DOI : https://doi.org/10.1186/s12936-017-2135-y
Share this article
Anyone you share the following link with will be able to read this content:
Sorry, a shareable link is not currently available for this article.
Provided by the Springer Nature SharedIt content-sharing initiative
- Artemisinin
- Methodology
Malaria Journal
ISSN: 1475-2875
- Submission enquiries: [email protected]
- Advanced Searches
- Legislation
- Congressional Record
- Search Tools
- Browse the Help Center
Examples: "Trade Relations", "Export Controls"
Examples: hr5, h.r.5, sjres8, sa2, pl116-21, 86Stat1326
Examples: trade sanctions reform, small modular reactor
Examples: hr5, h.r.5, sjres8, s2, 90stat2495
Examples: baseball, "standing rules"
Examples: 5, 20, 37
Examples: hr5021, H.Res.866, sconres15, S.51, 117pl2, 117-2
Examples: "enrolled bill signed", "leak detection dog"
Examples: "diplomatic service", retired
Examples: PN4, pn12, pn1633-2, 118PN345
Examples: Morris, Beck
Examples: general, "deputy under secretary"
Examples: judiciary, "Coast Guard"
Examples: marine mammals, "5 U.S.C. 801", "Presidential Address"
Example: peace corps
Examples: EC6228, r12313, PM45, PT83, ML160
Example: 5 U.S.C. 801
Examples: "trade relations", "Export Control Act"
Examples: EC2, PM32, POM43
Examples: UNESCO, "sea turtles"
Examples: 115-3, 114-13(A)
Example: 106-1
S. Rept. 118-207 - DEPARTMENTS OF LABOR, HEALTH AND HUMAN SERVICES, AND EDUCATION, AND RELATED AGENCIES APPROPRIATION BILL, 2025 118th Congress (2023-2024)
Committee report.
| Report Type: | Senate Report |
|---|---|
| Accompanies: | |
| Committees: |
Report text available as:
- PDF (1MB) (PDF provides a complete and accurate display of this text.) Tip ?
Information
- Author Services
Initiatives
You are accessing a machine-readable page. In order to be human-readable, please install an RSS reader.
All articles published by MDPI are made immediately available worldwide under an open access license. No special permission is required to reuse all or part of the article published by MDPI, including figures and tables. For articles published under an open access Creative Common CC BY license, any part of the article may be reused without permission provided that the original article is clearly cited. For more information, please refer to https://www.mdpi.com/openaccess .
Feature papers represent the most advanced research with significant potential for high impact in the field. A Feature Paper should be a substantial original Article that involves several techniques or approaches, provides an outlook for future research directions and describes possible research applications.
Feature papers are submitted upon individual invitation or recommendation by the scientific editors and must receive positive feedback from the reviewers.
Editor’s Choice articles are based on recommendations by the scientific editors of MDPI journals from around the world. Editors select a small number of articles recently published in the journal that they believe will be particularly interesting to readers, or important in the respective research area. The aim is to provide a snapshot of some of the most exciting work published in the various research areas of the journal.
Original Submission Date Received: .
- Active Journals
- Find a Journal
- Proceedings Series
- For Authors
- For Reviewers
- For Editors
- For Librarians
- For Publishers
- For Societies
- For Conference Organizers
- Open Access Policy
- Institutional Open Access Program
- Special Issues Guidelines
- Editorial Process
- Research and Publication Ethics
- Article Processing Charges
- Testimonials
- Preprints.org
- SciProfiles
- Encyclopedia

Article Menu

- Subscribe SciFeed
- Recommended Articles
- Google Scholar
- on Google Scholar
- Table of Contents
Find support for a specific problem in the support section of our website.
Please let us know what you think of our products and services.
Visit our dedicated information section to learn more about MDPI.
JSmol Viewer
A multidisciplinary update on treatment modalities for metastatic spinal tumors with a surgical emphasis: a literature review and evaluation of the role of artificial intelligence.

Simple Summary
Share and cite.
Houston, R.; Desai, S.; Takayanagi, A.; Quynh Thu Tran, C.; Mortezaei, A.; Oladaskari, A.; Sourani, A.; Siddiqi, I.; Khodayari, B.; Ho, A.; et al. A Multidisciplinary Update on Treatment Modalities for Metastatic Spinal Tumors with a Surgical Emphasis: A Literature Review and Evaluation of the Role of Artificial Intelligence. Cancers 2024 , 16 , 2800. https://doi.org/10.3390/cancers16162800
Houston R, Desai S, Takayanagi A, Quynh Thu Tran C, Mortezaei A, Oladaskari A, Sourani A, Siddiqi I, Khodayari B, Ho A, et al. A Multidisciplinary Update on Treatment Modalities for Metastatic Spinal Tumors with a Surgical Emphasis: A Literature Review and Evaluation of the Role of Artificial Intelligence. Cancers . 2024; 16(16):2800. https://doi.org/10.3390/cancers16162800
Houston, Rebecca, Shivum Desai, Ariel Takayanagi, Christina Quynh Thu Tran, Ali Mortezaei, Alireza Oladaskari, Arman Sourani, Imran Siddiqi, Behnood Khodayari, Allen Ho, and et al. 2024. "A Multidisciplinary Update on Treatment Modalities for Metastatic Spinal Tumors with a Surgical Emphasis: A Literature Review and Evaluation of the Role of Artificial Intelligence" Cancers 16, no. 16: 2800. https://doi.org/10.3390/cancers16162800
Article Metrics
Article access statistics, further information, mdpi initiatives, follow mdpi.

Subscribe to receive issue release notifications and newsletters from MDPI journals
An official website of the United States government
The .gov means it’s official. Federal government websites often end in .gov or .mil. Before sharing sensitive information, make sure you’re on a federal government site.
The site is secure. The https:// ensures that you are connecting to the official website and that any information you provide is encrypted and transmitted securely.
- Publications
- Account settings
Preview improvements coming to the PMC website in October 2024. Learn More or Try it out now .
- Advanced Search
- Journal List
- HHS Author Manuscripts

An Overview of Malaria in Pregnancy
Melissa bauserman.
1 Department of Pediatrics, University of North Carolina School of Medicine, Chapel Hill, NC
Andrea L Conroy
2 Department of Pediatrics, Indiana University School of Medicine, Indianapolis, IN
Krysten North
3 Department of Pediatrics, University of North Carolina School of Medicine, Chapel Hill, NC
Jackie Patterson
4 Department of Pediatrics, University of North Carolina School of Medicine, Chapel Hill, NC
5 Department of Pediatrics, University of North Carolina School of Medicine, Chapel Hill, NC
Steve Meshnick
6 Department of Epidemiology, University of North Carolina Gilligns School of Global Public Health, Chapel Hill, NC
One hundred twenty-five million pregnant women are at risk for contracting malaria, a preventable cause of maternal and infant morbidity and death. Malaria parasites contribute to adverse pregnancy and birth outcomes due to their preferential accumulation in placental intervillous spaces. Pregnant women are particularly vulnerable to malaria infections, and malaria infections during pregnancy put their fetuses at risk. Malaria in pregnancy is associated with anemia, stillbirth, low birth weight and maternal and fetal death. We review the challenges to diagnosing malaria in pregnancy, as well as strategies to prevent and treat malaria in pregnancy. Finally, we discuss the current gaps in knowledge and potential areas for continued research.
Introduction
Globally, an estimated 125 million pregnant women reside in areas where they are at risk of contracting malaria in pregnancy (MIP), and MIP remains an important preventable cause of adverse birth outcomes. 1 Although there are five species of malaria that infect humans, two main species of Plasmodium contribute to adverse maternal and fetal outcomes in pregnancy, P. falciparum and P. vivax. In sub-Saharan Africa, where the majority of adverse birth outcomes attributable to malaria occur, P. falciparum is the dominant species. However, over half of pregnancies that are potentially exposed to malaria occur in Southeast Asia and the Western Pacific where P. falciparum and P. vivax coexist. Co-existence of P. falciparum and P. vivax also occurs in South America, where 3% of the global total of women at risk for MIP reside. 1
Over the past decade, there has been significant progress in reducing the global prevalence of P. falciparum , particularly in Africa. However, women remain at high risk of MIP, with over 50% of women in high transmission areas having P. falciparum detected in peripheral blood at presentation to antenatal care. 2 , 3 This high prevalence of disease results from an increased risk of contracting malaria among pregnant compared to non-pregnant women. Women who are younger, malnourished, primigravidae/secundigravidae, lack immunity to pregnancy-associated malaria, or living with HIV are at the highest risk of malaria-associated adverse pregnancy outcomes. 4 , 5
Pathophysiology of Malaria in Pregnancy
MIP contributes to adverse pregnancy outcomes, at least in part, due to the preferential accumulation of parasites in the placental intervillous space. Placental sequestration is common in infections with P. falciparum because malaria parasites export a protein, VAR2CSA, to the red blood cell membrane that facilitates adherence to chondroitin-sulfate A (CSA) on syndecan-1, which is anchored in placental tissue. 6 This interaction is associated with the recruitment, retention and activation of mononuclear cells in the placenta—and is thought to mediate malaria’s effect on birth outcomes. 7 Maternal antibodies against VAR2CSA are protective. 5 P. vivax can also lead to placental changes, but to date no studies have unequivocally documented the sequestration of P. vivax infected erythrocytes in the placenta. 8
A number of histological changes in P. falciparum infected placentae have been described, including the infiltration of mononuclear cells, deposition of malaria pigment, thickening of the trophoblast basement membrane, syncytial knotting, and complement deposition. 9 – 11 Inflammation in the placenta has been linked to impaired transplacental transport of glucose 12 and amino acids, 13 and disruption of the insulin-like growth hormone axis. 14 Impaired nutrient transport across the placenta may be further exacerbated by altered placental angiogenesis 15 leading to changes in both the villous architecture 16 and surface area for nutrient exchange, as well as impaired uteroplacental blood flow. 15 , 17 These histologic and functional changes likely contribute to impaired fetal growth. Longitudinal Doppler data support the idea that malaria in the first half of pregnancy can lead to changes in umbilical artery blood flow and fetal growth in pregnancy, and this is affected by both gravidity and nutritional status. 18
Risk Factors for Malaria in Pregnancy
Environmental, parasite, and maternal factors influence the severity of MIP. In areas where malaria transmission is high, the primary burden of malaria is in primigravidae, whereas, in areas of low transmission, all gravidities are at risk. In areas of high transmission, primigravidae develop antibodies to VAR2CSA protein produced by malaria parasites, and are partially protected during subsequent pregnancies; this tends not to happen in areas of low transmission. 19 Overall, pregnant women living in areas with low or unstable (episodic) transmission have little or no immunity to malaria and are at a two-to-three times higher risk of severe disease compared to non-pregnant controls. 20 P. falciparum has typically been associated with more severe MIP than P. vivax , although P. vivax is more likely to occur in a mother with little acquired immunity. 21 Maternal age and gravidity also play a role in the severity of MIP. Younger mothers are at greater risk for severe malaria infection compared to older mothers, who appear to have some protection from severe disease. 4 In high transmission areas, such as sub-Saharan Africa, primigravidae and secundigravidae are at greater risk for severe malaria infection compared to multigravidae, but this is not true in areas of low transmission, where multigravidae have not had prior malaria exposure nor developed immunity. 22
Malnourished pregnant women are at increased risk for adverse birth outcomes with MIP. 23 A meta-analysis using individual patient data from 14,633 pregnancies from Africa and the Western Pacific between 1996–2015 showed that malaria and malnutrition are common exposures, with 35% of women having either of those exposures. Pregnant women with malnutrition and malaria were at an increased risk of LBW compared to women with only 1 of those risk factors. 24 Recent data suggests reduced L-arginine intake is one mechanism through which malnutrition contributes to low birth weight with both nutritional survey data 25 and preclinical models 26 suggesting that L-arginine supplementation may reduce preterm birth 25 and increase fetal viability, placental vascularization, and birth weight. 26
Burden of Malaria
Maternal effects.
The clinical effects of malaria on pregnant women vary from no symptoms to severe anemia and death. Women living in areas of low malaria transmission who have a lower degree of acquired immunity are more likely to experience complications such as renal failure, pulmonary edema, and cerebral malaria. 27 Despite this, the overall maternal mortality rate is similar in low-transmission areas (0.6–12.5%) compared to malaria-endemic areas (0.5–23%). 4 More research is warranted on the topic of malaria-related mortality during pregnancy, as the current data are limited and inconsistent.
Maternal anemia is one of the most common symptoms of MIP. Plasmodium causes anemia through hemolysis, increased splenic clearance of erythrocytes, and reduced red blood cell production. While severe anemia during pregnancy (hemoglobin <7 g/dL) is often multifactorial with significant nutritional components, malaria can play an important role. 28 In one estimate in sub-SaharanAfrica, the population attributable fraction of malaria to severe anemia during pregnancy was 26%. 4 For endemic areas with a 5% baseline prevalence of severe anemia, epidemiological modeling predicts malaria-induced anemia to contribute to nine maternal deaths per 100,000 live births. 4 However, in a population-based study in the Democratic Republic of the Congo, malaria played little or no role as a driver of anemia during pregnancy. 29
Pregnant women are three times more likely to be affected by severe malaria. 30 The World Health Organization defines severe malaria as parasitemia with evidence of end organ dysfunction ( Table 1 ). The presenting features of severe malaria can include severe anemia, hypoglycemia, acute respiratory distress syndrome, renal failure and cerebral malaria. 30 The median mortality of severe MIP is 39% (range 8–100%). 30 Severe malaria must be treated promptly with intensive care and parenteral antimalarial medication to reduce mortality. 31
Treatment Strategies for MIP
| Symptoms of malaria and positive parasitological test (microscopy or RDT) but no features of severe malaria | Parasitemia and one of the following (not caused by another etiology): 1) Impaired consciousness 2) Prostration 3) Multiple convulsions 4) Acidosis 5) Hypoglycemia 6) Severe malarial anemia (Hemoglobin <7 g/dL) 7) Renal Impairment 8) Jaundice 9) Pulmonary Edema 10) Significant bleeding 11) Shock 12) ( only) Hyperparasitemia >10% | ||
| Quinine and clindamycin x 7 days | Artemisinin-based combination therapy (ACT) for 3 days, Options include 1) artemether + lumefantrine 2) artesunate + amodiaquine 3) artesunate + mefloquine 4) artesunate + SP 5) dihydroartemisinin + piperaquine | IV or IM artesunate at least 24 hours then ACT for 3 days Add primaquine in areas of low-transmission | |
| Chloroquine or quinine Add weekly chemoprophylaxis with chloroquine through pregnancy and breastfeeding Add Post-delivery/lactating: treatment with primaquine x 14 days | ACT or Chloroquine ACT Add weekly chemoprophylaxis with chloroquine through pregnancy and breastfeeding Add Post-delivery/lactating: treatment with primaquine x 14 days | ||
Fetal Effects
Malaria is an important cause of stillbirth throughout endemic areas ( Figure 1 ). MIP contributes to 12–20% of stillbirths in endemic regions of sub-Saharan Africa, with lower rates if the mother undergoes treatment. 32 P. falciparum detection both in peripheral blood samples or placental samples at delivery nearly doubles the odds of stillbirth (odds ratio 1.81 and 1.5, respectively). 32 Stillbirth risk is higher in areas with low to intermediate endemicity compared to areas of high endemicity. 33 The risk of stillbirth can be modified with appropriate malaria intervention efforts. For example, the use of insecticide-treated bed nets (ITN) is associated with lower rates of placental malaria and stillbirth (risk ratio 0.67 [95% CI 0.45 to 1.00] for stillbirth). 34

IUGR = Intrauterine growth retardation. Reprinted with permission ( 4 ).
MIP increases the risk of low birth weight (LBW), and approximately 20% of cases of LBW in malaria-endemic areas are attributed to placental infection with malaria ( Figure 1 ). 35 A mother with a malaria-infected placenta is twice as likely to have a baby with LBW. 36 LBW in turn is associated with higher infant mortality rates. In Africa, LBW has been associated with a three - to 20-fold increase in the probability of infant mortality. 36 , 37 Parity is an important factor in LBW. Primigravidae with MIP have two to seven higher odds of LBW and mortality than multigravidae. 38 The timing of infection also seems to play a role in infant size. Second-trimester infection is more likely to result in LBW than third-trimester infection; but data on first-trimester infection are limited. 39
MIP causes LBW due to both intrauterine growth restriction (IUGR) and prematurity. Up to 70% of IUGR in endemic areas is due to malaria, presumably as a result of impaired oxygen and nutrient delivery to the fetus. 35 , 36 The contribution of malaria to preterm birth is also substantial, with up to 36% of prematurity in malaria-endemic areas attributable to Plasmodium infection. Prematurity may result from the host’s immune response to malaria parasites triggering early labor. 33 These adverse fetal effects are species specific, as P. ovale and P. malariae species are not associated with adverse birth outcomes.
Congenital Malaria
Congenital malaria is defined as the identification of asexual P. falciparum parasites in the cord blood or peripheral blood of an infant during the first 7 days of life. 40 The true prevalence of congenital malaria is uncertain. While the prevalence was previously thought to be between <1% and 6%, 40 more recent studies have demonstrated a prevalence rate up to 33% in high-endemicity areas; but it is not clear how many of these congenital infections persist and cause clinical illness. 41 Most descriptive reports of congenital malaria are from infants who are born in non-endemic areas to mothers with a history of travel to endemic areas. Infant symptoms include fever associated with hepatosplenomegaly, hemolytic anemia, thrombocytopenia, and feeding intolerance. 41 These infants often become symptomatic between 10 and 30 days of life, although they can present later. Their symptoms may progress rapidly and can be fatal. 27 , 42 Because, much of the literature on congenital malaria is derived from case reports, more research is needed to better understand the epidemiology and pathophysiology of congenital malaria.
Effects in Early Childhood
Offspring are affected by placental malaria into childhood, ( Figure 1 ). Prenatal malaria exposure is associated with an increased risk of early malaria infection in children as young as four to six months of age. 40 Placental parasitemia may increase the risk of malaria infections in infancy and childhood through several mechanisms. For example, MIP might interfere with maternal antibody passage to offspring, compromising the immunity of the fetus and newborn, making the offspring vulnerable to early malaria infections. 40 In utero exposure to malaria induces the development of T reg cells that lead to fetal immune tolerance to malaria antigens that persists into childhood. 43 Placental malaria has been associated with subsequent susceptibility to non-malaria infections, including measles and tetanus, suggesting additional effects on infant immunity that may be due to the obstruction of antibody passage across the placenta. 44 Acute placental malaria infection has been associated with increased one-year mortality in infants 45 and decreased length and weight gain in the first year of life. 46 , 47 MIP is also associated with anemia during infancy and the infant’s risk for anemia with maternal peripheral parasitemia at delivery is 11.8% and 9.2% with placental malaria infection. 48
The diagnosis of MIP can be challenging due to placental sequestration of parasitized erythrocytes, low circulating levels of parasites and limited resources in malaria endemic areas for advanced diagnostic techniques. Microscopic identification of malaria from the blood by an experienced and well-equipped technician remains the gold standard for malaria diagnosis. 49 However, rapid diagnostic tests (RDTs) that test for malaria antigens, like histidine-rich protein-1 (PfHRP2), are another option for malaria diagnosis. 49 – 51 RDTs are easier than microscopy to perform in low-resource settings, because they are not dependent on highly trained technicians in well-equipped laboratories. Therefore, RDTs might be the most appropriate point of care testing among symptomatic mothers in low-resource settings. 31 , 50 However, the use of RDTs might be insufficient in diagnosing MIP among mothers with asymptomatic infection, because RDTs require a higher circulating parasite burden than microscopy for detection. 52 RDTs are also insufficient to detect low amounts of circulating parasites because of placental sequestration. In research studies, the gold standard for malaria diagnosis has been placental histopathology, but it is not practical in many field sites. 53 , 54 Using microscopy of placental blood as the referent, the sensitivity of RDTs is 81% (95% CI 55–93) and the specificity is 94% (95% CI 76–99). 31 Molecular techniques, such as polymerase chain reaction (PCR) diagnosis, have increased sensitivity of diagnosis when compared to microscopy of placental blood to 94% (95% CI 86–98), but specificity of 94% (95% CI 86–98). 31 A new generation of ultrasensitive RDT’s is now being developed and might mitigate these diagnostic problems. 55
Prevention and Treatment
Prevention strategies in africa.
In malaria-endemic areas in Africa, a combination of vector control (preventing exposure to mosquitos) and chemoprevention (preventive medication-based treatment) strategies are used to prevent MIP. The World Health Organization (WHO) recommends a combined approach using insecticide treated bed nets (ITNs) to reduce exposure to mosquitoes carrying malaria and chemoprevention. 56 ITNs work by providing a physical barrier from mosquitoes, and repelling or killing susceptible mosquitoes, which reduces mosquito density and maintains the nets’ effectiveness even after the integrity of the barrier is compromised. 57 The use of ITNs in Africa have been shown to reduce LBW by 23%, miscarriages and stillbirths by 33%, and placental parasitemia by 23%. 58 Despite the proven efficacy of ITNs, uptake was estimated at only 39% in Africa between 2009 and 2011. 59 Since that time, ITN use has steadily increased, and an estimated 61% of pregnant women at risk for malaria slept under an ITN in 2017 56 , ( Figure 2 ). Malarial resistance to pyrethroids, the most commonly used insecticide in ITNs has been reported across sub-Saharan Africa and might impair future efficacy. 57

Percentage of the population in Sub-Saharan Africa at risk for malaria with access to ITN and using ITNs.
ITN: insecticide-treated bed nets Sources: World Health Organization and Malaria Atlas Project. Reprinted with permission ( 56 ).
Spraying the walls of households with insecticide to reduce human exposure to mosquitos, a procedure known as indoor residual spraying (IRS) is part of a comprehensive vector control program. Globally, IRS usage has declined and only 3% of the population at risk was protected by IRS in 2017, which might be related to a switch in insecticide from pyrethroids to more expensive chemicals. 56 IRS has been shown to improve outcomes of MIP, with women protected by IRS having lower incidence of MIP and lower risk of placental malaria. 60 , 61 When women were protected during greater than 90% of the time of their pregnancies, women had lower risk of preterm birth (risk ratio 0.35, 95% CI, 0.15–0.84). 60 IRS is an important part of a comprehensive vector control program and might contribute to improved birth outcomes in malaria-endemic regions.
Chemoprevention strategies have been successfully used to prevent adverse health outcomes associated with MIP. The most efficacious of these strategies uses a technique of intermittent preventive treatment in pregnancy (IPTp). IPTp consists of providing monthly doses of anti-malarial medication to all pregnant women starting in the second trimester. Women who receive at least 2 courses of IPTp have a relative risk reduction of 40% for moderate to severe anemia, 61% for antenatal parasitemia, 55% for placental parasitemia and 27% for low birthweight. 62 Since 2012, the WHO has recommended monthly IPTp to reduce the incidence of these complications of pregnancy. 63 However, despite WHO recommendations, in 2017, only 22% of pregnant women received three or more doses of IPTp in Sub-Saharan Africa ( Figure 3 ). 64

Percentage of pregnant women receiving IPTp, by dose in Sub-Saharan Africa, 2010–2017.
ANC: antenatal care, IPTp: intermittent preventive treatment in pregnancy, listed by dose. Sources: National Malaria Programme, World Health Organization, US Centers for Disease Control and Prevention. Reprinted with permission ( 56 ).
Sulfadoxine-pyrimethamine (SP) has been the drug of choice for IPTp in women who are HIV-negative. 65 Plasmodium resistance to SP has emerged through multiple mutations in the P. falciparum dihydrofolate reductase (Pfdhfr) and dihydropteroate synthetase (Pfdhps), with penetrance of this haplotype in some areas of greater than 90%. 66 Due to increasingly more resistant organisms, IPTp with SP is less effective at inhibiting parasite growth and preventing fetal growth restriction. 66 In light of increasing resistance, alternative strategies for chemoprevention are being tested, including IPTp with alternative medications and strategies of intermittent screening and treatment in pregnancy (ISTp). ISTp strategies use RDTs to diagnosis MIP at multiple time points and treat only when RDTs are positive. However, these strategies depend on accurate diagnosis of MIP and have not been proven to be effective alternatives to IPTp-SP even in highly resistant areas. 66 IPTp with dihydroartemisinin-piperaquine (DP) might be a promising alternative to IPTp-SP, but more research is needed in this area. 66
Prevention Strategies Outside of Africa
In South America and Asia, where malaria transmission is typically lower than in Africa, data on traditional chemoprophylaxis is limited. Prophylaxis with mefloquine or chloroquine has been efficacious for preventing MIP in pregnant women in Thailand. 67 , 68 Other chemoprophylactic strategies employed outside of Africa have included monthly IPTp-SP with azithromycin and ISTp-SP and artesunate. These strategies show promise in the reduction of low birth weight or maternal parasitemia.
Treatment of uncomplicated malaria
All MIP infections should be treated promptly to avoid complications to the mother and fetus. 31 To ensure safety of treatment in pregnancy, the WHO recommends trimester-specific and species-specific treatment strategies for uncomplicated malaria ( Table 1 ). For first trimester treatment of P. falciparum , the WHO recommends a 7-day treatment course of quinine with clindamycin, and second line treatment includes artemisinin-based combination therapy (ACT) or oral artesunate with clindamycin. 65 First trimester treatment of uncomplicated non- falciparum malaria consists of chloroquine or quinine for chloroquine-resistant infections.
Second and third trimester treatment of uncomplicated malaria follows the same guidelines as treatment for malaria in non-pregnant adults. 31 Therefore, first line treatments with ACTs can be used in MIP. ACTs include a short-acting artemisinin component and a longer acting partner drug, such as SP. 69 The potent artemisinin reduces the number of parasites quickly and the longer acting partner drug acts on the remaining parasites and provides a post-treatment prophylactic effect, preventing new infections. 69 ACTs have achieved cure rates as high as 99.2% for uncomplicated MIP without demonstrating significant safety concerns. 70
Treatment of Severe Malaria
Severe malaria has historically been attributed to infections with P. falciparum , but more recent evidence has included P. vivax as a significant contributor to severe malaria. 30 For pregnant patients with severe malaria, the WHO recommends the same treatments for both P. falciparum and P. vivax infections. The WHO also recommends treatment with primaquine after delivery to achieve cure and prevent relapses by eradicating P. vivax sequestered in the liver, ( Table 1 ). 30
Artemisinins are the most efficacious drugs for severe MIP after the first trimester. Because they are embryotoxic and teratogenic in animal studies, the WHO does not recommend their use in the first trimester for uncomplicated malaria. However, their use is recommended even in the first trimester in cases of severe malaria because of the high risk of maternal mortality. 30 Data on the use of artemisinins in the first trimester in humans show no associated increased risk of adverse pregnancy outcomes. 30 Long-term neurodevelopmental studies are needed to evaluate the safety of different drug combinations on child development.
Quinine is an alternative to artemisinin that has been used for centuries for the treatment of malaria. Although it is not considered embryotoxic or teratogenic in animal studies, it is less well-tolerated in humans. 30 Quinine can prolong the cardiac QT interval and is associated with tinnitus, headache, blurred vision, altered auditory acuity, nausea, diarrhea, and, rarely, massive hemolysis. 65 These side effects reduce compliance with treatment regimens and lead to higher levels of treatment failure. 30
An efficacious vaccine against malaria could be of particular benefit for pregnant women. One vaccine, RTS,S, is now approved by the European Medicines Agency, but is only modestly effective. 71 Efforts are also underway to develop a vaccine targeting the VAR2CSA antigen to protect women against pregnancy-associated malaria. 72
Co-Infection with HIV
Co-infections with malaria and HIV worsen morbidity and mortality for each disease, possibly due to alterations in the balance between the immune response to malaria and stimulation of viral replication. 73 MIP is associated with a two-fold higher HIV viral load. Conversely, women living with HIV experience more placental and peripheral malaria, higher parasite densities, more frequent febrile illnesses, more severe anemia and worse birth outcomes compared to non-HIV infected mothers with MIP. 73 Chemoprevention for women living with HIV in malaria-endemic areas includes daily co-trimoxazole. SP is discouraged for chemoprevention due to potential adverse drug reactions between SP and co-trimoxazole. 74 Although pregnant women living with HIV have the greatest risk of severe MIP, treatment strategies for severe malaria in conjunction with HIV treatments have not been well studied. 30 , 73 The WHO recommends against the use of zidovidine or efavirenz and the use of artesunate amodiaquine due to neutropenia and hepatotoxicity respectively. 65 Pregnant women receiving highly active antiretroviral therapy regimens should receive quinine when cardiac monitoring is available.
Conclusions
Malaria is among the most common and easily preventable causes of poor birth outcomes in the world. IPTp and ITNs distribution programs have helped decrease malaria risk among pregnant women in many parts of the world. However, greater efforts are needed especially in light of increasing drug and insecticide resistance. A better understanding of the pathogenesis of malaria during pregnancy could lead to the development of new interventions to prevent its health consequences.
Gaps in Knowledge (sidebar)
- What are the mechanisms by which malaria during pregnancy affects fetal growth?
- What is the natural history of congenital malaria?
- How can we increase uptake of IPTp and ITN’s by pregnant women?
- When is the optimal gestational age to start IPTp?
- How can we enable women to begin IPTp earlier during pregnancy?
- When malaria prevalence drops, when is it appropriate to stop IPTp?
- When high levels of resistance to SP develop, what should be done to protect pregnant women from malaria?
- Will it be possible to vaccinate primigravidae against pregnancy-associated malaria?
DISCLOSURES
The authors report no proprietary or commercial interest in any product mentioned or concept discussed in this article.
Reference List

IMAGES
COMMENTS
Malaria is a severe disease caused by parasites of the genus Plasmodium, which is transmitted to humans by a bite of an infected female mosquito of the species Anopheles. Malaria remains the leading cause of mortality around the world, and early diagnosis and fast-acting treatment prevent unwanted outcomes.
This documentary video discusses the epidemiology of malaria; strategies for prevention, including vector control and vaccines; and the pipeline of promising new drugs for the fight to eliminate ma...
Methods A systematic literature review was undertaken across four medical and life sciences databases (PubMed, Cochrane Central, Embase, and Web of Science) from their inception to July 2016 to compare the effectiveness of different preventive measures on malaria incidence.
Public health strategies for malaria in endemic countries aim to prevent transmission of the disease and control the vector. This historical analysis considers the strategies for vector control developed during the first four decades of the twentieth century. In 1925, policies and technological advances were debated internationally for the first time after the outbreak of malaria in Europe ...
In order to assess the disparities between efficacy and effectiveness of malaria control interventions, and the range of PE observed on the field, we conducted a systematic review of the literature on epidemiological studies providing data about the protective effectiveness of control interventions for malaria prevention (CIMP) under field ...
The aim of this systematic review was to collate and summarize the impact of integrated malaria prevention in low- and middle-income countries on malaria burden. Literature on integrated malaria prevention, defined as the use of two or more malaria prevention methods holistically, was searched from 1st January 2001 to 31st July 2021.
This Review discusses the epidemiology, prevention, and treatment of malaria in the US.
Background Global interest in malaria elimination has prompted research on active test and treat (TaT) strategies. Methods A systematic review and meta-analysis were conducted to assess the effectiveness of TaT strategies to reduce malaria transmission. Results A total of 72 empirical research and 24 modelling studies were identified, mainly focused on proactive mass TaT (MTaT) and reactive ...
Purpose of Review Malaria is a prevalent disease in travelers to and residents of malaria-endemic regions. Health care workers in both endemic and non-endemic settings should be familiar with the latest evidence for the diagnosis, management and prevention of malaria. This article will discuss the recent malaria epidemiologic and medical literature to review the progress, challenges, and ...
Abstract Purpose of review: Malaria is a prevalent disease in travelers to and residents of malaria-endemic regions. Health care workers in both endemic and non-endemic settings should be familiar with the latest evidence for the diagnosis, management and prevention of malaria. This article will discuss the recent malaria epidemiologic and medical literature to review the progress, challenges ...
Malaria is a major public health problem in developing countries. The burden of malaria in fragile and conflict-affected states (FCAS) is increasing year by year. Moreover, the population living in FCAS is often the most vulnerable and at high risk of malaria due to factors, such as deteriorating healthcare system, mass relocations, and reduced resilience to shocks. Therefore, this scoping ...
Integrated malaria prevention advocates the use of several malaria prevention measures holistically at households and in the community. The aim of this systematic review was to collate and summarize the impact of integrated malaria prevention in low- and middle-income countries on malaria burden. Methods: Literature on integrated malaria ...
To the best of our knowledge, this is the first systematic literature review on the effectiveness and the cost-effectiveness of MSAT, and the second attempt to revisit this intervention since the WHO Malaria Policy Advisory Committee (MPAC) issued a recommendation on its use in 2015. 5 In the absence of sufficient evidence, the WHO MPAC ...
Better understanding of the complex interactions between malaria and malnutrition is crucial for optimally targeting interventions where both conditions co-exist. This systematic review aimed to assess the evidence of the interplay between malaria and malnutrition.
Malaria is known to cause around 1 million deaths per annum. This life-threatening disease is mostly prevalent in Africa. Due to the burgeoning proble…
A systematized literature review which involved a structured search of the malaria technological innovations followed by a quantitative and narrative description and synthesis of the innovations was carried out.
Prevention: Prevention of malaria involves controlling mosquito vectors through use of insecticide-treated nets, use of antimalarial drugs for prophylaxis, administration of vaccines (such as RTS, S vaccine), and use of mosquito bite prevention measures such as anti-mosquito lotions and repellents.
Malaria is caused by the four species of the protozoa of the genus Plasmodium, which is transmitted by the bite of the female Anopheline mosquito, congenitally, or through exposure to infected blood products. This article reviews the epidemiology, pathology, clinical symptoms, diagnosis, and treatment of malaria in pregnant women.
Malaria is an endemic in various tropical countries. The gold standard for disease detection is to examine the blood smears of patients by an expert medical professional to detect malaria parasite called Plasmodium. In the rural areas of underdeveloped countries, with limited infrastructure, a scarcity of healthcare professionals, an absence of sufficient computing devices, and a lack of ...
The 2021 CDC STI Treatment Guidelines included a systematic review of the available literature on STI PEP and concluded that further studies were necessary to determine whether it would be an effective strategy for bacterial STI prevention (5).
Background: Biologic graft infection (BGI) is one of the main complications in graft reconstructions. However, very little evidence exists regarding the epidemiology of BGI, as most of the data come from sparse reports. Moreover, most of the series did not detail the treatment and outcome of graft infections. The aim of this systematic review of the literature is to provide a comprehensive ...
This systematic review aims to provide a summary and overview of literature discussing factors influencing uptake of these two malaria control strategies in Southeast Asian countries.
A case of Powassan encephalitis occurred in Manitoba, Canada, after the bite of a black-legged tick. Awareness of this emerging tickborne illness is needed because the number of vector tick species is growing. No specific treatment options exist, and cases with illness and death are high. Prevention is crucial.
These discrepancies in implementation of good practices towards malaria prevention and control might be due to differences in sociodemographic characteristics (gender, age, educational, and income levels), the community's awareness about malaria, and their attitudes towards malaria prevention and control.
Malaria; Melanoma; Multiple sclerosis ... "We hope our work can contribute to safer and more effective treatment of rheumatic diseases ... Systematic literature review provides evidence base for ...
Pregnant women in all trimesters with parasitologically confirmed uncomplicated falciparum malaria were included irrespective of symptoms. This review attempted to re-calculate proportions of treatment success applying the same definition as the standard WHO methodology for non-pregnant populations.
s. rept. 118-207 - departments of labor, health and human services, and education, and related agencies appropriation bill, 2025 118th congress (2023-2024)
The most widely used measures of declining burden of malaria across sub-Saharan Africa are predictions from geospatial models. These models apply spatiotemporal autocorrelations and covariates to parasite prevalence data and then use a function of parasite ...
A Multidisciplinary Update on Treatment Modalities for Metastatic Spinal Tumors with a Surgical Emphasis: A Literature Review and Evaluation of the Role of Artificial Intelligence. Cancers 2024 , 16 , 2800.
Malaria in pregnancy is associated with anemia, stillbirth, low birth weight and maternal and fetal death. We review the challenges to diagnosing malaria in pregnancy, as well as strategies to prevent and treat malaria in pregnancy. Finally, we discuss the current gaps in knowledge and potential areas for continued research. Go to: